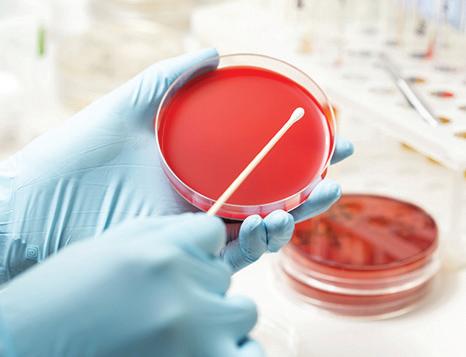

GUIDE TO TOP CARE











































































Here, world-class research leads to the most advanced treatments available anywhere. It starts with more than 1,000 clinical trials conducted each year, leading to patient tumors and teams that only treat your type of cancer, you can be sure you’re receiving the most innovative treatments, personalized just for you. It’s leading-edge care delivered with compassion that has led us to being named a U.S. News & World Report top 10 cancer center for the 22nd year in a row.


12 In Short Supply
A growing shortage of health care workers is being called America’s top patient safety concern.

18 On the Verge of Collapse
Emergency room overcrowding is a symptom of a much bigger problem nationwide.
20 Photo Essay: Looking Back COVID-19 has pushed the country to the brink. Key moments from the trenches of these difficult times.
28 Virtual Reality for Chronic Pain Patients are finding a new path to relief, and the science is showing encouraging results.
50 The Future of mNRA Vaccines
These shots hold promise for everything from flu to cancer.
52 Telemedicine’s PostPandemic Role
Since 2020, virtual care has exploded in popularity. But is it here to stay?
83 Best Hospitals for Maternity Care
What makes a hospital great for childbirth? Our inaugural ratings identify 237 centers that excel.

If you’re noticing these red flags, it could be time to move on.
56
Erasing Race in Medicine
Renewed efforts are underway to eliminate race from some aspects of patient care.
CHAPTER TWO
80 Welcoming Baby Safely
Consider these factors before choosing a maternity hospital.

At least six factors are entirely within your control.
99 Eating the Mediterranean Way
One expert’s view of the pleasures of following a U.S. News top diet.

103 The Merits of Strength Training
Hint: It’s about so much more than building muscle size.
Peter Killinger went to his local hospital and found out he'd had a heart attack and his heart was in failure. They rushed him to NewYork-Presbyterian, where our team put him on life support and performed a heart transplant within a month. nyp.org/heart





ranked #2 in the nation.
We’re honored and humbled to be ranked #2 among the best children’s hospitals in the nation by U.S. News & World Report. This recognition starts and ends with having the best team possible offering the best care imaginable.

We’re also proud to announce all ten of our specialties are
Heart
No.
Cancer
GI Surgery
Endocrinology
texaschildrens.org/best
A look at some of the most popular and most researched diets, with reviews by a panel of health experts. Discover the top diets for weight loss, diabetes manage ment and heart health, as well as the best plant-based and commercial diets. usnews.com/bestdiets
Eating healthfully and staying in shape can be tough to manage. We regularly serve up expert advice to support you. usnews.com/eat-run
State-by-state ratings of insurers offer ing Medicare Advantage and Medicare Part D plans, plus tips on choosing one of these plans vs. original Medicare. usnews.com/medicare
An interactive platform featuring news, analysis and county-level rankings that examine how social factors shape America’s health and well-being. usnews.com/ healthiestcommunities
See the best of the Best Hospitals –20 centers that lead the pack in a host of specialties, procedures and conditions, ex celling in both breadth and depth of care. usnews.com/hospitalphototour

We’ve evaluated more than 4,500 hospitals on up to 20 common procedures and conditions, including hip replacement, knee replacement, heart bypass surgery, colon cancer surgery, diabetes and stroke, as well as 15 medical specialties from cancer care to orthopedics to cardiology and heart surgery. usnews.com/best-hospitals
We’ve analyzed government data and published ratings of nearly 15,000 facilities nationwide. usnews.com/nursinghomes
Which over-the-counter products do pharmacists prefer? Check out Top Recommended Health Products to make your next trip to the drugstore easier. usnews.com/tophealthproducts
A searchable directory of more than 900,000 doctors. Patients can find and research doctors who have the training, certification, practical experience and hospital affiliation they want – and can see ratings based on other patients’ experience. With free registration, physicians can update the profile patients see. usnews.com/doctors

When treating cancer, precision is crucial. That’s why Robert Wood Johnson University Hospital, in partnership with Rutgers Cancer Institute of New Jersey, is proud to o er proton therapy for adults and children. This pinpoint-accurate, non-invasive treatment targets the exact location of the cancer, with fewer e ects on surrounding areas. It’s just one of many innovations you can expect to find at New Jersey’s only NCI-designated Comprehensive Cancer Center. Visit rwjbh.org/beatcancer or call 844-CANCERNJ to learn more.
Let’s beat cancer together.

but he also has advanced technology to fight it: Proton Therapy.
Stanford Hospital is ranked among the top ten hospitals in the nation by U.S . News & World Repor t .






Thank you to the team at Stanford Health Care for your s teadfas t dedication to healing humanit y through science and compas sion, one patient at a time.




When you care as much as we do, people not ice.



Providence Alaska Medical Center Anchorage, AK
CHI St. Vincent Hospital Hot Springs Hot Springs, AR
Mercy Health System of Northwestern Arkansas Rogers, AR
NEA Baptist Memorial Hospital Jonesboro, AR
CHI St.Vincent Infirmary Little Rock, AR
Adventist Health Bakersfield Bakersfield, CA
Dignity Health St. Joseph’s Medical Center Stockton, CA
El Camino Health Mountain View, CA
Memorial Medical Center Modesto Modesto, CA
Palomar Medical Center Escondido, CA
Pomona Valley Hospital Medical Center Pomon, CA
Salinas Valley Memorial Healthcare System Salinas, CA
Temecula Valley Hospital Temecula, CA
California Pacific Medical Center San Francisco, CA
Littleton Adventist Hospital Littleton, CO Medical Center of Aurora Aurora, CO
Medical Center of the Rockies Loveland, CO
Mercy Regional Medical Center Durango, CO
National Jewish/SCL Saint Joseph Hospital Denver, CO
North Colorado Medical Center Greeley, CO
Parker Adventist Hospital Parker, CO
Parkview Medical Center Pueblo, CO
Poudre Valley Hospital Fort Collins, CO
Saint Mary’s Hospital and Regional Medical Center Grand Junction, CO
SCL Health Good Samaritan Medical Center Lafayette, CO
Hospitals receiving this award have demonstrated the highest standards of care for heart attack patients and are recognized by the Chest Pain – MI Registry for their sustained achievement and commitment to excellence with the Platinum Performance Achievement Award. View all award recipients in the “Heart of Quality Patient Care” insert in this issue of U.S. News & World Report. Look for the hospitals that have the triangle; Platinum, Gold, and Silver.

Scan this QR code to find the full listing of Performance Achievement Award recipients.
Sky Ridge Medical Center
Lone Tree, CO
St. Anthony Hospital Lakewood, CO
Swedish Medical Center Englewood, CO
Lutheran Medical Center Wheat Ridge, CO
McKee Medical Center Loveland, CO
Platte Valley Medical Center Brighton, CO
Christiana Care Health System Newark, DE
The George Washington University Hospital Washington, DC
Bayfront Health Saint Petersburg St. Petersburg, FL
UF Health Jacksonville Jacksonville, FL
Piedmont Fayette Hospital Fayetteville, GA
Piedmont Henry Hospital Stockbridge, GA
Piedmont Newnan Hospital Newnan, GA
St. Joseph’s Hospital Savannah,GA
St. Mary’s Health Care Systems Athens, GA
Carle BroMenn Medical Center Normal, IL
Memorial Hospital Carbondale Carbondale, IL
Northwestern Lake Forest Hospital Lake Forest, IL
Northwestern Medicine Huntley Hospital Huntley, IL
Northwestern Medicine McHenry Hospital McHenry, IL
Riverside Health Care Kankakee, IL
Rush - Copley Hospital Aurora, IL
Loyola University Medical Center Maywood, IL
Memorial Hospital Shiloh Shiloh, IL
OSF HealthCare Saint Francis Medical Center Peoria, IL
OSF Saint Joseph Medical Center Bloomington, IL
Protestant Memorial Medical Center Belleville, IL
Columbus Regional Hospital Columbus, IN
Deaconess Gateway Heart Hospital Newburgh, IN
Deaconess Hospital Evansville, IN
Indiana University Health Arnett Hospital Lafayette, IN
Indiana University Health Bloomington, IN
Indiana University Health Methodist Hospital Indianapolis, IN
Indiana University Health North Hospital Carmel, IN
Indiana University Health Saxony Hospital Fishers, IN
Indiana University Health West Hospital Avon, IN
Goshen Hospital Goshen, IN
Indiana University Health Ball Memorial Hospital Muncie, IN
Allen Memorial Hospital Waterloo, IA
St. Luke’s Hospital Cedar Rapids, IA
Trinity Regional Medical Center Ft. Dodge, IA
UnityPoint Health - St. Luke’s Sioux City Sioux City, IA
Mercy Iowa City Iowa City, IA
MercyOne Siouxland Medical Center Sioux City, IA
Trinity Medical Center - Bettendorf Bettendorf, IA
Advent Health Shawnee Mission Shawnee Mission, KS
Hays Medical Center Hays, KS
Olathe Medical Center Olathe, KS
Stormont Vail Health Topeka, KS
University of Kansas Health System
St. Francis Campus Topeka, KS
Providence Medical Center Kansas City, KS
Baptist Health Corbin Corbin, KY
Baptist Health Lexington Lexington, KY
Baptist Health Louisville Louisville, KY
Pikeville Medical Center Pikeville, KY
Saint Elizabeth Healthcare Edgewood Edgewood, KY
Christus St. Patrick Hospital Lake Charles, LA
St. Tammany Health System Covington, LA
Luminis Health Anne Arundel Medical Center Annapolis, MD
UPMC Western Maryland Cumberland, MD
Spectrum Health
Grand Rapids, MI
MidMichigan Medical Center Midland, MI
CentraCare Heart & Vascular Center Saint Cloud, MN
Essentia Health - St. Mary’s Medical Center Duluth, MN
Anderson Regional Medical Center Meridian, MS
Baptist Memorial Hospital - Desoto Southaven, MS
Baptist Memorial HospitalGolden Triangle Columbus, MS
Baptist Memorial HospitalNorth Mississippi Oxford, MS
Forrest General Hospital Hattiesburg, MS
Magnolia Regional Health Center Corinth, MS
Merit Health Wesley Medical Center
Hattiesburg, MS
Mississippi Baptist Medical Center Jackson, MS
North Mississippi Medical Center
Tupelo, MS
Barnes Jewish HospitalWashington University Saint Louis, MO
Christian Hospital BJC Healthcare St. Louis, MO
Cox Medical Center Branson
Branson, MO
Freeman Health System
Joplin, MO
Heartland Regional Medical Center
St. Joseph, MO
Liberty Hospital
Liberty, MO
Mercy Hospital Joplin Joplin, MO
Mercy Hospital Springfield Springfield, MO
Mercy Hospital St. Louis St. Louis, MO
North Kansas City Hospital North Kansas City, MO
Research Medical Center
Kansas City, MO
Southeast Missouri Hospital
Cape Girardeau, MO
St. Mary’s Medical Center Blue Springs, MO
Centerpoint Medical Center Independence, MO
Saint Francis Medical Center Cape Girardeau, MO
Logan Health Kalispell, MT
St. James Health Care Butte, MT
St. Vincent Healthcare Billings, MT
Billings Clinic Billings, MT
Nebraska Medicine Omaha, NE
Renown Regional Medical Center Reno, NV
Bayshore Community Hospital Holmdel, NJ
Jersey Shore University Medical Center Neptune, NJ
Riverview Medical Center Red Bank, NJ
JFK Medical Center Edison, NJ
Ocean Medical Center Brick, NJ
Presbyterian Healthcare Services Albuquerque, NM
Bronx Care Health System Bronx, NY
Jamaica Hospital Medical Center Jamaica, NY
The Mount Sinai Medical Center New York, NY
UR Medicine Strong Memorial Hospital Rochester, NY
Alamance Regional Medical Center Burlington, NC
Atrium Health Cabarrus Concord, NC
Atrium Health Pineville Charlotte, NC
Atrium Health Carolinas Medical Center Charlotte, NC
CarolinaEast Medical Center New Bern, NC
Duke Raleigh Hospital Raleigh, NC
Duke University Hospital Durham, NC
Frye Regional Medical Center Hickory, NC
Moses H. Cone Memorial Hospital Greensboro, NC
Nash UNC Healthcare Rocky Mount, NC
New Hanover Regional Medical Center Wilmington, NC
Rex Hospital Raleigh, NC
UNC Medical Center
Chapel Hill, NC
WakeMed Cary Hospital Cary, NC
WakeMed Health and Hospitals Raleigh, NC
Wayne UNC Healthcare Goldsboro, NC
Altru Health System
Grand Forks, ND
Essentia Health - Fargo Fargo, ND
Sanford Medical Center Bismarck Bismarck, ND
Sanford Medical Center Fargo Fargo, ND
Aultman Hospital Canton, OH
Firelands Regional Medical Center Sandusky, OH
ProMedica Toledo Hospital Toledo, OH
Southwest General Health Center
Middleburg Heights, OH
The MetroHealth System Cleveland, OH
University Hospitals St. John Medical Center Westlake, OH
Asante Medford, OR
UPMC Hanover Hanover, PA
Butler Memorial Hospital Butler, PA
Doylestown Hospital Doylestown, PA
Penn State Health St. Joseph Reading, PA
Sharon Regional Medical Center Sharon, PA
UPMC Harrisburg Harrisburg, PA
UPMC Memorial York, PA
UPMC West Shore Mechanicsburg, PA
West Penn Hospital Pittsburgh, PA
Spartanburg Regional Healthcare System Spartanburg, SC
AnMed Health Anderson, SC
Bon Secours St. Francis Health System Greenville, SC
Lexington Medical Center West Columbia, SC
McLeod Regional Medical Center Florence, SC
Self Regional Healthcare Greenwood, SC
Avera Heart Hospital of South Dakota Sioux Falls, SD
Avera St. Luke’s Aberdeen, SD
Monument Health Rapid City, SD
Sanford USD Medical Center
Sioux Falls, SD
Tennova -Turkey Creek Medical Center
Knoxville, TN
Baptist Memorial Hospital - Memphis Memphis, TN
Blount Memorial Hospital Maryville, TN
Bristol Regional Medical Center Bristol, TN
Chattanooga - Hamilton County Hospital Authority Chattanooga, TN
Holston Valley Medical Center Kingsport, TN
Jackson Madison County General Hospital Jackson, TN
Methodist Hospital University Memphis, TN
Baylor Scott & White Health Temple, TX
Shannon Medical Center San Angelo, TX
Tarrant County Hosp DistrictJPS Health Network Fort Worth, TX
Texas Health Heart and Vascular Hospital Arlington, TX
Texas Health Presbyterian Hospital Plano Plano, TX
University of Texas Southwestern Medical Center Dallas, TX
Advent Health Central Texas Killeen, TX
Baylor Scott & White - Grapevine Grapevine TX
Baylor Scott & White Heart and Vascular - Dallas Dallas, TX
Baylor Scott & White Medical CenterCollege Station College Station, TX
Baylor Scott & White Medical CenterRound Rock Round Rock, TX
Baylor Scott and White All Saints Medical Center Fort Worth, TX
CHI/Baylor St. Luke’s Medical Center Houston, TX
CHRISTUS Mother Frances Hospital Tyler, TX
Dallas Regional Medical Center Mesquite, TX
Harris Health System Houston, TX
Memorial Hermann Memorial City Hospital Houston, TX
Memorial Hermann Sugar Land Sugar Land, TX
North Central Baptist Hospital San Antonio, TX
Texas Health Harris Methodist Fort Worth Fort Worth, TX
Texas Health Harris Methodist HEB Bedford, TX
Texas Health Harris Methodist Hospital Southwest Fort Worth, TX
The Hospitals of Providence Sierra Campus El Paso, TX
University Health San Antonio, TX
St. Marks Hospital/Northern Utah Healthcare Corp.
Salt Lake City, UT
University of Utah Health Salt Lake City, UT
Inova Alexandria Hospital Alexandria, VA
Inova Loudoun Hospital
Leesburg, VA
Sentara Martha Jefferson Hospital Charlottesville, VA
Augusta Health Fishersville, VA
Carilion Roanoke Memorial Hospital Roanoke, VA
Chesapeake Regional Medical Center Chesapeake, VA
Inova Fairfax Medical Campus IHVI Falls Church, VA
Reston Hospital Center
Reston, VA
Sentara Careplex Hospital Hampton, VA
Sentara Leigh Hospital Norfolk, VA
Sentara Norfolk General Hospital Norfolk, VA
Sentara Northern Virginia Medical Center Woodbridge, VA
Sentara Rockingham Memorial Hospital
Harrisonburg, VA
Sentara Virginia Beach General Hospital Virginia Beach, VA
MultiCare Good Samaritan Hospital Puyallup, WA
MultiCare Auburn Medical Center Auburn, WA
MultiCare Tacoma General Hospital Tacoma, WA
Virginia Mason Medical Center Seattle, WA
St. Mary’s Medical Center Huntington, WV
Wheeling Hospital Wheeling, WV
Marshfield Medical Center - Weston Weston, WI
Aurora BayCare Medical Center Green Bay, WI
Aurora Grafton Grafton, WI
Aurora Medical Center Summit Summit, WI
Aurora St. Luke’s Medical Center Milwaukee, WI
Marshfield Medical Center Marshfield, WI
UW Health Madison, WI
Wyoming Medical Center Casper, WY
Campbell County Health Gillette, WY
Hospital Israelita Albert Einstein Sao Paulo, Brazil
Tabba Heart Institute Karachi/Gulberg, Pakistan
A growing shortage of health care workers is being called the nation’s top patient safety concern
by Steven Ross Johnson ©
S THE PANDEMIC STRETCHES on with no clear end in sight, one of the biggest unan swered questions is what this experience has meant, and ultimately will mean, for those who’ve been on the front lines throughout –the nation’s health care workforce – and the patients they serve.
An estimated 1.5 million health care jobs were lost in the first two months of COVID-19 as the country raced to curb the novel coronavirus by temporarily closing clinics and restricting nonemergency services at U.S. hospitals. Though many of those jobs have since returned, health care employment remains below pre-pandemic levels, with the number of workers down by 1.1%, or 176,000, compared to February 2020, per the U.S. Bureau of Labor Statistics.
Yet the need for health care workers has never been greater. Staffing shortages are now the nation’s top patient safety concern, forcing Americans to endure longer wait times when seeking care “even in life-threatening emergencies,” or to be turned away en tirely, according to ECRI, a nonprofit patient safety organization.
In a letter sent in March 2022 to the House Energy and Com merce Committee, the American Hospital Association called the workforce shortage hospitals were experiencing a “national emergency,” projecting the overall shortage of nurses to reach 1.1 million by the end of the year. And it’s not just nurses: Profession als from medical lab workers to paramedics are in short supply.

The effects are being felt throughout the entire care continuum. In certain parts of the country, whole hospitals and medical departments have shuttered amid such shortfalls, leaving patients with less ac cess to vital health care, including labor and delivery services and inpatient care for children.
With fewer clinicians working in the field, practitioners are finding them selves responsible for a larger number of patients, fueling soaring burnout levels that experts say raise the risk of medical errors and, consequently, potential harm to Americans. The number of central line-associated bloodstream infections in creased 28% in the second quarter of 2020 compared to the same period in 2019, ac cording to the New England Journal of Medicine, while rates of falls rose by 17% and pressure injuries increased by nearly 42% at skilled nursing facilities during the same period.
The strain hasn’t let up. A February 2022 survey conducted by USA Today and Ipsos of more than 1,100 health care work ers found nearly a quarter of respondents said they were likely to leave the field in the near future due to the pandemic.

Low morale has already translated into departures. Results of a September 2021 poll of 1,000 health care workers revealed that, since February 2020, 18% had quit their jobs.
Patients are feeling the sting in several ways. In January 2022, Saint Alphonsus Health System – a primary care provider for a region with a population of more than 1 million in Idaho and parts of Or egon – decided to temporarily close weekend opera tions at three of its urgent care centers and cut back hours at all 11 of its urgent care clinics for a couple of weeks when several staff members contracted COVID19 and had to isolate. Though the situation has since normalized there, sudden, temporary staff losses have become par for the course during a pandemic that has sickened workers across all corners of the U.S. health care landscape.
Other staff cutbacks have been more permanent. In April 2022, Memorial Hospital of Carbon County, in Rawlins, Wyoming, announced it was ending its labor and delivery services due to staffing challenges. Now, the closest facility for expectant parents is about an hour and a half away at Ivinson Memorial Hospital, in Laramie, Wyoming.
“The cost of traveling nurses has played a significant role” in the decision, said Rod Waeckerlin, chair of the
MHCC Board of Trustees, in a press release. “Labor and Delivery is a unique service line that requires intensive staffing. Unfortunately, as a result of the pandemic, MHCC has lost a number of nursing staff, forcing a re liance on traveling nurses and creating a financial imbal ance operationally.”
The escalating demand for health care professionals has also led to a sharp rise in labor costs, as hospitals vying for workers must dangle larger pay packages. Hospital labor costs rose 37% between 2019 and March 2022, according to a recent report from consulting firm Kaufman Hall.
For hospital systems like Northwell Health in New York, the fluctuating labor market has presented both imme diate and longer-term workforce challenges that have evolved as the nature of the pandemic has changed.
By the start of 2021, Northwell’s staffing focus shifted. It went from managing the influx of severely ill COVID19 patients flooding its emergency departments and in patient beds to adding personnel at its outpatient set tings to treat more moderate cases.
With COVID cases ticking up once again at press time, Matthew Kurth, deputy chief people officer for Northwell Health, says the health system has pivoted to ensuring testing centers and processing laboratories are staffed up enough to meet the demand.
But just as workers have adapted, many patients are changing how they access their health care due to the pandemic, which has created both opportunities and pitfalls.
For example, many patients have become accustomed to using digital tools like telehealth to tend to their pri mary care needs, a practice Kurth says will likely con tinue beyond the pandemic. But while fewer people are
being hospitalized for severe COVID-19, more patients are showing up with se vere ailments, creating a backlog of cases at myriad facilities nationwide. Many of these cases stem from delayed care –people having postponed treatment either due to contagion fears or care restrictions enacted at the height of the pandemic.
“I think that first wave definitely had an impact across the entire spectrum,” says Dr. John D’Angelo, chief of integrated op erations for Northwell Health.
Although hospital staffing issues have evolved with each new COVID wave, one concern has remained constant: the mental and physical burden that has been placed on health care workers.

At Henry Ford Health in Michigan, pandemic-related burnout and stress has led some professionals to leave in pursuit of more lucrative jobs contracting with staff ing agencies while others have opted to exit the field altogether, says Jan HarringtonDavis, the organization’s vice president of talent acquisition and workforce diversity. She estimates the health system has ap proximately 3,000 open positions.
“I don’t think there’s any area that you could name that hasn’t seen a huge amount of turnover,” Harrington-Davis says.
Michelle Gaskill-Hames, chief operat ing officer for Kaiser Permanente’s South ern California and Hawaii markets, says though the situation has improved since the early months of COVID-19 in terms of cases and deaths, there remains a vital need for hospitals to address the anguish workers have experienced since Day One.
“As our surges are becoming smaller, more people are vaccinated and hospitalizations are down, many people are looking to put the pandemic behind them, but in the health care space, it’s not that easy,” Gaskill-Hames says. “There are just layers of anxiety, stress and fear. That doesn’t just go away.”
To help workers recover from pandemic-induced trau ma, the health system launched Rise & Renew, an initia tive that provides employees with counseling support.
At Mount Sinai Health System in New York, staff have been offered 14 one-on-one behavioral health counseling sessions and group workshops at no charge since June 2020, when the organization launched its Center for Stress, Resilience, and Personal Growth.
According to Jane Maksoud, the health system’s chief human resources officer, this program, coupled with ef forts to allow as many as 10,000 team members to work
remotely, is part of a broader retention strategy that hinges on meeting workers where they are to engage them with sup port, and allowing flexibility to whatever extent possible.
However, even as the country enters a less acute phase of the pandemic, some experts are skeptical that enough is being done nationwide to combat the enduring trauma of having worked on the front lines throughout COVID-19.
“My concern is that even though it’s getting talked about a lot, I don’t know if the support is reaching the clinical staff,” says Dr. Rajnish Jaiswal, associate chief of emergency medicine at NYC Health + Hospitals-Metropolitan in Manhattan. “Wellness programs that keep that in mind and allow folks to actually utilize them – I think that’s going to be the next big step.”
Jaiswal says getting back to a state of “normal” for many hospitals will mean facing the same staffing problems that were present before COVID-19.
A coordinated response Creative staffing solutions have also emerged from the pandemic. In the thick of initial COVID-19 surges, some hospitals addressed workforce gaps through rapid redeployment of existing staff to help in areas of high need. Medi cal specialists whose services were put on hold to stem the spread of the virus began pitching in to assist colleagues in caring for COVID-19 patients. Groups of nurses and physicians led by intensive care unit clinicians were established to manage sicker patients.
“In some instances, we had physicians working for nurses because a lot of the burden was on the nursing teams to re ally deliver that consistent bedside care,” Maksoud says.
Similar tactics are being adopted at Saint Alphonsus, for example. To ad dress its nursing shortage and ideally reduce wait times, the medical center is launching a pilot program that creates nursing care teams made up of registered nurses, licensed practical nurses and certified nursing assistants. With fewer nurses available to care for patients in that region, the goal of the program is to have fewer RNs be in charge of a larger pool of patients than they would tradi
tionally without lowering care quality or safety standards.
“It’s kind of a way to spread that care team a little broader,” says David Mc Fadyen, president of Saint Alphonsus Regional Medical Center.
At Virginia Mason Franciscan Health in Washington State, virtual care is proving helpful. Chief Nursing Officer Dianne Aroh says a centralized mission control center and virtual hospital that went into effect in 2019 provides realtime, systemwide surveillance that has helped deploy personnel more rapidly to departments experiencing capacity issues, while easing patient-flow bottle necks and wait times.
“That’s a system I think that we will need to leverage in the future,” she says.
Whether due to labor costs, ill ness or burnout, the long-term ramifications of current health care workforce shortages are likely to be felt well after the pandemic ends.
Nationally, staffing shortages threaten to exacerbate what projections for years have char acterized as a looming crisis. By 2025, the U.S. is estimated to have a shortage of around 446,000 home health aides, 95,000 nursing assistants, 98,700 medical and lab technologists and technicians, and more than 29,000 nurse practitioners, according to a 2021 report from Mercer, an industry market analytic firm.
Meanwhile, the need for health care is only going to rise as the elderly pop ulation grows. The 65-and-older set is projected to jump from 54 million in 2019 to more than 80 million by 2040, according to the Department of Health and Human Services. The prevalence of chronic illnesses among younger people and children has also grown over time, with more than 40% of school-age chil dren and adolescents having at least one chronic health condition.
While technology and workforce in novations may provide short-term relief, a diminished workforce signals a future where patients will likely have to become more active participants in their health care to achieve good outcomes. l
OFTEN FEEL like the proverbi al canary in the coal mine, acutely aware of how broken medicine is in this country and wondering if anyone else has noticed.
I’ve been an emergency physi cian for the last 19 years, but increasingly, my job has felt different from what I trained to do. Emer gency physicians are self-described adrenaline junkies. Our world revolves around trauma, stroke, sepsis and heart attacks. Little by little, however, our world has changed.

Even before the pandemic, it felt like the emer gency department was shouldering the lion’s share of primary care: We’d treat hypertension, refill pre scriptions when calls to the doctor’s office went un answered and manage chronically elevated blood sugar. Behavioral health patients with nowhere else to go would arrive one after the other by ambulance. Eager to help our patients, we started offering drug and alcohol treatment programs. Victims of our suc cess, we find that primary care physicians now seem likelier to send patients to the ED than to try treat ing them in their office. And it’s understandable, given the inaccessibility of outpatient radiologic and lab testing for urgent issues.
In dire straits. The U.S. medical system has long been tenuous, with signs of malfunction ev erywhere. Despite exorbitant spending, this country lags behind peer nations in critical health indicators such as life expectancy and chronic disease burden.
When the Affordable Care Act was enacted in 2010, we were hopeful. The system was about to
be overhauled and streamlined, with optimism that all patients eventually would have a primary care home with electronic records that would follow them every where and seamlessly interface with multiple systems. Except that quantum leap never came.
Now COVID-19 has laid bare medicine’s house of cards. We are on the brink of disaster.
In the ED where I work, days typically start with 120 patients – most of them “boarding,” or waiting for a bed upstairs in the hospital. Our ED only has 53 beds to begin with. This means having nowhere to see the new patients who start floating into the waiting room that, if we are lucky, has just been emptied from the day before. By the time the floodgates open at 11 a.m., we are bursting at the seams.
More recently, we’ve stationed physicians, physician as sistants and nurses in the waiting room to see patients. We even see them in the ambulance bay. Sometimes patients stay there for hours, unable to move into the ED. Because there is little hope a room will open anywhere in the ED to afford them the care they need, we start caring for them wherever we can – hallways, triage bays and waiting rooms included.
We take chances when we send patients home, hoping their oxygen level will hold, that someone else can take a look at their skin infection the following day after starting antibiotics, that they understood our instructions on how to manage their high blood sugar.
It may sound like we have a local problem in our ED only. There must be a management issue, a quick fix that an astute
hospital administrator can improvise, and we will be back to normal, caring for patients at the standard to which we are all accustomed. The truth is: This has become a national problem. Our ED is not alone. On social media, colleagues from all over the country are bemoaning the same situation.
Medicine’s house of cards has already started its crashing descent into collapse. We didn’t go into emergency medicine to care for patients this way, and they certainly didn’t come to us expecting the care we are struggling to provide. So what are the solutions?

Sounding the alarm. Institutional leaders, insurers and lawmak ers need to recognize emergency department crowding as a critical patient safety issue. Triggers that activate disaster protocols should be expanded to include indicators of crowding so resources can be directed toward minimizing boarding. Financial incentives must be aligned to encourage swift discharges with appropriate and timely follow-up. If the system is unable to accommodate adequate, timely outpatient testing for urgent complaints that are not life-threatening, then we need to find the pain points and create solutions. Capacity and turnaround times for outpatient labs and radiology must be ex amined and improved.
In addition, both public and private insurers must incentivize every
one of their patients to have a primary care physician. In turn, primary care doctors’ offices must increase capacity and access for urgent cases. Primaries and specialists should consider judiciously whether to urge their patients to seek care in the emergency department for imaging and testing that could be accomplished on an outpatient basis. Patients them selves need to consider responsible use of the ED, though it’s not simple, especially for those without easy access to medical care.
Our fundamental system must change, or the pen alty will be the collapse of not only the system but the doctors, physician assistants and nurses who have been waging this Sisyphean battle as well. Instead of waiting for someone to sound the alarm, I am doing it now. Consider yourselves warned. l
Dr. Sharon Anoush Chekijian is an assistant professor of emergency medicine in the Yale School of Medicine and a Public Voices Fellow with The OpEd Project.
THE PANDEMIC has pushed the country to the brink. But it has also revealed the enormous dedication, compassion and resilience of America’s health care workforce, as well as the fighting spirit displayed by everyday people in the face of a ceaseless threat. The following pages revisit a few moments from these difficult times.
WALKERSVILLE, MD. MAY 27, 2022 | FORMER NURSE PRACTITIONER MALLORY STANISLAWCZYK, BESET BY LONG COVID, RECEIVES AN IV DRIP AT HOME WHILE CUDDLING HER DAUGHTER. MATT ROTH – THE WASHINGTON POST / GETTY IMAGES


WASHINGTON, D.C. JUNE 21, 2022 | COVID-19 VACCINES WERE OK’D FOR KIDS AS YOUNG AS 6 MONTHS IN JUNE 2022. HERE, A NURSE GIVES THE SHOT TO 14-MONTH-0LD ADA HEDGE. BILL O’LEARY – THE WASHINGTON POST / GETTY IMAGES
WEST PALM BEACH, FLA. – MARCH 16, 2020 | MEDICAL WORKERS STAFF DRIVE-THROUGH TEST SITES, ENABLING AMERICANS TO GET SWABBED FOR THE NOVEL CORONAVIRUS. CHANDAN KHANNA – AFP / GETTY IMAGES


LOS ANGELES – APRIL 6, 2020 | SAILORS BRING A PATIENT ABOARD THE HOSPITAL SHIP USNS MERCY, WHICH WAS DEPLOYED TO SUPPORT LOCAL HOSPITALS BY TAKING CARE OF NON-COVID PATIENTS AND FREEING UP BEDS. RYAN BREEDEN – U.S. NAVY / GETTY IMAGES






TARZANA, CALIF. –SEPTEMBER 2, 2021 | A CLINICAL TEAM AT PROVIDENCE CEDARS-SINAI TARZANA MEDICAL CENTER FLIPS A 45-YEAR-OLD UNVACCINATED PATIENT ONTO HIS STOMACH IN THE INTENSIVE CARE UNIT WHILE ADMINISTERING TREATMENT. APU GOMES – AFP / GETTY IMAGES



WEARING VIRTUAL reality goggles is not just trendy among video gamers, but also has found popularity with researchers interested in exploring how the technology can help peo ple living with chronic pain. When combined with cognitive behavioral therapy, virtual re ality – or VR – has been shown to decrease pain intensity.
VR has been used for decades to help people overcome phobias and anxiety disorders. One of its first applications was developed in the mid-90s to distract burn victims from the agonizing pain of changing their wound dressings. A virtual environment called SnowWorld was developed by cognitive psychologist Hunter Hoffman to ease the pain from severe burns.
More recently, VR research has focused on both acute and chronic pain, and has been tested in people with post-traumatic stress disorder, idiopathic facial pain, cancer pain, complex regional pain syndrome and other conditions like irritable bowel syndrome.
What is virtual reality? VR has come a long way since it was first developed in the 1960s by the U.S. Air Force. Once thought of as a sci-fi gimmick with static and monotonous visuals, today’s VR features high-definition images using dy namic light to give each scene a sense of beginning and end. Many VR technologies use dramatic and immersive sound, and many systems monitor breathing so they can guide users through deep-breathing exercises. Patients wear headsets for 10 to 20 minutes once a day that transport them into 3D worlds; scenes vary from swimming with dolphins and ocean exploration to watching Cirque du Soleil and touring exotic destinations. In some cases, VR is used as a way to exercise and increase fitness.

Mainstream use of VR in entertainment and teaching has led to its increased popularity. Sleeker and low-cost versions have revolutionized VR technology and made them more ac cessible to the public. Oculus Quest 2 from Meta Platforms Inc. (formerly Facebook) is one of the more popular headsets because it’s light, well built, easy to use and more affordable than previous versions.
Several hundred hospitals across the country are assessing the use of VR, including Hospital for Special Surgery in New York and Boston Children’s Hospital. Cedars-Sinai Medical Center has been on the cutting edge of using VR to treat people with chronic pain. The VR program there, led by gastroenter ologist Dr. Brennan Spiegel, professor of medicine and public health, has treated more than 3,000 patients.
Spiegel has spearheaded several VR studies since 2015. One study followed 100 patients suffering from pain due to a variety of causes. The team at Cedars-Sinai found that




Time-sensitive health crises like heart attack or stroke need the right care at the right time for the chance at a better outcome. The science of the American Heart Association sets the standards for highquality care, and access to that care is something that all patients deserve.
Each year, the American Heart Association recognizes hospitals across the country for consistently following

up-to-date, research-based guidelines to ensure all patients have access to the best practices and lifesaving care. Read more about the recognition categories from the American Heart Association and find an awardwinning hospital near you.

This content is produced by or on behalf of our sponsor; it is not written by and does not necessarily reflect the view of U.S. News & World Report editorial staff. Learn more at mediakit.usnews.com.


Heart disease and stroke are the No. 1 and No. 5 causes of death in the United States, respectively.
Every 40 seconds, someone in America has a stroke or heart attack.
These organizations are sponsors of American Heart Association’s health care quality improvement programs.




American Heart Association gives hospitals up-to-date treatment guidelines with its Get With The Guidelines program.






More than 2,600 hospitals participate in AHA’s GWTG initiative, a 20-plus year effort to bring research-based care to heart and stroke patients.
Bed-Nubaia
These hospitals are recognized for two or more consecutive calendar years of 85% or higher adherence on all achievement measures and 75% or higher adherence to an additional set of quality measures in heart failure and/or stroke.
These hospitals are recognized for adherence for two or more consecutive calendar years of 85% or higher adherence on all achievement measures applicable to each program.
These hospitals are recognized for one calendar year of 85% or higher adherence on all achievement measures and 75% or higher adherence to an additional set of quality measures in heart failure and/or stroke.
These hospitals are recognized for one calendar year of 85% or higher adherence on all achievement measures applicable to each program.
* These hospitals received Get With The Guidelines®-Resuscitation awards from the American Heart Association for two or more patient populations. These hospitals are recognized for 10 or more consecutive calendar years of Gold Plus achievement in Get With The Guidelines®-Stroke and/or Get With The Guidelines®-Heart Failure.
STEMI: Gold Plus Receiving or Silver Plus Receiving B D
These hospitals are recognized for compliance to FMC at or before first hospital arrival to PCI ≤ 120 minutes for transferred STEMI patients for two or more consecutive, calendar years (Gold Plus) or one calendar year (Silver Plus), in addition to current Gold or Silver Mission: Lifeline status.
STEMI: Gold Receiving or Silver Receiving A C
These hospitals are recognized for two or more consecutive, calendar years (Gold) or one calendar year (Silver) of 75% compliance on each performance measure and 50% on arrival to first facility to PCI ≤ 120 minutes for patients transferred for primary PCI.
STEMI: Gold Plus Referring or Silver Plus Referring B D
These hospitals are recognized for compliance to Door In / Door Out in 30 minutes or less for transferred STEMI patients for two or more consecutive, calendar years (Gold Plus) or one calendar year (Silver Plus), in addition to current Gold or Silver Mission: Lifeline status.
STEMI: Gold Referring or Silver Referring A C
These hospitals are recognized for two or more consecutive, calendar years (Gold) or one calendar year (Silver) of 75% or higher compliance on each performance measure.
NSTEMI: Gold or Silver A C
These hospitals are recognized for achieving 65% adherence to Dual Antiplatelet prescription at discharge and 85% or higher compliance on each of the four performance measures for two or more consecutive calendar years (Gold) or one calendar year (Silver).
Target: Heart FailureTM Honor Roll G
These hospitals are recognized for 50% or higher adherence to all relevant Target measures in addition to their current Gold or Silver Get With The Guidelines®-Heart Failure status.
Target: StrokeTM Honor Roll Elite Plus F
These hospitals are recognized for treating 75% or more of their eligible stroke patients in 45 minutes or less∆ AND 50% of their eligible stroke patients in 30 minutes or less,∆ in addition to their current Gold or Silver Get With The Guidelines®-Stroke status.
Target: StrokeTM Honor Roll – Elite E
These hospitals are recognized for treating 85% or more of their eligible stroke patients in 60 minutes or less∆ in addition to their current Gold or Silver Get With The Guidelines®-Stroke status.
Target: StrokeTM Honor Roll G
These hospitals are recognized for treating 75% or more of their eligible stroke patients in 60 minutes or less,∆ in addition to their current Gold or Silver Get With The Guidelines®-Stroke status.
In addition to participating in Get With The Guidelines®-Stroke measuring, these hospitals are recognized for Door To Device (DTD) times in at least 50% of applicable patients within 90 minutes for direct arriving and within 60 minutes for transfers.
Target: Type 2 DiabetesTM Honor Roll I
A national honor roll program for hospitals participating in Get With The Guidelines® (HF, Stroke) to reinforce evidence-based guidelines with hospitals that qualify for a Silver level or higher achievement award in the related Get With The Guidelines module. These hospitals must be able to demonstrate adherence for 12 consecutive months (calendar year) for the “Overall Diabetes Cardiovascular Initiative Composite Score” measure in the selected module.
Brookwood
Coosa Valley
Medical
Regional Medical
Hospital,
North Alabama Medical
Baptist
Riverview Regional
Shelby Baptist Medical
Health Medical
Hospital,
Health
Regional
Abrazo
Campus,
Abrazo Central Campus,
West
Banner Baywood Medical Center,
Boswell Medical
Banner Del E Webb Medical
Desert Medical
Banner Estrella Medical Center,
Banner Thunderbird Medical Center,
Banner University Medical Center
Banner University Medical Center
St. Mary’s Hospital,
Dignity Health
Health
Mercy Gilbert
Flagstaff Medical Center,
HonorHealth Deer Valley Medical
HonorHealth John
HonorHealth Scottsdale
HonorHealth Scottsdale
HonorHealth Scottsdale
Medical
Medical
Tucson Medical Center,
Medical
Health Medical Center
Health Medical
Vincent
Mary’s
Adventist Health - Glendale, Glendale
Adventist Health and Rideout, Marysville..........................................................
Adventist Health Bakersfield, Bakersfield
Adventist Health Hanford, Hanford
Adventist Health Lodi Memorial,
Adventist Health Simi Valley, Simi Valley
Adventist Health White Memorial,
Seton Medical Center,
Alameda Hospital, Alameda
Alta Bates Summit Medical Center
Summit Campus, Oakland
Alvarado Hospital Medical Center, San Diego
Antelope Valley Hospital, Lancaster
Arrowhead
Medical
Heart Hospital,
Hospital,
Hospital Medical Center,
Medical
Cedars-Sinai
Medical Center,
Centinela Hospital Medical Center,
Community Regional Medical Center,
Corona Regional Medical Center,
Dameron Hospital, Stockton
Desert Regional Medical Center,
Desert Valley Hospital, Victorville
Dignity Health Arroyo Grande
Dignity Health Bakersfield Memorial Hospital,
Dignity Health Dominican Hospital,
Dignity Health Marian Regional Medical Center,
Dignity Health Mercy Hospital of Folsom,
Dignity Health Mercy Hospitals of Bakersfield,
Dignity Health Mercy Medical Center Merced,
Dignity Health Mercy Medical Center Redding,
Dignity Health Northridge Hospital Medical Center,
Dignity Health Saint Francis Memorial Hospital,
Dignity Health Sequoia Hospital, Redwood
Dignity Health Sierra Nevada Memorial Hospital,
Dignity Health St. Bernardine Medical Center,
Dignity Health St. John’s Pleasant Valley Hospital,
Dignity Health St. John’s Regional Medical Center,
Dignity Health St. Joseph’s Medical Center,
Dignity Health St. Mary’s Medical Center,
Dignity Health Woodland Memorial Hospital,
Doctors Medical Center, Modesto
Eden Medical Center, Castro
Eisenhower Health, Rancho Mirage
El Camino Health, Mountain
Emanate Health-Queen of
Encino Hospital Medical Center,
Enloe Medical Center,
Fairchild Medical Center,
Fountain Valley Regional Hospital
Garden Grove Hospital Medical Center,
Garfield Medical Center, Monterey
Good Samaritan Hospital, San
Hazel Hawkins Memorial Hospital, Hollister
Hemet Global Medical Center, Hemet
Henry Mayo Newhall Hospital,
Hoag Hospital Irvine, Irvine
Hoag Memorial Hospital
Huntington Beach Hospital,
Huntington Hospital, Pasadena
JFK Memorial Hospital, Indio
John Muir Medical Center
John Muir Medical Center
Kaiser Foundation Hospital - Antioch,
Kaiser Foundation Hospital
Kaiser Foundation Hospital
Kaiser Foundation Hospital
Kaiser Foundation Hospital
Kaiser Foundation Hospital
Kaiser Foundation Hospital
Kaiser Foundation Hospital
Kaiser Foundation Hospital
Kaiser Foundation Hospital
Kaiser Foundation Hospital
Kaiser Foundation Hospital
Kaiser Foundation Hospital
Kaiser Foundation Hospital
Kaiser Foundation Hospital
Kaiser Foundation Hospital
Kaiser Foundation Hospital - South Sacramento, Sacramento
Kaiser Foundation Hospital - South San Francisco
San Francisco
Kaiser Foundation Hospital
Kaiser Foundation Hospital
Kaiser Foundation Hospital
Vacaville, Vacaville
Vallejo, Vallejo
Walnut Creek, Walnut
Kaiser Permanente Baldwin Park Medical Center, Baldwin Park
Kaiser Permanente Downey Medical Center, Downey
Kaiser Permanente Fontana Medical Center, Fontana
Kaiser Permanente Los Angeles Medical Center, Los Angeles
Kaiser Permanente Moreno Valley Medical Center, Moreno Valley
Kaiser Permanente Ontario Medical Center, Ontario
Kaiser Permanente Orange County, Anaheim
Kaiser Permanente Panorama City Medical Center, Panorama City
Kaiser Permanente Riverside Medical Center, Riverside
Kaiser Permanente San Diego Medical Center, San Diego
Kaiser Permanente South Bay, Harbor City
Kaiser Permanente West Los Angeles, Los Angeles
Kaiser Permanente Woodland Hills, Woodland Hills
Kaiser Permanente Zion Medical Center, San Diego
Kaweah Delta Health Care District, Visalia
Keck Hospital of USC, Los Angeles
Kern County Hospital Authority, Bakersfield
La Palma Intercommunity Hospital, La Palma
Lakewood Regional Medical Center, Lakewood...............................................
Loma Linda University Children’s Hospital, Loma
Loma Linda University Medical Center, Loma
Long Beach Medical Center, Long Beach
Los Alamitos Medical Center, Los Alamitos
Los Robles Regional Medical Center, Thousand Oaks
MarinHealth Medical Center,
Marshall Medical Center, Placerville
Memorial Hospital Los Banos, Los Banos
Memorial Medical Center, Modesto, Modesto
Mercy General Hospital, Sacramento
Mercy San Juan Medical Center, Carmichael
Methodist Hospital of Sacramento,
Methodist Hospital of Southern California, Arcadia
Mills-Peninsula Medical Center, Burlingame.................................................
Mission Hospital Regional Medical Center, Mission Viejo........................
Montclair Hospital Medical Center, Montclair
NorthBay Healthcare Group, Fairfield
Novato Community Hospital, Novato
O’Connor Hospital, San Jose
Orange County Global Medical Center, Santa Ana.....................................
Oroville Hospital, Oroville
Paradise Valley Hospital, National City
PIH Health Downey Hospital, Downey
PIH Health Good Samaritan Hospital, Los Angeles
Pomona Valley Hospital Medical Center, Pomona
Providence Cedars Sinai Tarzana Medical Center, Tarzana
Providence Holy Cross Medical Center, Mission Hills
Regional Medical Center
Riverside Community Hospital,
Riverside University Health System
Medical
Agnes Medical Center,
Salinas Valley Memorial Healthcare
San Antonio Regional Hospital,
Dimas
Hospital,
San Joaquin General Hospital,
San Ramon Regional Medical
Santa Barbara Cottage Hospital,
Santa Clara Valley Medical Center,
Santa Monica - UCLA Medical Center
Scripps Green Hospital,
Scripps Memorial Hospital
Scripps Memorial Hospital
Scripps Mercy Hospital
Scripps Mercy Hospital
Sharp Chula Vista Medical Center,
Sharp Grossmont Hospital,
Sharp Memorial Hospital,
Shasta Regional Medical Center,
Sherman Oaks Hospital,
Sierra View Medical Center,
Sierra Vista Regional Medical Center,
Sonoma Valley Hospital,
Southwest Healthcare System - Inland
Rancho Springs Medical Center,
St. Elizabeth’s Community Hospital,
St. Francis Medical Center, Lynwood
St. Joseph Hospital, Orange
St. Jude Medical Center,
St. Louise Regional Hospital,
St. Rose Hospital - Hayward,
Stanford Childrens Health, Menlo
Stanford Health Care - ValleyCare,
Stanford Health Care, Stanford
Sutter Amador Hospital,
Sutter Auburn Faith Hospital,
Sutter Davis Hospital,
Sutter Delta Medical Center,
Sutter Medical Center,
Sutter Roseville Medical Center,
Sutter Santa Rosa Regional Hospital,
Sutter Solano Medical Center,
Sutter Tracy Community Hospital,
Temecula Valley Hospital,
Torrance Memorial Medical Center,
Tri-City Medical Center,
Twin Cities Community Hospital,
UC San Diego Health
UC San Diego Health
UCI Health,
University of California
University of California,
Presbyterian Hospital,
County Medical Center/Santa
Boulder Community Health Foothills Hospital, Boulder
Centura Health - Avista Adventist Hospital, Louisville
Centura Health - Castle Rock Adventist Hospital, Castle Rock
Centura Health - Littleton Adventist Hospital, Littleton
Centura Health - Longmont United Hospital, Longmont
Centura Health - Parker Adventist Hospital, Parker
Centura Health - Penrose Hospital, Colorado Springs
Centura Health - Porter Adventist Hospital, Denver
Centura Health - St. Anthony Hospital, Lakewood
Centura Health - St. Anthony North Hospital, Westminster
Centura Health - St. Francis Medical Center, Colorado Springs
Good Samaritan Medical Center, Lafayette
North Colorado Medical Center, Greeley........................................................... B G I
North Suburban Medical Center, Thornton
Parkview Medical Center, Pueblo
Platte Valley Medical Center, Brighton
Presbyterian/St. Luke’s Medical Center, Denver........................................ B D G I
Rose Medical Center, Denver
Saint Joseph Hospital, Denver
SCL Health - Lutheran Medical Center,
Ridge
SCL Health - St. Mary’s Medical Center, Grand
Sky Ridge Medical Center,
Swedish Medical Center, Englewood
The Medical Center of Aurora, Aurora
UCHealth - Longs Peak Hospital, Longmont
UCHealth Highlands Ranch Hospital, Highlands Ranch..................................
UCHealth Medical Center of the Rockies, Loveland
UCHealth Memorial Hospital North, Colorado
UCHealth Memorial Hospital,
UCHealth Poudre
Hospital,
Bridgeport Hospital, Bridgeport
Charlotte Hungerford Hospital, Torrington
Connecticut Children’s Medical Center, Hartford
Danbury Hospital,
Greenwich Hospital,
Griffin Hospital,
Hartford Hospital,
Lawrence
of Nuvance Health, Danbury
Memorial Hospital,
Midstate Medical Center, Meriden
New Milford Hospital,
Norwalk Hospital
London
of Nuvance Health,
of Nuvance Health,
Saint Francis Hospital and Medical Center,
Sharon Hospital,
St. Vincent’s
Francisco
Milford....................................
AdventHealth
AdventHealth Apopka,
AdventHealth
AdventHealth
AdventHealth
AdventHealth DeLand,
AdventHealth East Orlando,
AdventHealth Fish Memorial,
AdventHealth Kissimmee,
AdventHealth New Smyrna
AdventHealth North Pinellas, Tarpon
AdventHealth Ocala, Ocala
AdventHealth Orlando,
AdventHealth Palm Coast,
AdventHealth Waterman, Tavares
AdventHealth Wesley Chapel, Wesley
AdventHealth Winter Park, Winter
AdventHealth Zephyrhills, Zephyrhills
Baptist Hospital of Miami, Miami
Baptist Medical Center - Beaches
Baptist Medical Center - Jacksonville
Baptist Medical Center - South
Baptist Medical Center of Nassau,
Bay Medical Center-Sacred Heart Health
Bayfront Health St. Petersburg, St.
Bethesda Memorial Hospital, Boynton
Boca Raton Regional Hospital,
Broward Health Imperial Point,
Broward Health Medical Center,
Broward Health North, Pompano
Cape Canaveral Hospital, Cocoa
Cape Coral Hospital, Cape
Cleveland Clinic Florida,
Cleveland Clinic Indian River Hospital,
Cleveland Clinic Martin Health,
Cleveland Clinic Tradition Hospital,
Delray Medical Center,
Flagler Hospital,
Gulf Breeze Hospital,
Gulf Coast Medical Center,
Halifax Health Medical Center
HCA Florida Aventura Hospital,
HCA Florida Bayonet Point Hospital,
HCA Florida Blake Hospital,
HCA Florida Brandon Hospital,
HCA Florida Citrus Hospital,
HCA Florida Fawcett Hospital,
Charlotte
HCA Florida Fort Walton-Destin Hospital, Fort Walton Beach.....................
HCA Florida Gulf Coast Hospital, Panama
HCA Florida JFK Hospital,
HCA Florida Kendall Hospital, Miami
HCA Florida Lake Monroe Hospital, Sanford
HCA Florida Largo Hospital,
HCA Florida Memorial Hospital,
HCA Florida North Florida Hospital,
HCA Florida Northside Hospital, St. Petersburg...............................................B G I
HCA Florida Oak Hill Hospital, Brooksville.........................................................D F I
HCA Florida Ocala Hospital,
HCA Florida Orange Park Hospital, Orange Park
HCA Florida Osceola Hospital, Kissimmee
HCA Florida Sarasota Doctors Hospital, Sarasota
HCA Florida South Tampa Hospital, Tampa
HCA Florida St. Lucie Hospital,
Saint
HCA Florida West Hospital, Pensacola
HCA Florida West Marion Hospital,
part of HCA Florida Ocala Hospital,
HCA Florida Westside Hospital, Plantation.......................................................
Health Park Medical Center, Fort Myers
I Holy Cross Hospital,
Holmes Regional Medical Center,
E I Jackson Memorial Hospital, Miami
Jackson South Medical Center, Miami
James A. Haley Veterans’ Hospital, Tampa
Jupiter Medical Center, Jupiter
Lakeland Regional Health Medical Center, Lakeland
Lakewood Ranch Medical Center, Bradenton..................................................
Lee Memorial Hospital, Fort Myers
Lower Keys Medical Center, Key West
Manatee Memorial Hospital, Bradenton
Mayo Clinic Florida, Jacksonville
Memorial Hospital Miramar, Miramar
Memorial Hospital Pembroke, Pembroke
Memorial Hospital West, Pembroke Pines
Memorial Regional Hospital, Hollywood
Morton Plant Hospital, Clearwater
Mount Sinai Medical Center, Miami Beach
NCH Healthcare System,
Nicklaus Children’s Hospital, Miami.............................................................................
Health
Orlando Health
Orlando Health
Dr. P. Phillips Hospital,
Orlando Regional Medical Center,
South Lake Hospital, Clermont
Orlando Health Arnold Palmer Hospital for Children, Orlando
Orlando Health Inc.
Health Central Hospital,
Orlando Health South Seminole Hospital, Longwood..........................................
Palm Bay Hospital,
Palm
Sacred
St. Joseph’s
Mary’s
Vincent’s
Vincent’s
Vincent’s
General
West Boca Medical Center,
West Kendall Baptist
Winter Haven
AdventHealth Gordon,
AdventHealth Murray,
Atrium Health
Medical Center,
Candler Hospital,
Colquitt Regional Medical Center,
Doctors Hospital Augusta,
East Georgia Regional Medical Center,
Effingham Health System,
Emory Decatur Hospital,
Emory Hillandale,
Emory Johns Creek Hospital,
Emory Saint Joseph’s Hospital,
Emory University Hospital
Emory University Hospital,
Fairview Park Hospital, Dublin
Grady Health System,
Habersham Medical Center,
Hamilton Medical Center,
Houston Healthcare,
Memorial University Medical Center,
Northeast Georgia Medical Center,
Northeast Georgia Medical Center,
Northeast Georgia medical Center,
Northside Hospital Atlanta,
Northside Hospital Cherokee,
Northside Hospital
Northside Hospital
Northside Hospital
Perry Hospital,
Phoebe Putney Memorial Hospital,
Piedmont Athens Regional Medical
Piedmont Augusta Hospital,
Piedmont Cartersville Medical Center,
Piedmont Henry Hospital,
Piedmont Hospital,
Piedmont Macon Medical Center,
Piedmont Mountainside Hospital,
Piedmont Newnan Hospital,
Piedmont Newton Hospital,
Piedmont Rockdale Hospital,
Walton Hospital,
Polk Medical Center,
South Georgia Medical Center, Valdosta.....................................................
Southeast Georgia Health System, Brunswick
Southern Regional Medical Center, Riverdale
St. Francis - Emory Healthcare, Columbus
St. Joseph’s Hospital, Savannah
St. Mary’s Good Samaritan Hospital,
St. Mary’s Hospital, Athens
St. Mary’s Sacred Heart Hospital,
Tanner Medical Center/Carrollton, Carrollton
Tift Regional Medical Center,
Wellstar Cobb Hospital,
Wellstar Douglas Hospital, Douglasville
WellStar
Hospital,
HAWAII
Adventist
Lutheran General
Sherman Hospital,
South Suburban
Memorial Hospital
Alexian Brothers,
Resurrection,
Saint Alexius,
Saint Francis,
Saint Joseph Chicago,
Hospital,
Carle BroMenn Medical Center,
Carle Foundation Hospital,
Cook County Health,
Decatur Memorial Hospital,
Edward Hospital, Naperville
Memorial Hospital,
Herrin Hospital,
HSHS St. Elizabeth’s Hospital,
HSHS St. John’s Hospital, Springfield
HSHS St. Mary’s Hospital, Decatur
Humboldt Park Health, Chicago
Javon Bea Hospital - Riverside,
Loyola University Medical Center,
MacNeal Hospital, Berwyn
Memorial Hospital of Carbondale,
Mount Sinai Hospital, Chicago
Northwest Community Hospital,
Northwestern Medicine Central DuPage Hospital,
Northwestern Medicine Delnor Hospital,
Northwestern Medicine Huntley, Huntley
Northwestern Medicine Kishwaukee Hospital,
Northwestern Medicine Lake Forest Hospital,
Northwestern Medicine McHenry, McHenry
Northwestern Memorial Hospital, Chicago.............................
OSF HealthCare Little Company of Mary Medical
Evergreen Park
OSF HealthCare Saint Anthony’s Health
OSF Saint Anthony Medical Center, Rockford
OSF Saint Francis Medical Center, Peoria
OSF St. Joseph Medical Center, Bloomington
Palos Community Hospital, Palos
Riverside Medical Center, Kankakee
Rush Copley Medical Center,
Rush Oak Park Hospital, Oak Park
Rush University Medical Center, Chicago
Springfield Memorial Hospital,
SSM Health Good Samaritan,
SSM Health St. Mary’s Hospital,
Medicine,
Health,
Health- Methodist,
Health
Medical Center
St. Vincent Hospital,
Health Floyd,
Regional Hospital,
Heart and Vascular,
Community Hospital, Community Healthcare System,
Community South, Indianapolis...............................................................................
Deaconess Gateway Hospital,
Deaconess Hospital, Evansville
Elkhart General Hospital, Elkhart
Eskenazi Health, Indianapolis
Franciscan Health
Crown Point, Crown Point
Franciscan Health Indianapolis, Indianapolis
Franciscan Health Lafayette East, Lafayette
Franciscan Health Michigan City, Michigan
Franciscan Health Mooresville,
Good Samaritan,
Indiana University Health Arnett, Lafayette
Indiana University Health Ball Memorial Hospital, Muncie
Indiana University Health Bloomington Hospital, Bloomington
Indiana University Health Methodist Hospital, Indianapolis
Indiana University Health North Hospital,
Indiana University Health West Hospital,
Lutheran Hospital, Fort Wayne
Memorial Hospital
Bend
Memorial Hospital and Health Care Center, Jasper
Methodist Hospitals, Inc., Gary
Parkview Health, Fort Wayne
Reid Health, Richmond
St. Catherine Hospital, Inc., East Chicago
St. Mary Medical Center, Hobart
St. Vincent Evansville, Evansville
Vincent Kokomo,
Hospital,
Allen Hospital,
CHI Health Mercy Hospital Council Bluffs,
Genesis Health System - Davenport, Davenport
Hancock County Memorial Hospital,
Mercy Iowa City
affiliate of MercyOne, Iowa City........................................
Mercy Medical Center-Cedar Rapids, Cedar Rapids
MercyOne Des Moines Medical
MercyOne Dubuque
Center,
MercyOne North Iowa Medical Center,
MercyOne,
Methodist Jennie Edmundson Hospital, Council
Montgomery County Memorial Hospital, Red Oak
Myrtue Medical Center, Harlan
Southeast Iowa Regional Medical Center, West
The Finley Hospital, Dubuque
Trinity Bettendorf,
UnityPoint Health
UnityPoint Health
UnityPoint Health
University
Luke’s
Luke’s,
AdventHealth Shawnee
Ascension
Centura
Baptist Health Corbin,
Baptist Health Deaconess
Baptist Health Hardin,
Baptist Health LaGrange,
Baptist Health Lexington Hospital,
Baptist Health Louisville,
Baptist Health Paducah,
Clark Regional Medical Center,
Frankfort Regional Medical Center,
King’s Daughters Medical Center,
Mercy Health Lourdes Hospital,
Norton Audubon Hospital,
Norton Brownsboro Hospital,
Norton Hospital,
Owensboro Health,
Medical Center,
Saint Joseph Hospital,
St. Elizabeth Edgewood,
St. Elizabeth Florence,
St. Elizabeth Ft. Thomas,
The Medical Center at
TriStar Greenview Regional
Health
Hospital,
Jefferson General Hospital
General Medical
Regional Medical
Leonard J. Chabert Medical
Orleans East Hospital,
Baptist,
Health
Jefferson Medical Center,
Maine
Maine Medical Center,
Medical
Light Mercy
Bay Medical
Adventist HealthCare
Adventist HealthCare
Grove Medical Center,
Oak Medical Center, Silver Spring
Ascension Saint Agnes Hospital, Baltimore
CalvertHealth Medical Center,
Carroll Hospital Center, Westminster
ChristianaCare
Frederick
Union Hospital, Elkton
Doctors Community Medical Center, Lanham
Frederick Health Hospital, Frederick
Greater Baltimore Medical Center, Baltimore
Holy Cross Germantown Hospital, Germantown
Holy Cross Hospital, Silver Spring
Howard County General Hospital, Columbia
Johns Hopkins Bayview Medical Center, Baltimore
Luminis Health Anne Arundel Medical Center, Annapolis
MedStar Franklin Square Medical Center, Baltimore
MedStar Good Samaritan Hospital, Baltimore
MedStar Harbor Hospital, Baltimore.......................................................................
MedStar Montgomery Medical Center, Olney
MedStar Southern Maryland Hospital Center, Clinton
MedStar St. Mary’s Hospital,
MedStar Union Memorial Hospital,
Mercy Medical Center, Baltimore
Meritus Medical Center, Hagerstown
Northwest Hospital, Randallstown
Sinai Hospital of Baltimore, Baltimore.................................
Suburban Hospital Johns Hopkins Medicine, Bethesda
The Johns Hopkins Hospital, Baltimore............................................
TidalHealth Peninsula Regional, Salisbury
University of Maryland Baltimore Washington Medical Center, Glen Burnie
University of Maryland Capital Region Medical Center, Largo
University of Maryland Charles Regional Medical Center, La Plata..............
University of Maryland Harford Memorial Hospital, Havre De Grace
University of Maryland Medical Center, Baltimore.......................................
University of Maryland Shore Medical Center at Easton, Easton
University of Maryland St. Joseph Medical Center, Towson
University of Maryland Upper Chesapeake Medical Center, Bel
UPMC Western Maryland, Cumberland
Lady
Beth Israel Deaconess Hospital
Beth Israel Deaconess Medical Center,
Hospital,
Boston Children’s Hospital,
Medical Center,
and Women’s
and Women’s Hospital,
Cooley Dickinson Hospital,
Hospital,
Fairview Hospital, Great
Hospital,
Good Samaritan Medical Center,
Holy Family Hospital - Haverhill,
Holy Family Hospital - Methuen,
Holyoke Medical Center,
Lahey Hospital & Medical Center,
General Hospital,
Lowell General Hospital - Main Campus,
Lowell General Hospital - Saints Campus,
Massachusetts General Hospital,
Melrose-Wakefield Hospital,
Mercy Medical Center,
MetroWest Medical Center - Framingham
Milford Regional Medical Center,
Mount Auburn Hospital,
Newton-Wellesley Hospital,
North Shore Medical Center
Saint Vincent Hospital,
Signature Healthcare Brockton Hospital,
Southcoast Health Charlton Memorial Hospital,
Southcoast Health St. Luke’s Hospital,
Southcoast Health Tobey Hospital,
Steward St. Elizabeth’s Medical Center,
Sturdy Memorial Hospital,
Tufts Medical Center,
UMass Memorial - Marlborough Hospital,
UMass Memorial HealthAlliance-Clinton Hospital,
UMASS Memorial HealthAlliance-Clinton Hospital,
UMass Memorial Medical Center -
UMass Memorial Medical Center,
Ascension Borgess Hospital,
Macomb
Providence Hospital
Providence Hospital
St. John
Ascension St. Mary’s Hospital,
Beaumont
Henry Ford Allegiance Health, Jackson
Henry Ford Hospital and Health Network, Detroit...........................................
Henry Ford Macomb Hospital, Clinton
Henry Ford West Bloomfield Hospital, West Bloomfield
Henry Ford Wyandotte Hospital, Wyandotte
Hurley Medical Center,
McLaren Bay Region,
Flint,
McLaren Greater Lansing, Lansing
McLaren Lapeer Region,
Macomb, Mount
McLaren Northern Michigan, Petoskey
McLaren Port Huron Hospital, Port Huron
Mercy Health Partners d/b/a Trinity Health Muskegon Hospital, Muskegon
Metro Health - University of Michigan Health, Wyoming
MidMichigan Medical Center-Midland
System, Midland
Munson Medical Center, Traverse City
affiliate of MidMichigan
ProMedica Charles and Virginia Hickman Hospital,
Sparrow Hospital, Lansing
Spectrum Health Blodgett Hospital, Grand Rapids....................................................
Spectrum Health Butterworth, Grand Rapids
Spectrum Health Lakeland: St. Joseph and Niles, Saint Joseph...................
Spectrum Health United Hospital, Greenville
Spectrum Health Zeeland Community Hospital, Zeeland
St. Mary Mercy Hospital, Livonia
Trinity Health Saint Mary’s - Grand Rapids, Grand Rapids
Trinity Health St. Joseph Mercy Oakland, Pontiac
University of Michigan Health System, Ann Arbor
Abbott Northwestern Hospital, Minneapolis
CentraCare St. Cloud Hospital, Saint Cloud
Essentia Health East. St. Mary’s Medical Center, Duluth
Hennepin Healthcare System, Inc., Minneapolis
Lakeview Memorial Hospital, Stillwater
M Health Fairview Southdale Hospital, Edina
M Health Fairview University of Minnesota Medical Center, Minneapolis
Mayo Clinic Hospital, Saint Marys Campus, Rochester
Mercy Hospital, Coon Rapids
Park Nicollet Methodist Hospital, Saint Louis Park
Regions Hospital,
St. Francis Regional Medical
St. Luke’s,
Hospital,
Baptist Memorial Hospital
Baptist Memorial
General
Leflore
Singing River Hospital,
Dominic Memorial Hospital,
Mississippi
Barnes-Jewish Hospital, Saint
Boone Hospital Center, Columbia
Capital Region Medical Center,
Cass Regional Medical Center,
Centerpoint Medical Center,
Cox Medical Center Branson,
Cox Medical Center South,
Cox Monett Hospital Inc,
Freeman Health System, Joplin
Lake Regional Health System, Osage
Mercy Hospital Jefferson, Crystal
Mercy Hospital Joplin, Joplin
Mercy Hospital Lincoln,
Mercy Hospital South, Saint Louis
Mercy Hospital Springfield, Springfield
Mercy Hospital St. Louis, Saint Louis
Mercy Hospital Washington, Washington
Missouri Baptist Medical Center, Saint
Missouri Baptist Sullivan Hospital,
Mosaic Life Care d/b/a Heartland
New Liberty Hospital District, Liberty
North Kansas City Hospital, North
Parkland Health Center, Farmington
Phelps Health, Rolla
Research Medical Center, Kansas City
Saint Francis Medical Center, Cape
Saint Luke’s East Hospital, Lees Summit
Saint Luke’s Hospital of Kansas City, Kansas
Saint Luke’s North Hospital, Kansas
Health, Cape Girardeau
SSM Health DePaul Hospital,
SSM Health
Louis
SSM Health St. Mary’s Hospital,
SSM Health, St. Clare Hospital,
SSM St. Joseph Hospital Lake St. Louis,
Joseph Medical Center,
Luke’s
Peres Hospital,
Mary’s Health Center,
St. Mary’s Medical Center,
Missouri Health
Health
Health
Health
Health
Health
Regional
Kearney Regional Medical Center,
Medicine
Medicine,
Methodist Hospital,
Centennial Hills Hospital Medical Center, Las Vegas
Desert Springs Hospital Medical Center, Las Vegas
Dignity Health St. Rose Dominican Hospital - San Martin Campus, Las Vegas
Dignity Health St. Rose Dominican Hospital - Siena Campus,
ER at Blue Diamond, Las
Henderson Hospital,
MountainView Hospital, Las
North Vista
Nevada
Saint Mary’s
Hills
Valley Hospital
Summerlin Hospital Medical
Hospital
Hospital
Hackensack
Hackensack
Hackensack
Hackensack
Hackensack
Hackensack
Hackensack
Hackensack
Pascack
Hackettstown Medical Center,
Medical Center,
Hunterdon Healthcare,
Inspira Medical Center
Inspira Medical Center
Cherry Hill
Stratford Hospital,
Jersey City Medical Center,
Monmouth Medical Center,
Morristown Medical Center,
Newark Beth Israel Medical Center,
Newton Medical Center,
Overlook Medical Center,
Penn Medicine Princeton Medical Center,
Robert Wood Johnson University
Robert Wood Johnson
Saint Clare’s Health,
Saint Peter’s University Hospital,
St. Francis Medical Center, Trenton
St. Joseph’s University Medical Center,
St. Joseph’s Wayne Medical Center,
St. Luke’s Warren Hospital,
St. Mary’s General Hospital,
The Valley Hospital,
Trinitas Regional Medical Center,
Hospital,
Virtua Marlton Hospital,
Virtua Memorial Hospital of Burlington
Virtua Our Lady of Lourdes
Virtua Voorhees Hospital,
Virtua Willingboro Hospital,
Eastern New Mexico Medical Center,
Medical Center,
MountainView Regional Medical
Presbyterian Healthcare Services,
NEW YORK
Albany Med,
Catholic Health - Sisters of
Medical Center,
Children’s
Memorial Hospital,
Hospital,
Medicine,
F.F. Thompson Hospital,
St. Luke’s Healthcare,
System,
Flushing Hospital Medical
Health Medical
Health Medical
Gates Vascular Institute
General Hospital,
Cove Hospital, Glen
Falls Hospital,
of Mohawk Valley
General Medical Center,
Good Samaritan Hospital Medical Center, West
Samaritan Hospital,
HealthAlliance: Broadway Campus
Hospital, Rochester
Hospital, Huntington
of
Health, Suffern
Member of
Hospital Medical Center, Richmond
Kingsbrook Jewish Medical Center, Brooklyn
Lenox Hill Hospital, New York
LIJ Medical Center at Forest Hills, Forest Hills
LIJ Valley Stream, Valley Stream
Island Community Hospital,
Long Island Jewish Medical Center,
Maimonides Medical Center,
Mather Hospital Northwell Health,
Mercy Medical Center, Rockville Centre
WMC Health Network,
MidHudson Regional Hospital of WMC Health, Poughkeepsie
Montefiore Medical Center - Moses Campus, Bronx
Montefiore Mount Vernon Hospital, Mount Vernon
Montefiore New Rochelle Hospital, New Rochelle
Montefiore Nyack Hospital, Nyack
Montefiore St. Luke’s Cornwall, Newburgh
Mount Sinai Beth Israel, New York
Mount Sinai Brooklyn, Brooklyn
Mount Sinai Morningside, New York
Mount Sinai Queens, Astoria
Mount Sinai South Nassau, Oceanside...........................................
Mount Sinai West, New York
Nassau University Medical Center, East Meadow
New York Community Hospital, Brooklyn
Newark-Wayne Community Hospital, Newark
NewYork-Presbyterian Brooklyn Methodist Hospital, Brooklyn
NewYork-Presbyterian Hudson Valley Hospital, Cortlandt Manor
NewYork-Presbyterian Queens, Flushing
NewYork-Presbyterian/Columbia University Medical Center, New York.......................................................................................................
NewYork-Presbyterian/Lawrence
NewYork-Presbyterian/Lower
North
NYC Health
NYC Health
NYC Health
NYC Health
NYC Health
Health
NYC Health
Health
NYC Health
Hospitals/Harlem,
Hospitals/Jacobi,
Hospitals/Lincoln,
Hospitals/Metropolitan,
Hospitals/Queens,
Hospitals/Woodhull,
Langone Hospital
NYU Langone Hospital
NYU Langone Hospitals,
Our Lady of Lourdes Memorial Hospital,
Peconic Bay Medical Center
Hospital, Northwell
Plainview Hospital, Plainview
Richmond University Medical Center,
Rochester General Hospital,
Rochester Regional Health
Rome Memorial Hospital,
Saint Joseph’s Medical Center,
Samaritan Hospital,
Saratoga Hospital, Saratoga
SBH Health System,
Soldiers & Sailors Memorial Hospital,
South Shore University Hospital,
Southampton Hospital,
St. Catherine of Siena Medical Center,
St. Charles Hospital, Port Jefferson
St. Francis Hospital, The Heart
St. John’s Episcopal Hospital,
St. John’s Riverside Hospital,
St. Joseph Hospital,
St. Joseph’s Health,
St. Peter’s Hospital,
Staten Island University Hospital
Staten
Staten Island University Hospital,
Stony Brook University Hospital,
Syosset Hospital,
Brooklyn Hospital
Mount
University
Hospital
Vermont
University
Atrium Health
Atrium Health
Atrium
Atrium Health
Atrium Health Stanly,
Atrium Health Union,
Atrium Health University City,
Atrium Health Wake Forest Baptist High Point Medical Center,
Atrium Health Wake Forest Baptist Lexington Medical Center, Lexington
Atrium Health Wake Forest Baptist Medical Center, Winston-Salem
Atrium Health’s Carolinas Medical Center, Charlotte
Blue Ridge Regional Hospital, Spruce Pine
Cape Fear Valley Medical Center, Fayetteville
CarolinaEast Medical Center, New Bern
CaroMont Regional Medical Center, Gastonia
Carteret Health Care Medical Center, Morehead City
Central Carolina Hospital, Sanford
Columbus Regional Healthcare,
Cone Health - Alamance Regional, Burlington
Cone Health, Greensboro
Davis Regional Medical Center, Statesville
Duke Raleigh Hospital, Raleigh
Duke Regional Hospital, Durham
Duke University Hospital, Durham........................................
Durham VA HealthCare System, Durham
ECU Health Beaufort Hospital - A Campus of ECU Health Medical Center, Washington
ECU Health Bertie Hospital, Windsor
ECU Health Chowan Hospital, Edenton
ECU Health Medical Center, Greenville
ECU Health Roanoke-Chowan Hospital, Ahoskie
FirstHealth Moore Regional Hospital - Hoke, Raeford
FirstHealth Moore Regional Hospital, Pinehurst
Frye Regional Medical Center, Hickory
Hugh Chatham Memorial Hospital, Elkin
Johnston Health, Smithfield
Mission Hospital McDowell, Marion
Mission Hospitals, Inc., Asheville
Nash UNC Health Care, Rocky Mount...................................................... B A A E I
Northern Regional Hospital, Mount Airy
Novant Health Brunswick Medical Center, Bolivia
Novant Health Forsyth Medical Center, Winston-Salem........
Novant Health Huntersville Medical Center, Huntersville
Novant Health Kernersville Medical Center, Kernersville
Novant Health Matthews Medical Center, Matthews
Novant Health Mint Hill Medical Center, Charlotte
Novant Health New Hanover Regional Medical Center, Wilmington
Novant Health Presbyterian Medical Center, Charlotte
Novant Health Rowan Medical Center, Salisbury
Novant Health Thomasville Medical Center,
Memorial Hospital,
Pardee Hospital,
Albemarle Medical
Transylvania Regional Hospital,
Ashtabula County Medical Center,
Atrium Medical Center,
Aultman Alliance Community Hospital,
Hospital,
Blanchard Valley Health System,
Cleveland Clinic Akron General Medical Center,
Cleveland Clinic Avon Hospital,
Cleveland Clinic Euclid Hospital,
Cleveland Clinic Fairview Hospital,
Cleveland Clinic Hillcrest Hospital,
Cleveland Clinic Marymount Hospital,
Cleveland Clinic Medina Hospital,
Cleveland Clinic Mercy Hospital,
Cleveland Clinic South Pointe Hospital,
Cleveland Clinic,
Coshocton Regional Medical Center,
Fairfield Medical Center, Lancaster
Firelands Regional Medical Center,
Fisher Titus Medical Center, Norwalk
Genesis Healthcare System, Anesville
Good Samaritan Hospital, Cincinnati
Kettering Health Dayton, Dayton
Kettering Health Greene Memorial,
Kettering Health Hamilton, Hamilton
Kettering Health Main Campus, Dayton
Kettering Health Miamisburg, Miamisburg
Kettering Health Troy, Troy........................................................................................
Licking Memorial Hospital, Newark
Lima Memorial Health System, Lima
Louis Stokes Cleveland VA Medical Center,
McLaren St. Luke’s, Maumee
Mercy Health - Anderson Hospital,
Mercy Health - Fairfield Hospital
Mercy Health - St. Elizabeth Youngstown
Mercy Health West Hospital, Cincinnati
Mercy St. Vincent Medical Center, Toledo
Miami Valley Hospital, Dayton
Mount Carmel Health System, Columbus
Mount Carmel St. Ann’s, Westerville
Ohio State University Wexner Medical Center,
OhioHealth Doctors Hospital, Columbus
OhioHealth Grant Medical Center, Columbus
OhioHealth Mansfield Hospital, Mansfield
OhioHealth Marion General Hospital, Marion
OhioHealth Riverside Methodist Hospital,
Pomerene Hospital, Millersburg
ProMedica Flower Hospital, Sylvania
Toledo Hospital,
Soin Medical Center,
Southwest General Health Center, Middleburg Heights
Springfield Regional Medical Center, Springfield
St. Rita’s Medical Center, Lima
Summa Akron City Hospital, Akron
The Christ Hospital, Cincinnati
The Jewish Hospital Mercy Health, Cincinnati......................................................
The MetroHealth System, Cleveland
The University of Toledo Medical Center, Toledo
TriHealth Bethesda North Hospital, Cincinnati
Regional Hospitals, Bedford Medical Center and
Medical Center, Richmond Heights
University Hospitals Ahuja Medical Center, Beachwood
University Hospitals Cleveland Medical Center, Cleveland
University Hospitals Elyria Medical Center, Elyria
University Hospitals Geauga Medical Center, Chardon
University Hospitals Geneva Medical Center, Geneva
University Hospitals Parma Medical Center, Parma
University Hospitals Portage Medical Center, Ravenna
University Hospitals Samaritan Medical Center, Ashland
I University Hospitals Tripoint Medical Center/ University Hospitals
University Hospitals St. John Medical Center, Westlake
West Medical Center, Painesville
University of Cincinnati Medical Center, Cincinnati
Upper Valley Medical Center, Troy
West Chester Hospital, West Chester
Western Reserve Hospital, LLC, Cuyahoga Falls
Community Hospital,
Ascension St. John Medical Center, Tulsa
Comanche County Memorial Hospital, Lawton
Hillcrest Hospital South, Tulsa
Hillcrest Medical Center, Tulsa.................................................................
INTEGRIS Baptist Medical Center, Oklahoma City
Southwest Medical Center,
Hospital
Norman Regional Health System,
Northeastern Health System,
OU Health University of Oklahoma Medical Center,
Saint Francis Hospital Muskogee, Muskogee
Saint Francis Hospital,
Anthony Hospital,
Center,
Hospital,
Medical
Hospital,
Roger Williams Medical
Aiken Regional Medical Center,
Health,
Beaufort Memorial Hospital,
Bon Secours St. Francis
Bon Secours
Secours
Carolina Pines Regional Medical Center,
Coastal Carolina Hospital,
Conway Medical Center,
East Cooper Medical Center,
Grand Strand Medical Center,
Hampton Regional Medical Center,
Hilton Head Hospital,
Lexington Medical Center,
McLeod Health Cheraw, Cheraw
McLeod Health Dillon,
McLeod Health Seacoast,
McLeod Regional Medical Center,
Mount Pleasant Hospital, Mount
MUSC Health - Lancaster Medical Center,
MUSC Health, Charleston
Pelham Medical Center,
Piedmont Medical Center,
Prisma Health Baptist Easley Hospital,
Prisma Health Baptist Hospital,
Prisma Health Baptist Parkridge Hospital,
Prisma Health Greenville
Prisma Health Greer Memorial Hospital,
Prisma Health Hillcrest Hospital,
Prisma Health Laurens County Hospital,
Prisma Health Oconee Memorial
Prisma Health Richland Hospital,
Ralph H. Johnson VA Medical
Regional Medical Center
Roper
Baptist Memorial Hospital Memphis,
Blount Memorial Hospital, Maryville
CHI Memorial Hospital
CHI Memorial Hospital Hixson, Hixson
Erlanger Baroness Hospital, Chattanooga
Fort Sanders Regional Medical Center, Knoxville
Holston Valley Medical Center, Kingsport
Jackson-Madison County General Hospital, Jackson
Johnson City Medical Center, Johnson
LeConte Medical Center, Sevierville
Maury Regional Medical Center, Columbia
Methodist Germantown Hospital, Germantown
Methodist Medical Center, Oak Ridge
Methodist North Hospital, Memphis
Methodist South Hospital, Memphis
Methodist University Hospital, Memphis
Morristown-Hamblen Healthcare System, Morristown
Newport Medical Center,
North Knoxville Medical Center,
NorthCrest Medical Center,
Parkridge Medical Center, Chattanooga
Parkwest Medical Center, Knoxville
Roane Medical Center, Harriman
Saint Francis Hospital - Memphis, Memphis
Saint Thomas Midtown Hospital, Nashville................................................
Saint Thomas Rutherford Hospital, Murfreesboro
Saint Thomas West Hospital, Nashville
St. Francis Hospital - Bartlett, Bartlett
The University of Tennessee Medical Center, Knoxville
TriStar Centennial Medical Center, Brentwood
TriStar Hendersonville Medical Center, Hendersonville
TriStar Skyline Medical Center, Nashville
TriStar Southern Hills Medical Center, Nashville
TriStar Stonecrest Medical Center, Smyrna......................................................
TriStar Summit Medical Center,
Baptist Hospitals of Southeast Texas, Beaumont
Baylor Scott & White All Saints Medical Center
Baylor Scott & White Heart and Vascular Hospital
Baylor Scott & White Medical Center - Centennial,
Worth,
Dallas,
Baylor Scott & White Medical Center - College Station,
Baylor Scott & White Medical Center - Grapevine,
Baylor Scott & White Medical Center - Hillcrest,
Baylor Scott & White Medical Center - Irving,
Baylor Scott & White Medical Center - Lake Pointe, Rowlett
Baylor Scott & White Medical Center - Marble Falls, Marble
Baylor Scott & White Medical Center - McKinney, McKinney.........................
Baylor Scott & White Medical Center - Pflugerville, Pflugerville
Baylor Scott & White Medical Center - Plano, Plano..................................
Baylor Scott & White Medical Center
Round Rock,
Baylor Scott & White Medical Center - Temple, Temple
Baylor Scott & White Medical Center - Waxahachie, Waxahachie
Baylor Scott & White The Heart Hospital - Plano, Plano
Baylor University Medical Center - Dallas, Dallas
Ben Taub Hospital, Houston
Brazosport Regional Health System,
Health System, Amarillo
Carrollton Regional Medical Center, Carrollton
Cedar Park Regional Medical Center,
CHI St. Luke’s Health - Baylor St. Luke’s Medical
Children’s Medical Center Dallas,
CHRISTUS Good Shepherd Health System
CHRISTUS Good Shepherd Health System-Marshall,
CHRISTUS Mother Frances Hospital-Tyler,
CHRISTUS Santa Rosa Health, San Antonio
CHRISTUS Spohn Hospital Corpus Christi
CHRISTUS Spohn Hospital Corpus Christi -
CHRISTUS St. Michael Health System, Texarkana
Citizens Medical Center, Victoria
Corpus Christi Medical Center, Corpus Christi
Covenant Medical Center,
Cuero Regional Hospital, Cuero
Dallas Regional Medical Center,
Del Sol Medical Center, El Paso
Dell Seton Medical Center at The University
DeTar Healthcare System, Victoria
Doctors Hospital at Renaissance, Edinburg
Houston Methodist Willowbrook Hospital, Houston
Huntsville Memorial Hospital,
JPS Health Network,
Knapp Medical Center,
Palmas Medical Center,
Medical Center Hospital,
Medical City Dallas,
Medical City Plano,
Memorial Hermann Memorial City Medical Center, Houston
Methodist Charlton Medical Center,
Methodist Dallas Medical Center, Dallas...........................................................
Methodist Hospital
Metropolitan, San
Harlingen Medical Center, Harlingen.......................................................................
HCA Houston Healthcare - Clear Lake,
Houston Healthcare
Houston Healthcare -
Houston Healthcare
Houston Healthcare -
Houston Healthcare -
Houston Healthcare -
Heart Hospital of Austin,
Hendrick Medical Center South,
Hendrick Medical Center,
Houston Methodist
Houston Methodist
Houston Methodist Hospital,
Houston Methodist
Houston Methodist
Houston Methodist West
Methodist Hospital
Northeast, San Antonio
Stone
Methodist Hospital, San
B E I Methodist Mansfield Medical Center, Mansfield
Midland Memorial Hospital, Midland
A A Mission Regional Medical Center, Mission
Northwest Texas Healthcare System, Amarillo
B E I OakBend Medical Center Williams Way Campus, Richmond
A Odessa Regional Medical Center, Odessa
A Parkland Health
Hospital System, Dallas
Rio Grande Regional Hospital, McAllen
B F I Shannon Medical Center, San Angelo
South Texas Health System, Edinburg............................................................... B G I
St. David’s Georgetown Hospital, Georgetown
A St. David’s Medical Center, Austin
St. David’s North Austin Medical Center, Austin
St. David’s South Austin Medical Center, Austin
B B A E I St. David’s Round Rock Medical Center, Round Rock
B B A E I
St. Joseph Health College Station Hospital, College Station
St. Joseph Medical Center, Houston
St Luke’s Health-Memorial Lufkin, Lufkin
St. Luke’s Health - The Woodlands Hospital, The Woodlands
Texas Health Arlington Memorial Hospital, Arlington
Texas Health Harris Methodist Hospital Fort Worth, Fort Worth
Texas Health Harris Methodist Hospital Hurst-Euless-Bedford,
B B A F
B C I St. Joseph Health Regional Hospital, Bryan
B E I
B B G II
B B A G I
B E
B A F J
Texas Health Harris Methodist Hospital Southwest Fort Worth, Fort Worth
D A
Texas Health Heart & Vascular Hospital Arlington, Arlington.................. B B A G
Texas Health Huguley Hospital Fort Worth South, Burleson
B
Texas Health Presbyterian Hospital Dallas, Dallas............................... B B A E I Texas Health Presbyterian Hospital Denton, Denton
Texas Health Presbyterian Hospital Plano, Plano
Texas Vista Medical Center, San Antonio
Texoma Medical Center, Denison
The Hospitals of Providence East Campus, El Paso
The Hospitals of Providence Sierra Campus, El Paso
The Hospitals of Providence Transmountain Campus, El Paso
Titus Regional Medical Center, MT Pleasant..........................................
United Regional Healthcare System, Wichita Falls
University Health
University Medical
Valley
B B G I
B B A E
B E I
B F J I
B I
B G I
B
B E
Hospital
Valley
Lakeview Hospital,
Hospital
University of
Augusta Health, Fishersville
Bon Secours Mary Immaculate Hospital,
Bon Secours Maryview Medical Center,
Bon Secours Memorial Regional
Bon Secours Rappahannock General
Bon Secours St. Francis Medical Center,
Bon Secours St. Mary’s Hospital,
Carilion Roanoke Memorial Hospital,
Centra Lynchburg General Hospital,
Chesapeake Regional Medical Center,
Fauquier Hospital,
HCA Chippenham Medical Center,
HCA Johnston-Willis Hospital,
Inova Alexandria Hospital, Alexandria
Inova Fair Oaks Hospital, Fairfax
Inova Fairfax Hospital, Falls Church
Inova Loudoun Hospital, Leesburg
Inova Mount Vernon Hospital,
Mary Washington Hospital,
Reston Hospital Center,
Riverside Doctors’ Hospital Williamsburg,
Riverside Regional Medical Center,
Riverside Shore Memorial Hospital,
Riverside Walter Reed Hospital,
Sentara CarePlex Hospital,
Sentara Leigh Hospital,
Sentara Martha Jefferson Hospital,
Sentara Norfolk
Sentara Northern Virginia
Sentara Princess
Sentara RMH Medical
Sentara Virginia
Sentara Williamsburg
Stafford Hospital,
StoneSprings Hospital
VCU Health
Hospital Center,
WASHINGTON
Confluence Health-Central Washington Hospital,
Medical Center,
Medical Center,
Kadlec Regional Medical Center,
Kittitas Valley Healthcare,
Legacy Salmon Creek Medical Center,
MultiCare Auburn Medical Center,
Covington Medical Center,
MultiCare Deaconess Hospital,
MultiCare Tacoma General Hospital,
Overlake Medical Center
Clinics,
PeaceHealth Southwest Medical Center,
PeaceHealth St. Joseph Medical Center, Bellingham
PeaceHealth United General Medical Center, Sedro Woolley
Providence Centralia Hospital,
Providence Holy Family Hospital, Spokane
Providence Regional Medical Center Everett, Everett
Providence Sacred Heart Medical Center
Providence St. Mary Medical Center,
Providence St. Peter Hospital,
Saint Anthony Hospital,
Saint Clare Hospital, Lakewood
Saint Joseph Medical Center,
Saint Michael Medical Center,
Seattle Children’s Hospital,
St. Anne Hospital, Burien
St. Francis Hospital,
Swedish Edmonds, Edmonds
Swedish Medical Center
Swedish Medical Center
Swedish Medical Center
Swedish Medical Center
Trios Health,
University
UW Medicine
Hill
Hill
Washington Medical Center,
Valley Medical
Hospital,
Bellin Memorial Hospital,
Memorial Hospital,
Hospital,
Bay
Menomonee Falls Hospital, Menomonee Falls
Froedtert Pleasant Prairie Hospital, Pleasant Prairie............................................
West Bend Hospital, West Bend
Gundersen Lutheran Medical Center,
HSHS Sacred Heart Hospital,
Medical Center
Eau Claire,
Marshfield Medical Center, Marshfield
Mayo Clinic Health System LaCrosse, La Crosse
Mayo Clinic Health System - Eau Claire, Eau Claire
Mercy Hospital and Trauma Center, Janesville
ProHealth Care, Oconomowoc Memorial Hospital, Oconomowoc
Aspirus
Aurora BayCare
Aurora Lakeland Medical
Aurora Medical Center
Aurora Medical Center
Aurora Medical Center
Aurora Medical Center
Aurora Medical Center
Aurora Medical Center
Aurora Medical Center
Aurora Sheboygan Memorial Medical
Aurora Sinai Medical Center,
Aurora St. Luke’s Medical Center,
Aurora St. Luke’s South Shore, Cudahy
Aurora West Allis Medical Center,
ProHealth Care, Waukesha Memorial Hospital, Waukesha
Richland Hospital, Richland Center
SSM Health St. Mary’s Hospital - Madison, Madison......................................
St. Agnes Hospital, Fond Du Lac
St. Mary’s Janesville Hospital, Janesville
St. Nicholas Hospital, Sheboygan
ThedaCare Regional Medical Center - Appleton, Appleton.................................
Regional Medical Center - Neenah, Neenah
UnityPoint Health -Meriter,
University of Wisconsin Hospital and Clinics, Madison.......................
Hills Health,
Cheyenne Regional Medical Center,
Star Valley Health, Afton
Medical Center, Casper
the group that experienced VR technology reported a 24% drop in pain scores. The other 50 patients, who watched a standard, 2D nature video with relaxing scenes on a nearby screen, experienced only a 13.2% reduction in pain.
“Virtual reality has been shown to reduce pain when used within the hospital in a variety of studies,” says Spiegel, who is also director of health services research at Cedars-Sinai and author of the book, “VRx: How Vir tual Therapeutics Will Revolutionize Medicine.” “We have also developed a digital pain reduction kit, includ
ining the use of VR to ease pain in adults and children with complex regional pain syndrome, or CRPS, and patients with cerebral palsy and peripheral idiopathic facial pain.
“In the past, there were very few labs that were working in VR because it was so expensive and technically challenging, but once consumer equipment became available, many more researchers started envisioning new potential applications for virtual reality,” Won says. “There’s huge potential for VR as a therapeutic option, but we don’t want this to be oversold and people to get excited about VR treatments before they are proven effective.”
Researchers are also looking into the potential side effects of VR, such as whether it could be addictive.
“We have not seen abuse among our patients who are using it for thera peutic purposes, and in fact, what we have observed is that people don’t love using VR after 20 to 30 minutes,” Spiegel says.
The most common side effect for some patients, according to Spiegel, is “cybersickness,” the feeling of diz ziness and nausea when the patient is wearing a VR headset. Patients also have experienced side effects such as blurred vision, eye strain and head ache. He says less than 5% of patients experience these effects, which usually disappear when the headset comes off and often decrease with subsequent use and treatment sessions.
ing virtual reality, used at home to help patients improve quality of life and reduce their need for pain medications.”
More study needed. Despite all the excitement around VR and its promise for managing pain and po tentially reducing the need for opi oids, the exact mode behind how VR impacts pain remains unknown. Some experts speculate that VR creates a form of analgesia by changing the activity of the body’s pain modulation system, while others postulate that VR serves as a “pain distraction,” reducing the perception of pain by absorbing and diverting attention away from the pain.
Andrea Stevenson Won believes in the potential of VR technology, but she also recognizes the need for more studies. Won is director of the Virtual Embodiment Lab at Cornell University in New York, where she’s an as sistant professor of communication with the College of Agriculture and Life Sciences. She has led studies exam
The explosion of interest in VR tech nology seems endless. In November 2021, the Food and Drug Administra tion approved the first VR technology – now called RelieVRx – for the treat ment of adult patients with diagnosed chronic lower back pain. RelieVRx uses the principles of cognitive behavioral therapy to help blunt pain.
As one of a few approved “digiceuticals,” aka digital therapeu tics, the device is intended for at-home self-use and consists of a VR headset, controller and a “breathing amplifier” attached to the headset that directs a patient’s breath toward the headset’s mi crophone for use in deep breathing exercises. The FDA approval “sets a positive pathway for future advancements,” Spiegel says, because the agency “provided a special breakthrough designation for the device.”

Several other companies have entered the VR field to discover the next generation of systems that go beyond being a distraction therapy and work by focusing the brain away from pain. One com pany, CognifiSense, is working on a completely new type of VR therapy, which has been dubbed “VR neuropsychological therapy.” This approach aims to change how the brain perceives pain and create a lasting reduction in pain.
“There are so many researchers dedicated to keeping this an evidence-based branch of medicine,” Spiegel says, “to further study where VR is appropriate and where it’s not appropriate, and how we can best help patients living with chronic pain.” l
IN NOVEMBER 2021, the World Health Organization classified omicron as a new COVID-19 variant of concern, after a team of South African scientists sounded alarm bells about its highly transmissible nature. Just two months later, vaccine maker Mod erna started a clinical trial to study the effectiveness of an omicron-specific booster shot.
The new mRNA technology behind the Moderna and Pfiz er-BioNTech COVID-19 vaccines is being hailed as a game changer in the future battle against infectious diseases, and even against some cancers. That’s largely because of how quickly mRNA vaccines can be developed in response to new invaders – and then tweaked if those invaders mutate to try to escape an immune attack. “There are hundreds and hundreds of diseases for which mRNA could be useful,” says Dr. Drew Weiss man, a professor of medicine at the University of Pennsylvania whose lab has developed several mRNA vaccines that are on the verge of human testing.
Next up: the flu. Making an mRNA vaccine entails taking a piece of a virus’s DNA strand –in the case of COVID, it’s the part that makes the spike protein that gives the virus that studded appearance – and using it to teach the immune system to recognize and eliminate the virus. The vaccine causes cells to make the target protein, prompting the immune system to eradicate the virus anytime it appears in the body.
One target for which the technology is considered especially promising: influenza. Manufacturing the seasonal flu vaccine currently is a laborious six-month-or-longer process that in volves growing what are predicted to be the dominant virus strains in eggs, harvesting and inactivating them, and then making vaccine doses at huge scale. If an unexpected strain pops up, the vaccine can’t be changed on a dime to cover it. An mRNA vaccine that teaches the body to recognize hemaggluti nin A or B, the proteins on the surface of flu viruses, could be developed much faster and adjusted quickly, Weissman says.
Moderna is now developing five mRNA vaccines covering four seasonal flu viruses, three of which are in human testing.
Weissman and a range of companies, including mRNA vaccine developer CureVac, are using the technology to try to develop a universal flu vaccine – a single shot that could cover most strains of the influenza A virus that emerge over time. Rather than target the “head” of the hemagglutinin pro tein, which tends to mutate every year, the vaccine would be designed to elicit an immune response to the less changeable “stem” or “stalk” region, Weissman explains.

Other targets. Moderna and BioNTech are also working on mRNA vaccines to prevent HIV, a virus that mutates quickly. The idea is to use the technology to elicit broadly neutralizing an tibodies, immune proteins that target the virus and keep it at bay even as it changes, says Dr. Rajesh Gandhi, an infectious dis eases physician and co-director of the Harvard University Center for AIDS Research.
And mRNA technologies could be applied to develop vaccines against other viruses that can hide out in the body for years, often producing no symptoms but raising the risk of other diseases. Epstein-Barr virus, or EBV, has been linked to an increased risk of multiple sclerosis and some cancers, for example. In February 2020, just before the pandemic diverted the biopharma in dustry’s attention, Moderna announced it was starting clinical trials of an mRNA vaccine to prevent EBV.
“There is increasing evidence that infectious agents may be a trigger for some of the major diseases of mankind,” says Dr. Anthony Komaroff, a professor of medicine at Harvard Medical School. “A vaccine given early in life could have an enormous protective effect.”
Other diseases for which mRNA vaccines are now in devel opment include Zika, yellow fever and tuberculosis. Therapeu tic mRNA vaccines designed to stimulate an immune response to cancer are also being explored in melanoma, prostate can cer, lung cancer and many other tumor types. Says Gandhi: “We’re on the threshold of a new revolution in vaccinology.” l



After 2020’s rapid shift to telemedicine, experts think as much as half of care could be delivered remotely
by Margaret Loftus©
AMY SHIDELER had barely put down roots in Northeast Ohio in fall 2020 when she tested positive for COVID-19. Her support system had yet to be built, and her parents, in Indiana, were recovering from the virus themselves. Beset by fa tigue and fever, she worried about being alone, especially since she had a history of asthma. “It was a very isolat ing feeling.”
But a home monitoring program at Cleveland Clinic, where Shideler is a social worker, made her feel less alone. Each day, she used the MyChart app on her smart phone to log her symptoms, temperature and oxygen level, which were then assessed by care coordinators at the clinic. Within 10 minutes of reporting shortness of breath one morning, she was called by a nurse and connected to a physician, who immediately prescribed a new inhaler. In all, the medical center’s virtual team evaluated her three times for symptoms that might otherwise have sent her to the emergency room. “It was comforting to know I was going to get what I needed right where I was,” she says.
Caring for patients where they are has long
been the promise of telemedicine, but it took unexpect ed and explosive demand in 2020 to make the promise real. Cleveland Clinic went from some 37,000 virtual visits in 2019 to 841,000 in 2021, peaking at 1.2 mil lion in 2020. Virtual care company Teladoc Health facilitated 10.6 million visits in 2020, a 156% increase over 2019; in 2021, that number climbed 38% to 15.8 million visits.
While demand has leveled off, experts predict that telemedicine – from doctor and psychotherapist visits to remote monitoring of chronic conditions – is here to stay. “Now that people have been exposed to it, it’s going to be a part of everything that we do,” says Dr. Steven Shook, a neurologist and lead for virtual health at Cleveland Clinic. Consulting firm McKinsey & Company estimated in 2020 that up to $250 billion of the U.S. health care industry has the potential to become virtual, up from a preCOVID revenue of $3 billion annually; providers estimate that as much as 50% of care could be delivered remotely.
AT CLEVELAND CLINIC, VIRTUAL VISITS SKYROCKETED FROM ABOUT 37,000 IN 2019 TO 1.2 MILLION IN 2020.
The extent to which the industry grows de pends largely on whether Congress makes per manent changes to rules that allowed for the expansion of telehealth services, such as more favorable reimbursement rates and permitting
remote care without geographic restrictions. At press time, sus taining expanded telehealth services had wide bipartisan sup port and strong backing from the Biden administration, but it’s the eventual fine print – for example, the rates at which various telehealth services are reimbursed compared to those in clinical settings – that will shape the future.

Home as clinic. To that end, a group of providers that in cludes Intermountain Healthcare, Ascension and Amazon Care formed a coalition in 2021 – called Moving Health Home – to advocate for policy changes that would designate the home as a site of clinical care. Members argue that advances in medi cal record-sharing, remote monitoring technologies and digital therapeutics have made it possible to deliver even acute care at home in many cases. Salt Lake City-based Intermountain, for example, treats patients at home who have everything from heart failure to certain cancers with a combination of technology and visits from an interdisciplinary caregiving team.
Consumers, for the most part, like the idea. McKinsey found that 40% of consumers will continue using virtual care, compared to 11% who used it pre-COVID.
To be sure, any visits that require hands-on evaluation, such
she’s seeing fewer patients remotely be cause UI Health is limiting such visits due to low reimbursement rates. Ide ally, though, she finds every other visit could be replaced. “Coming into a clinic every three months can be onerous, so a quick 20-minute call is no problem,” she says. Likewise, at the Medical University of South Carolina, diabetes patients are monitored through cellular-connected glucometers that beam data via a se cure cloud to a team of nurses who can adjust insulin.
The coronavirus itself became a case study for remote monitoring. UI Health partnered with the digital health care com pany physIQ to send COVID patients home fitted with a biosensor patch to collect data on heart and respiratory rates and arrhythmias, as well as move ment. The sensor, which is connected to an Android device, sent the data to a team of nurses who checked in with patients daily. Research ers were able to identify prelimi nary markers that preceded the decline of a patient’s condition.
“This kind of technology can and should be given to patients with lots of other chronic conditions,” says Dr. David Chestek, one of the investigators and interim chief medi cal information officer at UI Health.
Predictive value. Indeed, a study in 2020 by physIQ and four VA hospitals found that such analytics accurately pre dicted hospitalization for heart failure pa tients. And because these patients often have other health issues, it also predicted adverse events such as pneumonia and renal failure.
as orthopedics, are limited in their telehealth potential. But the possibilities in other domains are wide open: Mental health visits through Teladoc Health grew more than 500% in 2020 and more than doubled in 2021.
Another promising area: chronic diseases, which drive 80% of the health care costs in the U.S. Before COVID, Dr. Rachel Caskey, a physician at UI Health in Chicago, only rarely used telehealth. Last year, she managed many of her patients with chronic conditions remotely by, for example, having those with diabetes rely on a glucometer to keep track of their blood sugar and people with hypertension use a blood pressure cuff to take their own measurements. More recently, however, Caskey says
For all its technological promise, tele medicine has the potential to foster a more patient-centered health care sys tem, proponents argue. Consider that much of routine care has been delivered in 15-minute increments once a year, says Dr. James McElligott, medical director for the Center of Telehealth at MUSC. “It’s all about one point in time, but that’s not how health and wellness work.” McEl ligott thinks telehealth will provide the opportunity to check in more often with patients where they live, with more of a focus on their functioning and wellness. “A big page has turned,” he says. “I don’t think we can go back to where we were.”

Renewed efforts are underway to eliminate race from some aspects of patient care
by Steven Ross Johnson ©SEMINAL EVENTS dur ing the pandemic – such as the protests over the death of George Floyd at the hands of Minneapolis police in 2020 and the dis proportionate impact of COVID-19 on com munities of color – have brought the issues of systemic racism and injustice to the forefront.
For some health care providers, the mo ment has also presented an opportunity to leverage the national conversation into new efforts to examine how existing policies and practices in medicine may be perpetuating racial health inequities.
“We’re at a pivotal time,” says Dr. Nichola Davis, chief population health officer for NYC Health + Hospitals, New York City’s public hospital and health care system. “People’s ears are open and they are willing to hear and have these courageous conversations that they maybe weren’t able to have in 2019.”
Persistent disparities. At issue are clini cal algorithms that factor in race when as sessing a patient’s risk for a host of health conditions, ranging from death in connec tion with heart surgery to urinary tract in fections in children. Critics contend these calculations may result in patients of color
receiving less access to and poorer quality care than their white counterparts, fueling long-standing racial health disparities.
“Race was never necessary or needed” in these algorithms, says Dr. Milda Saun ders, an internal medicine physician, ethi cist, health equity researcher and associate professor of medicine at the University of Chicago. Race-based adjustments within al gorithms that help providers make clinical assessments have been around for decades. And while there is widespread acceptance that the concept of race is not based on bi ology but is instead a social construct, race correction continues to influence how pa tients are diagnosed and treated, despite the potential harms.
So ingrained are these calculations in clinical assessments that the effort to over haul them is often quite complicated, with questions over what factors can be an ad equate replacement.
“These are conversations that have been happening among certain subsets of people for years,” Davis says. “This isn’t new work for some people.”
There has been notable movement of late, however: In May 2021, for example, NYC Health + Hospitals announced its removal
of a patient’s race from calculations used to assess kidney function – part of the health system’s broader “Medical Era cism” initiative.
More recently, the American Academy of Pediatrics issued a policy statement promising to review and revise guide lines that factor race into clinical deci sion-making. The group said the practice is based on “flawed science” and stems from systemic and structural inequities that drive racial health disparities. “Rac ism has infiltrated and impacted health care delivery and outcomes in this coun try for more than 400 years,” states the policy, released in May 2022.
Race was first introduced in the late 1990s to calculate estimated glomerular filtration rate, or eGFR, which is com monly used by clinicians to measure the kidneys’ ability to filter waste from the blood. A higher eGFR score normally suggests better kidney function.
Black patients, though, are typically assigned a race adjustment that raises their eGFR by approximately 16% or more than non-Black patients, depend ing on the equation used. The adjust ment is tied to past findings showing higher levels of the waste product cre atinine among Black people.
“Explanations that have been given for this finding include the notion that Black people release more creatinine into their blood at baseline, in part because they are reportedly more muscular,” a 2020 article in the New England Journal of Medicine states. “Analyses have cast doubt on this claim, but the ‘race-corrected’ eGFR re mains the standard.”
A heavy toll. Davis says this adjust ment can negatively impact the quality of health care Black patients receive, causing delays in medical interventions such as referrals to a nephrologist or di alysis. One such potential consequence was outlined in a November 2021 piece published by STAT, in which Glenda V. Roberts – a woman with kidney disease who identified as Black – wrote of how the equation delayed her evaluation for a kidney transplant.
“Unfortunately, when you look at the clinical algorithms, what many of them do is they may downplay the severity of some illnesses when you do that race cor rection,” Davis says.
Recent steps to remove race from eGFR calculations were strengthened in September 2021 when the National Kid ney Foundation and American Society of Nephrology encouraged the use of a new equation that does not include race.
“The big change is that more institu tions like the hospital system, hospital leadership and administrators are more on board with efforts toward equity than they were in prior years,” says Dr. Monica Maalouf, associate director of the internal medicine residency pro gram for Loyola Medicine, a Chicago area health system.
Maalouf says Loyola is in the process of determining how to omit race as a variable from the health system’s eGFR calculations. This has involved talks with physicians and laboratory staff, as well as working with information technol ogy specialists on whether ra cial designation can be removed from the risk score’s automated reporting system.
National Kidney Foundation President Dr. Paul Palevsky says the new equation marks an im portant step toward achieving equity in health care by provid ing a more accurate, race-free approach to assessing kidney function.
“It was the most common equation used in medicine that incorporated race,” Palevsky says, estimating a race-inclusive equation for kidney function is used ap proximately 240 million times a year.
But while the change in the eGFR cal culation signifies a substantial step for ward, eliminating race correction in cal culations for other health conditions has been more challenging, despite growing recognition about the potential harms and health disparities that can come from their continued use.
“The field has realized that when we are using race as a factor in our clinical as sessments that we’re actually not using a precise measure like we would do for mea suring sex or age,” Saunders says. “But we want to find the best answer, so that may involve sort of reexamining the questions and not just saying, ‘Let’s just drop race,’ but asking what was race measuring, and then substituting that measure.”
Saunders says University of Chicago Medicine recently removed race in cal
As the global professional organization for the entire cardiovascular care team, the American College of Cardiology (ACC) is committed to supporting patients, caregivers, and health care professionals by ensuring the highest quality care is delivered to every patient, every time.
ACC Accreditation Services links performance improvement to patient outcomes and promotes consistent processes across the care continuum. Working with hospitals, centers and health systems, ACC Accreditation Services partners to build communities of excellence by advancing the highest standards of quality patient care.
For 25 years, the NCDR has delivered a suite of data registries to help hospitals, centers and health systems measure and improve the quality of cardiovascular care they provide. The NCDR utilizes real-world evidence to improve patient outcomes and achieve quality heart care.
MedAxiom, an ACC Company MedAxiom is the premier source for cardiovascular organizational performance solutions. MedAxiom unites the cardiovascular community via cutting-edge education, networking opportunities and best practices to transform cardiovascular care, together.



FOR CARDIOVASCULAR PROFESSIONALS, please visit CVQuality.ACC.org to learn more about ACC’s Quality Improvement for Institutions program. To learn more about cardiovascular organizational peformance solutions, visit MedAxiom.com.
FOR PATIENTS AND CAREGIVERS, please visit CardioSmart.org to learn more about ACC’s clinician-directed heart health education and resources.
The following pages list more than 2,000 hospitals, centers and health systems that rely on ACC’s NCDR and Accreditation Services. Patients and caregivers can trust hospitals and centers that participate in the NCDR, receive the ACC’s Accreditation seal of approval, and are recognized with the Chest Pain – MI Registry™ Performance Achievement Award and the HeartCARE Center™ Award for delivering the best cardiovascular patient care.
Incorporates evidence-based guidelines and clinical best practices to treat patients with atrial fibrillation.
CL Cardiac Cath Lab Accreditation
Merges the latest evidence-based science and process improvement methodologies, while addressing pre-procedure, periprocedure and post-procedure care for patients undergoing treatment in the Cath Lab.
CP Chest Pain Center Accreditation
Integrates triage treatment protocols, risk stratification, and best practices for the emergency care of acute coronary syndrome patients.
EP Electrophysiology Accreditation
Links the latest science, process improvement methodologies and patient outcomes across the care continuum for patients undergoing treatment in the EP Lab.
(Catheter-based atrial fibrillation ablation procedures) Assesses the prevalence, demographics, acute management and outcomes of patients undergoing atrial fibrillation (AFib) catheter ablation procedures.
C CathPCI Registry®
(Diagnostic cardiac catheterization and percutaneous coronary intervention) Measures adherence to the ACC/ AHA clinical practice guideline recommendations, procedure performance standards and appropriate use criteria for coronary revascularization.
CP Chest Pain — MI Registry™
(Acute myocardial infarction treatment)
Leverages national evidence-based standards for understanding and improving the quality, safety and outcomes of care provided for heart attack patients.
E EP Device Implant Registry™
(Implantable cardioverter defibrillator and pacemaker procedures) Provides a national standard for understanding patient characteristics, treatments, outcomes, device safety and the overall quality of care for ICD/CRT-D and select novel pacemaker procedures.
IM IMPACT Registry®
(Pediatric and adult congenital treatment procedures) Assesses the prevalence, demographics, management and outcomes of pediatric and adult congenital heart disease patients who undergo diagnostic catheterizations and catheterbased interventions.
L LAAO Registry™
(Left atrial appendage occlusion procedures) Captures data on left atrial appendage occlusion (LAAO) procedures to assess real-world procedural outcomes, short and long-term safety, and comparative effectiveness.
T STS/ACC TVT Registry™
(Transcatheter valve therapy procedures) Monitors real-world outcomes on transcatheter valve therapies leading to improved patient outcomes, enhanced assessment of treatment options and results, and more informed decision making.
Leverages guideline-directed medical therapies and best practices to ensure greater operational efficiency and a more consistent approach to treatment.
TV Transcatheter Valve Certification
Utilizes evidence-based science, realworld patient outcomes and expert recommendations to standardize and improve care for patients requiring transcatheter valve therapies.
Performance Achievement Award
Recognizes hospitals participating in Chest Pain – MI Registry that have demonstrated sustained, top level performance in quality of care and adherence to guideline recommendations.
Platinum Gold Silver HeartCARE Center™
Recognizes hospitals that have demonstrated a commitment to world-class cardiovascular care through comprehensive process improvement, disease and procedure-specific accreditation, professional excellence and community engagement.
Hospitals are listed by state and then by level of engagement with the ACC’s quality and process improvement programs.
Grandview Medical Center
Huntsville Hospital
Shelby Baptist Medical Center
University of Alabama Hospital
Ascension Providence
Health Care Authority for Baptist Health
Riverview Regional Medical Center
St. Vincent’s East
St. Vincent’s Hospital
Andalusia Regional Hospital
Brookwood Medical Center
Crestwood Medical Center
DCH Regional Medical Center
Mobile Infirmary Medical Center
North Alabama Medical Center
Princeton Baptist Medical Center
Southeast Health
Springhill Medical Center
Dekalb Regional Medical Center
East Alabama Medical Center
Flowers Hospital
Gadsden Regional Medical Center
Jackson Hospital and Clinic
Northeast Alabama Regional Medical Center
South Baldwin Regional Medical Center
Thomas Hospital
Vaughan Regional Medical Center
Baptist Medical Center South
Cullman Regional Medical Center
Marshall Medical Center
Russell Medical Center
Shoals Hospital
University of South Alabama Cardiology Department
Walker Baptist Medical Center
Alaska Regional Hospital
Providence Alaska Medical Center
Mat-Su Regional Medical Center
Alaska Native Medical Center
Central Peninsula Hospital
Fairbanks Memorial Hospital
ARIZONIA
Chandler Regional Medical Center
Abrazo Arizona Heart Hospital
Mercy Gilbert Medical Center
Havasu Regional Medical Center
Saint Joseph’s Hospital and Medical Center
Tucson Medical Center
Abrazo Arrowhead Campus
Carondelet St. Mary’s Hospital
Northwest Medical Center
Yavapai Regional Medical Center
Abrazo Central Campus
HonorHealth
Mayo Clinic Arizona
Mountain Vista Medical Center
Valley View Medical Center
Western Arizona Reg Medical Center
Yuma Regional Medical Center
Abrazo Scottsdale Campus
Abrazo West Campus
Banner - University Medical Center Tucson
Banner Boswell Medical Center
Banner Desert Medical Center
Banner Heart Hospital
Banner Thunderbird Medical Center
Banner University Medical Center - Phoenix
Canyon Vista Medical Center
Carondelet St. Joseph’s
Flagstaff Medical Center
Honor Health - Deer Valley Medical Center
HonorHealth John C. Lincoln Medical
Kingman Regional Medical Center
Oro Valley Hospital
Phoenix Children’s Hospital
Santa Cruz Valley Regional Hospital
Tempe St. Luke’s Hospital
Verde Valley Medical Center
CHI St. Vincent Infirmary
Mercy Health System of Northwestern Arkansas
National Park Medical Center
University of Arkansas Medical Sciences Physician
Arkansas Heart Hospital
Baptist Health - Fort Smith
Baptist Health Medical Center - Little Rock
Northwest Medical Center - Bentonville
Saline Memorial Hospital
Washington Regional Medical Center
Baptist Health Medical Center - North Little Rock
Baxter Regional Medical Center
CHI St. Vincent Hospital
Mercy Hospital Fort Smith
NEA Baptist Memorial Hospital
St. Bernards Medical Center
St. Mary’s Regional Medical
Unity Health White County
Medical Center
Baptist Memorial Hospital - Jonesboro
CHI St. Vincent North
Conway Regional Medical Center
Jefferson Regional Medical Center
Medical Center of South Arkansas, LLC
Northwest Medical Center - Springdale
Arkansas Children’s Hospital
Baptist Health Medical Center - Conway
Saint Mary’s Regional Medical Center
White River Medical Center
Adventist Health and
Rideout Hospital
Adventist Health
Bakersfield
Eisenhower Medical Center
University of California
Bakersfield Heart Hospital
California Pacific Medical Center
El Camino Health
French Hospital Medical Center
Palomar Medical Center
Sutter Medical Center
- Sacramento
Antelope Valley Hospital
Dignity Health St. Joseph’s Medical Center
Doctors Medical Center
Loma Linda University Medical Center
Memorial Medical Center
Modesto
NorthBay Medical Center
Pomona Valley Hospital Medical Center
Temecula Valley Hospital
UC San Diego Health System
Sulpizio CV Center
University Of California Davis Medical Center
Adventist Health
Alta Bates Summit Medical Center
Hoag Memorial Hospital
Presbyterian
Loma Linda University Medical Center -
Mercy General Hospital
Sacramento
Mills - Peninsula Medical Center
Riverside Community Hospital
Saint Agnes Medical Center
St. Bernardine Medical Center
Sutter Santa Rosa
Regional Hospital
Tri-City Medical Center
UC Irvine Health
University of California
San Francisco Medical Center
White Memorial Medical Center
Adventist Health St. Helena
Cedars - Sinai Health Systems
Community Memorial Hospital
Desert Regional Medical Center
Desert Valley Hospital
Emanate Health Medical Center
Fresno Heart and Surgical Hospital

Keck Medical Center of
Los Robles Hospital & Medical Center
Marian Regional Medical Center
MemorialCare Long Beach Medical Center
Salinas Valley Memorial Healthcare System
Sharp Memorial Hospital
St. John’s Regional Medical
Torrance Memorial Medical Center
Arrowhead Regional Medical Center
Bakersfield Memorial Hospital
Community Hospital of the Monterey Peninsula
Emanuel Medical Center
Enloe Medical Center
Fresno Community Hospital
Medical Center
Garfield Medical Center
Good Samaritan Hospital
Huntington Hospital
John Muir Medical Center
- Concord Campus
Kaiser Foundation Hospital
Kaiser Permanente Medical Center
- San Francisco
Kaiser Permanente Medical Center
- Santa Clara
Kaweah Delta Hospital District
Marin Health Medical Center
Memorialcare Saddleback Medical Center
Northridge Hospital Medical Center
PIH Health Good Samaritan Hospital
Providence Little Company of Mary Medical Center
Providence Mission Hospital
Providence Saint John’s Health Center
Providence St. Joseph Hospital
Santa Barbara Cottage Hospital
Santa Rosa Memorial Hospital
Scripps Memorial Hospital
Scripps Mercy Hospital -
Sequoia Hospital
Sharp Chula Vista Medical Center
Sharp Grossmont Hospital
Stanford Health Care
Stanford Health Care Valley Care
Sutter Delta Medical Center
Washington Hospital
West Hills Hospital & Medical Center
Children’s Hospital of Los Angeles
Community Medical Center -

Corona Regional Medical Center
Dignity Health Dominican Hospital
Glendale Memorial Hospital and Health Center
Henry Mayo Newhall Hospital
Kaiser Foundation Hospital
Kaiser Permanente Irvine Medical Center
Kaiser Permanente Oakland Medical Center
Lakewood Regional Medical Center
Lucile S. Packard Children’s Hospital at Stanford University
MemorialCare Orange Coast Medical Center
Palmdale Regional Medical Center
PIH Health Hospital - Whittier
Providence Saint Joseph Medical Center
Providence St. Jude Medical Center
Providence St. Mary Medical Center
Riverside University Health System Medical Center
San Antonio Regional Hospital
Shasta Regional Medical Center
Southern California Hospital at Culver City
Sutter Roseville Medical Center
University Of California - Santa Monica
Valley Presbyterian Hospital
West Anaheim Medical Center
Adventist Medical Center -
Adventist Health - Simi Valley
Adventist Health Simi Valley
Alameda Health System
Barstow Community Hospital
California Hospital Medical Center
Children’s Hospital of Orange County
Chino Valley Medical Center
Corona Regional Medical Center
Dameron Hospital Association
Dignity Health
Dignity Health Mercy Medical Center
El Centro Regional Medical Center
Fountain Valley Regional Hospital
Hollywood Presbyterian Hospital
John F. Kennedy Memorial Hospital
John Muir Medical Center - Walnut Creek Campus
Kaiser Foundation - Roseville Medical Center
Kaiser Foundation Hospital South Sacramento
Kaiser Permanente - Vallejo Medical Center
Kaiser Permanente Fremont Medical Center
Kaiser Permanente Medical Center Health Sciences
Kaiser Permanente Modesto Medical Center
Kaiser Permanente Orange County - Anaheim Medical Center
Kaiser Permanente Sacramento Medical Center
Kaiser Permanente San Rafael Medical Center
Kaiser Permanente Walnut Creek
Kaiser Redwood City Medical Center
Los Alamitos Medical Center
Marshall Medical Center
Mercy Medical Center Merced
Methodist Hospital of South CA
Oroville Hospital
PIH Health Hospital - Downey
Pioneers Memorial Healthcare District
Pioneers Memorial Hospital
Placentia Linda Hospital
Providence Holy Cross Medical Center
Providence Tarzana Medical Center
Queen of the Valley Medical Center
Rady Children’s Hospital - San Diego
Rancho Spring Medical Center
Regional Medical Center - San Jose
Ridgecrest Regional Hospital
San Joaquin General Hospital
San Ramon Regional Medical Center
Santa Clara Valley Health and Hospital System
Santa Teresa Community Hospital
Sherman Oaks Hospital
Sierra View District Hospital
St. Joseph Hospital
St. Mary Medical Center
St. Mary’s Medical Center
St. Rose Hospital
Sutter Amador Surgery Center
Sutter Solano Medical Center
UCSF Benioff Children’s Hospitals,
USC Verdugo Hills Hospital
Valley Children’s Hospital
COLORADO
Medical Center of Aurora
UCH - Memorial Hospital
Rose Medical Center
National Jewish/ SCL Saint Joseph Hospital
Medical Center of the Rockies
Porter Adventist Hospital
Saint Mary’s Hospital and Regional Medical Center
St. Anthony Hospital
University of Colorado Hospital Authority
Valley View Hospital
Lutheran Medical Center
North Colorado Medical Center
Parkview Medical Center
Penrose Hospital
Boulder Community Health
Parker Adventist Hospital
Platte Valley Medical Center
SCL Health Good Samaritan Medical Center
Swedish Medical Center
Castle Rock Adventist
Highlands Ranch Hospital
Littleton Adventist Hospital
Mercy Regional Medical Center
Sky Ridge Medical Center
St. Anthony North Health
St. Francis Medical Center
Avista Adventist Hospital
Community Hospital
Longmont United Hospital
McKee Medical Center
Poudre Valley Hospital
Yale
Christiana
Bayhealth
The George Washington
AdventHealth
AdventHealth
Wesley
St. Joseph’s
AdventHealth
AdventHealth
Joseph’s
City..............
Baptist Hospital of Miami,
Bayfront Health
Saint Petersburg
HCA Florida Osceola Hospital..
Morton Plant Hospital...............
Mount Sinai Medical Center....
Physicians Regional HS
Pine Ridge..................................
Sarasota Memorial Hospital.....
UF Health
AdventHealth
AdventHealth
Ascension
Baptist
Broward
River
HCA Florida JFK Medical Hospital
HCA Florida Memorial
HCA Florida North Florida Hospital
HCA Florida West
Holy Cross Hospital........................
Jackson Memorial Hospital...........
Lakeland Regional Medical Center
Lee Health - HealthPark Medical Center
Naples Community Hospital
UF Health Shands
University of Miami Hospital and Clinics
Winter Haven Hospital...................
AdventHealth
AdventHealth
Ascension Sacred Heart
Ascension Sacred Heart
Cleveland Clinic
Cleveland Clinic
HCA
HCA
HCA
Orlando Health.....................................
ShorePoint
South Miami Hospital..........................
Tallahassee Memorial
Tampa General Hospital......................
Health
Wellington Regional
AdventHealth
Baptist Hospital..........................................
Bethesda Hospital,
Baptist Health South
Boca Raton Regional Hospital.................
Bravera
Delray Medical Center..............................
HCA Florida Bayonet Point Hospital......
HCA Florida Blake Hospital
HCA Florida Brandon Hospital................
HCA Florida Citrus Hospital.....................
HCA Florida Fawcett Hospital.................
HCA Florida Kendall Hospital..................
HCA Florida Lawnwood Hospital...........
HCA Florida Mercy Hospital....................
HCA Florida Ocala Hospital.....................
HCA Florida Westside Hospital..............
Holmes Regional Medical Center...........
Lakewood Ranch Medical Center............
Mayo Clinic..................................................
North Okaloosa Medical Center..............
Palm Beach Gardens Medical Center....
Palmetto General Hospital.......................
Rockledge Regional Medical Center.....
The Villages Regional Hospital................
Venice Regional Bayfront Health............
Advent Health New Smyrna Beach..............
AdventHealth Altamonte Springs...............
AdventHealth Apopka...................................
AdventHealth Deland.....................................
AdventHealth East Orlando..........................
AdventHealth Fish Memorial........................
AdventHealth Heart of Florida.....................
Ascension Sacred Heart on the Emerald Coast
Ascension St. Vincent’s Clay County...........
Ascension St.
HCA Florida Oak Hill
Jackson North
Jackson South
Lee Health
Lower Keys
Mease Countryside
Morton Plant
North Broward
Oviedo
Parrish
Physicians
Sebastian River
South Florida
South Miami
St.
St. Cloud
St.
St.
Wolfson
AdventHealth
Bayfront
Cape
Cleveland
Dr.
Good
HCA Florida Englewood
HCA Florida Highlands
HCA Florida Palms
HCA Florida Pasadena Hospital
HCA Florida Poinciana Hospital.........................
HCA Florida Putnam Hospital............................
HCA Florida Sarasota Doctors Hospital...........
HCA Florida South Shore Hospital....................
HCA Florida South Tampa Hospital..................
HCA Florida St. Lucie Hospital...........................
HCA Florida Trinity Hospital...............................
Heart and Rhythm



Jackson West Medical
Joe DiMaggio
Johns Hopkins
Children’s
Melbourne Regional Medical Center...............
Memorial Hospital
South Broward Hospital
Memorial Regional Hospital................................
Miami Children’s Health
Nemours Children’s Hospital.............................
North Shore Medical
Ocala

Palm Bay Hospital..................................................
Physicians Regional Medical Center
Santa
Sarasota
South Miami


AU Medical
Piedmont
St. Joseph’s
Hamilton Medical
Medical Center
Memorial Health
Medical Center
Saint Francis - Emory
Piedmont Henry Hospital....................
Piedmont Hospital................................
Piedmont Newnan Hospital................
Wellstar Kennestone Regional Medical Center
Emory Saint Joseph’s Hospital
Atlanta
Emory University Hospital........................
Emory University Hospital Midtown......
Floyd Medical Center.................................
Northeast Georgia Health System
Northside Hospital - Gwinnett
Southern Regional Medical Center.........
Atlanta Medical Center..................................
Cartersville Medical Center...........................
Children’s Healthcare of Atlanta..................
Coliseum Medical Centers............................
East Georgia Regional Medical Center......
Eastside Medical Center................................
Grady Health System......................................
Houston Medical Center...............................
Memorial Satilla Health..................................
Piedmont Rockdale
Southeast Georgia Health

Spalding
Tanner Medical
Tanner Medical
Tift Regional Medical
Union General Hospital...................................
Wellstar Cobb Hospital..................................
WellStar North Fulton Hospital
Wellstar Paulding Hospital............................
WellStar West Georgia Medical Center.....
Adventist Health System
AdventHealth


Atlanta Medical Center

Coffee Regional Medical Center
Doctors Hospital - Augusta
East Georgia Regional Medical Center
Emory Decatur Hospital
Emory Johns Creek Hospital
Fairview Park Hospital
John D. Archbold Memorial Hospital
Meadows Regional Medical Center
Northeast Georgia Medical Center
Northside Hospital - Atlanta
Northside Hospital - Cherokee
Northside Hospital - Forsyth
Piedmont Columbus Regional
Piedmont Mountainside Hospital
Piedmont Walton Hospital
Polk Medical Center
Upson Regional Medical Center
Wellstar Douglas Hospital
Straub Medical Center
The Queen’s Medical Center
Pali Momi Medical Center
Hilo Medical Center
Kaiser Permanente
Medical Center
Maui Memorial Medical Center
North Hawaii Community Hospital
Saint Alphonsus Regional Medical Center
Portneuf Medical Center
St. Alphonsus Medical Center - Nampa
St. Luke’s
Eastern Idaho Regional Medical Center
Kootenai Health
St. Joseph Regional Medical Center
HCA - West Valley Medical
Idaho Falls Community Hospital
St. Luke’s Magic Valley Regional Medical Center
OSF HealthCare
Medical Center
Riverside Health Care
Loyola University Medical Center
Edward Hospital
Memorial Hospital Carbondale
OSF Saint Anthony Medical Center
Rush - Copley Hospital
AMITA Health Adventist
Medical Center Hinsdale
Northwestern Medicine McHenry Hospital
Springfield Memorial Hospital
Trinity Medical Center - Rock Island
University of Chicago Medical Center
AMITA Health Adventist Medical Center La Grange
AMITA Health Alexian Brothers Medical Center
AMITA Health Resurrection Medical Center Chicago
AMITA Health Saint Joseph Medical Center
Blessing Hospital
Carle BroMenn Medical Center
Highland Park Hospital
HSHS St. Elizabeth’s Hospital
NorthShore University Health System
Northwest
Hospital
OSF HealthCare Heart of Mary Medical Center
OSF Saint Joseph Medical Center
Protestant Memorial Medical Center
Rush University Medical Center
University of Illinois Medical Center at Chicago
Advocate Christ Medical Center
Advocate Good Samaritan Hospital
Advocate Illinois Masonic Medical Center
Advocate Lutheran General Hospital
Advocate Sherman Hospital
AMITA Health Adventist Medical Center GlenOaks
AMITA Health Mercy Medical Center
AMITA Health St. Mary’s Hospital
Carle Foundation Hospital
Elmhurst Memorial Healthcare
Good Samaritan Hospital
MacNeal Hospital
Memorial Hospital Shiloh
Northwestern Central DuPage Hospital
Northwestern Lake Forest Hospital
Northwestern Medicine Huntley Hospital
Northwestern Memorial Hospital
Palos Health
Prairie Heart Institute at St. John’s Hospital
Rush Oak Park Hospital
Silver Cross Hospital
UnityPoint Health Methodist
UnityPoint Health Methodist
West Suburban Medical Center
Advocate Condell Medical Center
Advocate Good Shepherd Hospital
AMITA Health Adventist Medical Center Bolingbrook
AMITA Health Saint Francis Hospital of Evanston
AMITA Health Saint Joseph Hospital
Chicago
AMITA Health Saint Joseph Hospital
AMITA Health Saints Mary and Elizabeth Medical Center
AMITA Health St. Alexius Medical Center
Anderson Hospital
Franciscan Health Olympia Fields
Genesis Medical Center, Silvis
Gottlieb Memorial Hospital
Heartland Regional Medical Center
Mercyhealth Javon Bea Hospital
Mount Sinai Hospital
Sarah Bush Lincoln Health Center
Advocate Children’s Hospital Oak
Advocate South Suburban Hospital
Advocate Trinity Hospital
Alton Memorial Hospital
FHN Memorial Hospital
Gateway Regional Medical Center
Glenbrook Hospital
Humboldt Park Health
Jersey Community Hospital District
John H. Stroger Jr Hospital of Cook County Hospital
Katherine Shaw Bethea Hospital
Lurie Children’s Hospital of Chicago
Northwestern Delnor Hospital
Northwestern Medicine Kishwaukee Hospital
Red Bud Regional Hospital
SSM Health Good Samaritan Hospital
- MT Vernon
St. Mary’s Hospital
Swedish Covenant Hospital
Vista Medical Center
INDIANA
Lutheran Hospital of Indiana
Indiana University Health Methodist Hospital
Parkview Heart Institute
Columbus Regional Hospital
Northwest Health
Deaconess Gateway Heart Hospital
Franciscan Health
Indiana University Health Arnett Hospital
Indiana University Health
Ball Memorial Hospital
Indiana University Health Bloomington
Ascension St. Vincent Evansville
Northwest Health
Saint Joseph Health System
Union Hospital
Ascension St. Vincent Heart Center
Ascension St. Vincent Hospital
Clark Memorial Hospital
Community Hospital
Deaconess Hospital
Elkhart General Hospital
Goshen Hospital
Indiana University Health North Hospital
Indiana University Health
Saxony Hospital
Indiana University Health West Hospital
Reid Health
Community Heart and Vascular Hospital

Dupont Hospital
Franciscan Health Crown
Franciscan Health Lafayette East
Kosciusko Community Hospital
Marion General Hospital
Memorial Hospital of South Bend
Methodist Hospital Southlake Campus
St. Mary Medical Center
Baptist Health Floyd
Franciscan Health Dyer
Franciscan Health Michigan City
Health and Hospital Corporation of Marion County
Hendricks Regional Health
Methodist Hospital Northlake Campus
Pinnacle Healthcare, LLC
St. Catherine Hospital
Community Hospital Anderson
Community Hospital East
Community Hospital South
Community Howard Regional Health
Franciscan Health - Hammond
Franciscan Health - Munster
Good Samaritan Heart Center
Hancock Memorial Hospital
Lutheran Downtown Hospital
Memorial Hospital and Health Care Center
Riley Hospital for Children
Indiana University Health
Riverview Health
Scott Memorial Hospital
St. Elizabeth
Terre Haute Regional Hospital
Union Hospital Clinton
Witham Health System
Woodlawn Hospital
St. Luke’s Hospital
Allen Memorial Hospital
MercyOne North Iowa
MercyOne Siouxland Medical Center
Genesis Medical Center, Davenport
Iowa Methodist Medical Center
Mercy Iowa City
MercyOne Des Moines Medical Center
MercyOne Waterloo Medical Center
University of Iowa Hospitals and Clinics
The Finley Hospital
Trinity Medical Center - Bettendorf
Trinity Regional Medical Center
UnityPoint Health, St Luke’s Sioux City
Iowa Lutheran Hospital
MercyOne Dubuque Medical Center
Ottumwa Regional Health Center
CHI Health Mercy
Mercy Medical Center
MercyOne Clinton Medical Center
Advent Health
Shawnee Mission
Hays Medical Center
The University of Kansas Health System
Overland Park Regional Medical Center
Salina Regional Health Center
Stormont Vail Health
Olathe Medical Center
Providence Medical Center
University of KansasHealth System St. Francis Campus
Ascension Via Christi Hospitals in Wichita
Wesley Medical Center
Western Plains Medical Center
AdventHealth South Overland Park
Ascension Via Christi Hospital at Manhattan
Menorah Medical Center
Newman Regional Health
St. Catherine Hospital
St. Luke’s South Hospital
Via Christi Hospital -
Kansas Medical Center
Lawrence Memorial Hospital
Wesley Woodlawn Hospital
William Newton
Baptist Health Lexington
Baptist Health Paducah
Kings Daughters Medical Center
Jewish Hospital
Norton Audubon
Pikeville Medical Center
St. Joseph Hospital
Baptist Health Louisville
Saint Elizabeth Healthcare
Edgewood
Ephraim McDowell Regional
Medical Center
Medical Center at Bowling Green
Norton Hospital
Baptist Health Corbin
Mercy Health Lourdes Hospital
Saint Joseph East
Baptist Health Hardin
Harrison Memorial Hospital
Highlands ARH Regional Medical Center
Lake Cumberland Regional Hospital
Meadowview Regional Medical Center
Norton Brownsboro Hospital
Owensboro Health Regional Hospital
Saint Joseph London
St. Claire Regional Medical Center
T. J. Samson Community Hospital
Baptist Health Deaconess
Madisonville, Inc

Clark Regional Medical Center
Frankfort Regional Medical Center
Georgetown Community Hospital
Greenview Regional Hospital
Hazard ARH Regional Medical Center
Jackson Purchase Medical Center
Baptist Health Richmond
Bluegrass Community Hospital
Bourbon Community Hospital
CHI Saint Joseph Health System, St. Joseph Berea
Clark Regional Medical Center
Fleming County Hospital
Logan Memorial Hospital
Murray Calloway County Hospital
Norton Children’s Hospital
Norton Women’s & Children’s Hospital
Spring View Hospital
St. Mary & Elizabeth Hospital
Three Rivers Medical Center
University of Louisville Hospital
CHRISTUS St. Patrick Hospital
CHRISTUS St. Frances Cabrini Hospital
Ochsner Clinic Foundation
St. Tammany Health System
CHRISTUS Shreveport Bossier Health System
Ochsner - LSU Health Shreveport
Our Lady of The Lake Regional Medical Center
St. Francis Medical Center
Willis Knighton Medical Center
East Jefferson General Hospital
Ochsner Lafayette General Medical Center
Our Lady of Lourdes Heart Hospital
Terrebonne General Health System
Tulane University Hospital and
Lakeview Regional Medical Center, A Campus of Tulane
Ochsner - LSU Health
Shreveport Monroe Medical
Rapides Regional Medical Center
Baton Rouge General Medical
Glenwood Regional Medical Center
Lake Charles Memorial Hospital
North Oaks Medical Center
Our Lady of Lourdes Regional Medical Center
Touro Infirmary Medical Center
University Medical Center
Acadian Medical Center
Beauregard Memorial Hospital
Children’s Hospital of New Orleans
Cypress Pointe Surgical Hospital
Lane Regional Medical Center
Mercy Regional Medical Center
Minden Medical Center
Ochsner Baptist Medical Center
Ochsner Medical Center
Ochsner Medical Center
Ochsner Medical Center
Slidell Memorial Hospital and Medical Center
St. Bernard Parish Hospital
St. Charles Parish Hospital
West Calcasieu Cameron Hospital
West Jefferson Medical Center
Willis Knighton Bossier
Willis Knighton Pierremont
Maine Medical Center
Central Maine Medical Center
Eastern Maine Medical Center
York Hospital
Adventist Healthcare White Oak Medical Center
Johns Hopkins Hospital
Luminis Health Anne Arundel Medical Center
University of Maryland Medical Center Cardiology
UPMC Western Maryland
Adventist HealthCare Shady Grove Medical Center
MedStar Union Memorial Hospital
MedStar Southern Maryland Hospital Center
Sinai Hospital of Baltimore
Suburban Hospital
TidalHealth Peninsula Regional, Inc.
University of Maryland Saint Joseph Medical Center
Frederick Health Hospital
Holy Cross Hospital
Spring,
Howard County General Hospital
MedStar Franklin Square Medical Center
Carroll Hospital Center
Holy Cross Germantown Hospital
Johns Hopkins Bayview Medical Center
Meritus Medical Center
Saint Agnes Hospital
UM Baltimore Washington Medical Center
UM Upper Chesapeake Medical Center, Inc
University of Maryland Capital Region Medical Center
University of Maryland Shore
Regional Health
Walter Reed National Military Medical Center
Lahey Hospital and Medical Center
Lawrence General Hospital
Baystate Medical Center
Brigham & Women’s Hospital
Cape Cod Hospital
Massachusetts General Hospital
Mount Auburn Hospital
Saint Vincent Hospital
Tufts Medical Center
UMASS Memorial Medical Center
Beth Israel Deaconess Medical Center
Boston Medical Center
Charlton Memorial Hospital
Lowell General Hospital
Mercy Hospital
St. Elizabeth’s Medical Center
Anna Jaques Hospital
Berkshire Medical Center, Inc
Milford Regional Medical Center
Beth Israel Deaconess Hospital Heart Plymouth, Inc.
Beverly Hospital
Boston Children’s Hospital
Caritas Holy Family Hospital
Cooley Dickinson Hospital
Good Samaritan Medical Center
Melrose - Wakefield Hospital
MetroWest Medical Center
North Shore Medical Center-
Saint Anne’s Hospital
Signature Healthcare Brockton Hospital
South Shore Health System
UMass Memorial Medical Center
Spectrum Health
UP Health System
Heart Marquette
Edward W. Sparrow
Hospital Assoc
Mercy Health
MidMichigan Medical Center
Heart Midland
St. Joseph Mercy Oakland
Trinity Health St. Joseph Mercy
Ann Arbor
Ascension Genesys Hospital
Ascension Health
Ascension Providence Hospital
Southfield
Ascension St. John Hospital
Borgess Medical Center
Henry Ford Macomb Hospital
Lakeland HealthCare
McLaren Bay Region
McLaren Flint
McLaren Greater Lansing
McLaren Macomb
McLaren Northern Michigan
Michigan Medicine
Spectrum Health
Butterworth Hospital
Beaumont Hospital, Dearborn
Beaumont Hospital, Royal Oak
Bronson Methodist Hospital
Covenant Healthcare
Harper University Hospital
Henry Ford Health
Henry Ford Jackson Hospital
Holland Hospital
McLaren Port Huron Hospital
Munson Medical Center
Ascension Macomb - Oakland Hospital
Ascension Providence Hospital Novi
Ascension Providence Rochester Hospital
Beaumont Hospital, Troy
Garden City Hospital
McLaren Oakland
Mercy Health Saint Mary’s
Saint Mary Mercy Hospital
Beaumont Hospital, Farmington Hills
Beaumont Hospital, Grosse Pointe
Beaumont Hospital, Trenton
Beaumont Hospital, Wayne
DMC Sinai - Grace Hospital
Henry Ford Health System West Bloomfield
Henry Ford Wyandotte Hospital
Hurley Medical Center
Huron Valley Sinai Hospital
Lake Huron Medical Center
McLaren Central Michigan
McLaren Thumb Region
Monroe Regional Hospital
Promedica Monroe Regional Hospital
University of Michigan Health - West
UP Health System - Bell Hospital
UP Health System - Portage
Wayne State University
Heart Children’s Hospital
CentraCare Heart & Vascular Center
Essentia Health - St. Mary’s Medical Center
University of Minnesota Health, Heart Care - Minneapolis
Allina Health Minneapolis
Heart Institute - Minneapolis
Allina Health Minneapolis
Heart Institute - Saint
Mayo Clinic Hospital
Saint Mary’s Campus
Mercy Hospital part
North Memorial Health
St. Joseph’s Hospital
St. Luke’s Hospital
University of Minnesota Health, Heart Care - Edina
Park Nicollet Methodist Hospital
Regions Hospital
Sanford Bemidji Medical Center
Essentia Health - St. Joseph’s
Hennepin County Medical Center
Children’s Minnesota
Mayo Clinic Health System
Ridgeview Medical Center
St. John’s Hospital
University of Minnesota Health, Heart Care - Burnsville
Baptist Memorial Hospital
- Desoto
Mississippi Baptist Medical Center
Baptist Memorial Hospital
- Golden Triangle
Merit Health Wesley Medical Center
Forrest General Hospital
Baptist Memorial Hospital
North Mississippi
North Mississippi Medical Center
Ocean Springs Hospital
St. Dominic - Jackson Memorial Hospital
University of Mississippi Medical Center
Magnolia Regional Health Center
Southwest MS Regional Medical Center
Anderson Regional Medical Center
Memorial Health System
Merit Health River Region
Methodist Healthcare
- Olive Branch Hospital
Pascagoula Hospital
Baptist Memorial Hospital
- North Mississippi
Delta Regional Medical Center
Merit Health System
River Oaks Hospital
Rush Foundation Hospital
Singing River Gulfport
Bolivar Medical Center
Merit Health - Biloxi
Merit Health Natchez
Barnes Jewish Hospital/ Washington University
Heartland Regional Medical Center
Research Medical Center
North Kansas City Hospital
Saint Francis Medical Center
Centerpoint Medical Center
Freeman Health System
Liberty Hospital
Mercy Hospital Joplin
Mercy Hospital Springfield
Mercy Hospital St. Louis
Poplar Bluff Regional Medical Center
Saint Luke’s Hospital of Kansas City
Southeast Missouri Hospital
University of Missouri Hospital and Clinics
Boone Hospital Center
Christian Hospital BJC Healthcare
Cox Medical Center Branson
Cox Medical Center South
Mercy Hospital South
SSM Health Saint Louis University Hospital
St. Luke’s Hospital
Carondelet Heart Institute at St. Joseph Medical Center

Hannibal Regional Hospital
Lee’s Summit Medical Center
Missouri Baptist Medical Center
SSM Health DePaul Hospital - St. Louis
St. Mary’s Medical Center
Truman Medical Centers
Capital Region Medical Center
Children’s Mercy Kansas City
Citizens Memorial Hospital
Mercy Hospital Jefferson
Mercy Hospital Washington East Community
Northeast Regional Medical Center
Saint Luke’s East Hospital
Saint Luke’s Northland Hospital
SSM Health - St Marys Hospital Jefferson City
SSM Health St. Clare Hospital -
SSM Health St. Mary’s Hospital -
Moberly Regional Medical Center
Ozarks Healthcare
Phelps County Regional Medical Center
Progress West Healthcare
SSM Cardinal Glennon Children’s Medical
St. Louis Children’s Hospital
Billings Clinic
St. Vincent Healthcare
Logan Health
Community Medical Center
Providence St. Patrick Hospital
Bozeman Health
St. James Health Care
Benefis Hospitals
Bryan Medical Center
Nebraska Medicine
CHI Health CUMC - Bergan Mercy
CHI Health Nebraska Heart
Faith Regional Health Services
Kearney Regional Medical Center
Nebraska Methodist Hospital
Bellevue Medical Center
Great Plains Health
Mary Lanning Healthcare
CHI Health Good Samaritan
CHI Health Immanuel
CHI Health Lakeside
CHI Health St. Francis
Children’s Hospital and Medical Center
Saint Mary’s Regional Medical Center
Renown Regional Medical Center
University Medical Center of Southern Nevada
Dignity Health St. Rose Dominican Siena
MountainView Hospital
Dignity Health St. Rose Dominican
San Martin
North Vista Hospital
Northeastern Nevada
Regional Hospital
Sunrise Hospital and Medical Center
Desert Springs Hospital
Northern Nevada Medical Center
Spring Valley Hospital
Carson Tahoe Regional Medical Center
Centennial Hills Hospital Medical Center
Henderson Hospital
Renown South Meadows Medical Center
Southern Hills Hospital
Louis
SSM St. Joseph Hospital - St. Charles
SSM St. Joseph Hospital West
St. Luke’s
Peres Hospital
Barnes Jewish St. Peters Hospital
Belton Regional Medical Center
Bothwell Regional Health Center
Heart Care Center, LLC

Lake
System
Summerlin Hospital Medical Center
Valley Hospital Medical Center
Catholic Medical Center
Portsmouth Regional Hospital
Concord Hospital
Dartmouth Hitchcock Medical Center
Exeter Hospital
Parkland Medical Center
Southern New Hampshire Medical
St. Joseph Hospital
Elliot Hospital
Wentworth - Douglass
Jersey Shore University Medical Center
JFK Medical Center
Englewood Health
Hackensack Meridian Health Network
Ocean Medical Center
Riverview Medical Center
Cooper University Health System
Deborah Heart & Lung Center
Morristown Medical Center
Newark Beth Israel Medical Center
St. Francis Medical Center
The Valley Hospital
AtlantiCare Regional Medical Center
Bayshore Community Hospital
Cooperman Barnabas Medical Center, Inc.
Robert Wood Johnson University Hospital
Southern Ocean Medical Center
Virtua Our Lady of Lourdes
Capital Health Medical Center - Hopewell
St. Joseph’s Health
University Hospital
Clara Maass Medical Center
Inspira Medical Center -
Inspira Medical Center
Jersey City Medical Center
Raritan Bay Medical Center
St. Michael’s Medical Center
Bayonne Medical Center
Centrastate Medical Center
CentraState Medical Center
Chilton Medical Center
Christ Hospital
Community Medical Center
Hackettstown Medical Center
Holy Name Medical Center
Hunterdon Healthcare System
Jefferson Washington Township Hospital
Monmouth Medical Center
Mountainside Medical Center
Newton Medical Center
Overlook Medical Center
Princeton Medical Center
Robert Wood Johnson University Hospital
- Hamilton
Robert Wood Johnson University Hospital - Rahway
Robert Wood Johnson University Hospital - Somerset
Saint Clare’s Hospital
Saint Peter’s University Hospital
Shore Medical Center
St. Luke’s Warren Campus
St. Mary’s General Hospital
Trinitas Regional Medical Center
Virtua Health Inc.
Virtua Memorial Hospital
Virtua Our Lady of Lourdes
Presbyterian Healthcare Services
San Juan Regional Medical Center
Lovelace Medical Center
Memorial Medical Center
Mountain View Regional Medical Center
University of New Mexico Hospital
Carlsbad Medical Center
Eastern New Mexico Medical Center
Gerald Champion Regional Medical
Christus St. Vincent Regional Medical
Los Alamos Medical Center
NEW YORK
UR Medicine Strong Memorial Hospital
St. Elizabeth Medical Center
The Mount Sinai Medical Center
Bellevue Hospital Center
Mount Sinai St. Luke’s
New York Presbyterian - Queens
St. Joseph’s Hospital
Stony Brook University Hospital
Westchester County Health Care Corp
New York Presbyterian - Weill Cornell Medical Center
St. Peter’s Hospital
Vassar Brothers Medical
Albany Medical Center Hospital
Bassett Medical Center
Good Samaritan Hospital
Good Samaritan Hospital Medical Center
Jamaica Hospital Medical
Mercy Hospital of Buffalo
Montefiore Medical Center
New York Presbyterian
- Brooklyn Methodist Hospital
New York Presbyterian
- Columbia University Irving
NYU Langone Health - Tisch Hospital
St. Francis Hospital and Heart Center
Upstate Medical University
Arnot Ogden Medical Center
Bronx Care Health System
Cayuga Medical Center at Ithaca
Ellis Hospital
Gates Vascular Institute
Maimonides Medical Center Division of Cardiology
New York Presbyterian
- Lawrence Hospital
Northwell Health Lenox Hill Hospital
Northwell Health North Shore
University Hospital
Northwell Health Southside Hospital
Northwell Health Staten Island Hospital
NYU Langone Hospital - Long Island
Richmond University Medical Center
Rochester Regional Health System
UPMC Chautauqua
Wyckoff Heights Medical Center
Cohen Children’s Medical Center
Garnet Health
Glens Falls Hospital
Montefiore St Lukes’s Cornwall
Mount Sinai Beth Israel
Mount Sinai South Nassau Hospital
New York Presbyterian - Hudson Valley Hospital
Northwell Health Long Island
Jewish Hospital
Olean General Hospital
Stony Brook Southampton Hospital
The Brooklyn Hospital Center
United Health Services Hospitals/ Wilson Regional
Brookdale Hospital & Medical Center
Crouse Hospital
HealthAlliance Hospital - Broadway Campus
Jacobi Medical Center
John T. Mather Hospital
Long Island Community Hospital
Montefiore Nyack Hospital
New York Presbyterian
- Morgan Stanley Children’s
Niagara Falls Memorial Medical Center
Northern Westchester Hospital
Northwell Health Huntington Hospital
NYU Langone Hospital - Brooklyn
Peconic Bay Medical Center
Rochester Regional Health
Samaritan Hospital
Saratoga Hospital
SBH Health System
St. Catherine of Siena
UVM Health Network
White Plains Hospital
CarolinaEast
Medical Center
New Hanover Regional Medical Center
UNC Medical Center
Frye Regional Medical Center
Duke University Hospital
Atrium Health’s Carolinas Medical Center
Cape Fear Valley Health System
Moses H. Cone
Memorial Hospital
Novant Health Forsyth Medical Center
Novant Health Presbyterian Medical Center
Rex Hospital
Wake Forest Baptist Health
WakeMed Raleigh Campus
Atrium Health Cabarrus
CaroMont Regional Medical Center
UNC Health Southeastern
Vidant Medical Center
Alamance Regional Medical Center
Atrium Health Wake Forest Baptist High Point
Duke Raleigh Hospital
Duke Regional Hospital
Haywood Regional Medical Center
Nash UNC Healthcare
Sentara Albemarle Medical Center
WakeMed Cary Hospital
Atrium Health Pineville
Catawba Valley Medical Center
Central Carolina LifePoint Health

FirstHealth Moore Regional Hospital
Johnston UNC Health Care
Mission Hospital, Inc.
Novant Health Huntersville Medical Center
Novant Health Matthews Medical Center
Pardee Hospital
Watauga Medical Center
Wayne UNC Healthcare
Wilson Medical Center
Davis Regional Medical Center
Harris Regional Hospital
Iredell Memorial Hospital
Lake Norman Regional Medical
Margaret R. Pardee Memorial Hospital
Maria Parham Health
Novant Health Rowan Medical Center
Atrium Health Union
Betsy Johnson Hospital
Caldwell Memorial Hospital
Carteret Health Care
Central Harnett Hospital
DLP Cardiac Partners LLC/BRC



















Halifax Regional Medical Center
Johnston Health Clayton
Person Memorial Hospital
Rutherford Regional Health System
Scotland Healthcare System
Swain County Hospital
Sanford Medical Center
Bismarck
Sanford Medical Center
Altru Health System
Essentia Health -












































Trinity Hospitals

Health
- Akron Campus
Hillcrest Hospital
ProMedica Toledo Hospital
Southwest General Health Center
Aultman Hospital
Fairview Hospital
University Hospitals Cleveland Medical Center
Adena Regional Medical Center
Bethesda Hospital
Cleveland Clinic

Cleveland Clinic Mercy Hospital
Firelands Regional Medical Center
Kettering Health Hamilton
Kettering Health Main Campus
The MetroHealth System
The University of Toledo Medical Center
Trinity Medical Center West
Atrium Medical Center
Cleveland Clinic Akron General


While the wellness of all health care providers has always been a primary focus of the American College of Cardiology (ACC), the unprecedented challenges over the last several years have underscored the importance of the well-being of all clinicians.




Find resources and tools to incorporate wellness into your professional and personal lives on ACC’s Clinician Well-Being Portal.

Visit ACC.org/ClinicianWellbeing to learn more.

Fairfield Medical Center
Kettering Health Dayton
Knox Community Hospital
Lima Memorial Health System
Mercy Health Fairfield Hospital
Mercy Health Saint Ritas
Mercy Health West Hospital
Miami Valley Hospital
Mount Carmel East
Saint Elizabeth
Youngstown Hospital
Summa Health
University Hospitals Ahuja Medical Center
University Hospitals Parma Medical Center
University Hospitals St. John Medical Center
Blanchard Valley Hospital
Genesis Hospital
Grant Medical Center
Jewish Hospital
Lake West Medical Center
Marietta Memorial Hospital
Mercy Hospital Anderson
Mount Carmel St. Ann’s Hospital
OhioHealth Mansfield Hospital
Riverside Methodist Hospital
Springfield Regional Medical Center
The Christ Hospital Health Network
The Ohio State University Medical Center
Trumbull Memorial Hospital
UH Regionals Hospitals
Geauga Campus
University Hospitals Elyria Medical Center
University Hospitals Portage Medical Center
University of Cincinnati Medical Center
Community Hospital and Wellness Center
Coshocton Regional Medical Center
Good Samaritan Hospital
Holzer Cardiovascular Institute
McLaren St. Luke’s
Mercy Health Lorain Hospital
Mercy St. Vincent Medical Center
Mount Carmel Grove City
Nationwide Children’s Hospital
Soin Medical Center
Wooster Community Hospital
Ashtabula County Medical Center
Avita Ontario Hospital
Children’s Hospital Medical Center
Cincinnati Children’s Hospital Medical Center
Clinton Memorial Hospital
Doctors Hospital
East Liverpool City Hospital
Fisher - Titus Medical Center
Galion Community Hospital
Licking Memorial Hospital
Mary Rutan Hospital
Memorial Health
Mercy St. Anne Hospital
Mercy Tiffin Hospital
Miami Valley Hospital South
OhioHealth Dublin Methodist Hospital
OhioHealth Marion General Hospital
Promedica Flower Hospital
Rainbow Babies & Children’s Hospital
Southern Ohio Medical Center
Taylor Station Surgical Center
The Christ Hospital
UC Health - West Chester Hospital
University Hospital East
- OSU Wexner Medical Center
University Hospitals Bedford Medical Center
University Hospitals Conneaut Medical Center
University Hospitals Geneva Medical Center
University Hospitals Richmond Medical Center
University Hospitals Samaritan Medical Center
Upper Valley Medical Center
Western Reserve Hospital
Wilson Memorial Hospital
Norman Regional Health System
Ascension St. John Medical Center
Hillcrest Hospital South
Oklahoma Heart Institute at Hillcrest Medical Center
INTEGRIS Baptist Medical Center
Oklahoma Heart Hospital
Oklahoma Heart Hospital South
OU Medicine, Inc.
INTEGRIS Southwest Medical Center
Saint Francis Hospital
St. Anthony Hospital
Jane Phillips Memorial Medical Center
Northeastern Health System
SSM Health St. Anthony Hospital - Midwest
AllianceHealth Seminole
Duncan Regional Hospital
INTEGRIS Grove Hospital
McAlester Regional Health Center
Medical Center of Southeastern Oklahoma
Mercy Hospital Ardmore, Inc.
Oklahoma Surgical Hospital
Saint Francis South, LLC
Southwestern Medical Center
St. Anthony Shawnee Hospital Inc.
St. Mary’s Regional Medical Center
Stillwater Medical Center
Adventist Health Portland
Asante
Oregon Health & Science University
Kaiser Sunnyside Medical Center
Legacy Emanuel Medical Center
Sacred Heart Medical Center
St. Charles Health System
Bay Area Hospital
Providence Saint Vincent Medical Center
Salem Hospital
CHI Mercy
Good Samaritan Regional Medical Center
Legacy Good Samaritan Medical Center
Legacy Meridian Park Medical Center
Mckenzie Willamette Medical Center
Legacy Mount Hood Medical Center
OHSU Health Hillsboro Medical Center
Providence Medford Medical Center
Providence Portland Medical Center
Willamette Valley Medical Center
Chester County Hospital
Einstein Medical Center
Philadelphia
Conemaugh Memorial Medical Center
Doylestown Hospital
Regional Hospital of Scranton
UPMC Altoona
Butler Memorial Hospital
Hospital of the University of Pennsylvania
Mercy Fitzgerald Hospital
Penn Presbyterian Medical Center
Sharon Regional Medical Center
St. Mary Medical Center
UPMC Harrisburg
Washington Health System
Excela Health
Westmoreland Hospital
Penn State Health
Penn State Hershey Medical Center
Pennsylvania Hospital
Reading Hospital
St. Luke’s University Health Network -


Temple University Hospital
The Guthrie Clinic
UPMC Hamot
UPMC Passavant Hospital
UPMC Shadyside
Allegheny General Hospital
Crozer Chester Medical Center
Einstein Medical Center
Montgomery
Forbes Hospital
Geisinger Medical Center
Lehigh Valley Health Network
Penn Medicine/
Lancaster General Health
Saint Vincent Hospital
St. Clair Hospital
Temple University Hospital
- Jeanes Campus
UPMC Hanover
UPMC Memorial
UPMC Presbyterian Hospital
UPMC Susquehanna
UPMC West Shore
Wellspan York Hospital
Abington Memorial Hospital
Geisinger Wyoming Valley Medical Center
Jefferson Hospital
Jefferson Torresdale
Lankenau Medical Center
Lehigh Valley Health Network
Muhlenberg
Meadville Medical Center
Nason Medical Center, LLC
Nazareth Hospital
Penn State Health Holy Spirit Medical Center
Somerset Hospital
Thomas Jefferson University
UPMC East
UPMC Mercy
West Penn Hospital
ACMH Hospital
Bryn Mawr Hospital
Children’s Hospital of Philadelphia
Geisinger Community Medical Center
Holy Redeemer Hospital
Indiana Regional Medical Center
Cardiology Department
J.C. Blair Memorial Hospital
Lehigh Valley Hospital - Pocono
Mount Nittany Medical Center
Penn Highlands Dubois
Phoenixville Hospital
St. Lukes University Health Network
- Allentown
The Uniontown Hospital
UPMC McKeesport
Chambersburg Hospital
Chan Soon - Shiong Medical Center at Windber
Conemaugh Meyersdale Medical Center
Conemaugh Miners Medical Center
Ephrata Community Hospital
Evangelical Community Hospital
Grand View Hospital
GSL Hospital
Heritage Valley Beaver
Jefferson Bucks
Lehigh Valley Hospital - Hazleton
Lehigh Valley Hospital
- Schuylkill East Norwegian Street
Lower Bucks Hospital
Monongahela Valley Hospital
Paoli Hospital
Prime Healthcare
- Roxborough Memorial Hospital
Riddle Hospital
St. Christopher’s Hospital For Children
St. Luke’s Carbon Campus
St. Luke’s Hospital - Miners Campus
St. Luke’s Hospital - Monroe Campus
St. Luke’s University Health Network - Anderson
St. Luke’s University Health Network - Monroe
The Good Samaritan Hospital
UPMC Children’s Hospital of Pittsburgh
UPMC Jameson
Wayne Memorial Hospital
Wellspan Gettysburg Hospital
Wexford Hospital
Cardiovascular Center of Puerto Rico
Hospital Pavia Santurce
Hospital Auxilio Mutuo
Hospital Damas
Hospital Menonita Cayey
Saint Luke’s Memorial Hospital
Bayamon Medical Center
Doctors’ Center Hospital
Mayaguez Medical Center
Rhode Island Hospital
Kent Hospital
Landmark Medical Center
Miriam Hospital
Lexington Medical Center
Spartanburg Regional Healthcare System
AnMed Health
McLeod Regional Medical Center
Prisma Health Richland
Self Regional Healthcare
Bon Secours St. Francis Health System
MUSC Health Columbia Downtown
Conway Medical Center
Medical University of South Carolina
Prisma Health
Trident Medical Center
Beaufort Memorial Hospital
Grand Strand Health
Hilton Head Hospital
Roper Hospital
Aiken Regional Medical Center
Tidelands Georgetown Memorial Hospital
Carolina Pines Regional Medical Center
Cherokee Medical Center
East Cooper Medical Center
Kershaw Medical Center
MUSC Health Columbia Medical Center
MUSC Health Florence Medical Center
Piedmont Medical Center
Avera Heart Hospital of South Dakota
Monument Health
Sanford USD Medical Center
Avera St. Luke’s
Prairie Lakes Healthcare
Avera Sacred Heart Hospital
Sanford Aberdeen Medical Center
TENNESSEE
Baptist Memorial Hospital
Memphis
Jackson Madison County General Hospital
CHI Memorial
Methodist Hospital
Germantown
Methodist Hospital University
Tennova - Turkey Creek Medical Center
University of Tennessee Medical Center
Chattanooga - Hamilton County Hospital Authority
Holston Valley Medical Center
Maury Regional Medical Center
Parkridge Medical Center
Vanderbilt University Medical Center
Ascension Saint Thomas Hospital West
Cookeville Regional Medical Center
Saint Francis Hospital
TriStar Centennial Medical Center
Ascension Saint Thomas Hospital Midtown
Blount Memorial Hospital
Bristol Regional Medical Center
Johnson City Medical Center
Methodist Hospital North
Southern Tennessee Medical Center
St. Francis Bartlett
Sumner Regional Medical Center
Tennova - North Knoxville Medical Center
Vanderbilt Tullahoma - Harton
Ascension Saint Thomas Rutherford
Memphis Hospital - South Campus
NorthCrest Medical Center
Parkwest Medical Center
Tennova Healthcare - Clarksville
Tennova Healthcare - Cleveland
Tristar Hendersonville Medical Center
Tristar Horizon Medical Center
TriStar Summit Medical Center
Baptist Memorial Hospital - Tipton
Baptist Memorial Hospital - Union
Baptist Memorial Hospital Carroll County
CHI Memorial Hospital Hixson
Erlanger - Chattanooga Hamilton County Hospital - East Campus
Erlanger Medical Center
Hardin Medical Center
Le Bonheur Children’s Hospital
Livingston Regional Hospital
Riverview Regional Medical
Southern Tennessee – Sewanee
Southern Tennessee Regional Health System - Lawrenceburg
Southern Tennessee Regional Health System - Pulaski
Starr Regional Medical Center
Tennova Jefferson Memorial Hospital
TriStar Skyline Medical Center
TriStar Southern Hills Medical Center
TriStar Stone Crest Medical Center
Trousdale Medical Center
Vanderbilt Wilson County Hospital
West Tennessee Healthcare Bolivar General Hospital
West Tennessee Healthcare
General Hospital
West Tennessee Healthcare Dyersburg Hospital
West Tennessee Healthcare Volunteer Hospital
CHI/Baylor St. Luke’s Medical Center
CHRISTUS Mother Frances Hospital
St. Luke’s Health
- Memorial -
The Hospitals of Providence
Sierra Campus
Methodist Hospital/Methodist
Children’s Hospital
Methodist Texsan Hospital
Houston Methodist
Willowbrook Hospital
University Health
UT Health Tyler
Ascension Seton Medical Center Austin
Harris Health System
HCA Houston Healthcare Conroe
Houston Healthcare
Kingwood
Houston Methodist Hospital
Houston Methodist West Hospital
Medical Center Hospital
Metropolitan Methodist Hospital
Northeast Baptist Hospital
United Regional Healthcare System
University of Texas Southwestern Medical Center
Texas Health Presbyterian Hospital of Dallas
Baptist Medical Center
Baylor Scott & White Health
Baylor Scott & White Heart and Vascular - Dallas
Baylor Scott & White Medical Center - Round Rock
CHRISTUS Good Shepherd Medical Center
CHRISTUS Spohn Hospital Corpus Christi - Shoreline
Corpus Christi Medical Center
Covenant Health
DeTar Healthcare System
Doctors Hospital at Renaissance
HCA Houston Healthcare Medical Center
Houston Healthcare Clear
Houston Healthcare Southeast
Houston Methodist The Woodlands Hospital
Medical City Heart
Memorial Hermann Hospital TMC
Memorial Hermann Memorial City Hospital
Memorial Hermann Southeast Hospital
Memorial Hermann
The Woodlands Medical Center
Methodist Stone Oak Hospital
Northeast Methodist Hospital
Resolute Health Hospital
Rio Grande
St. David’s South Austin Medical Center
St. Luke’s
Texas Health Harris Methodist
Fort Worth
Texas Health Heart and Vascular Hospital
Texoma Medical Center
University Medical Center of El Paso
Valley Regional Medical Center
Woodland Heights Medical Center
AdventHealth Central Texas
Ascension Seton Medical Center Hays
Ascension Seton Medical Center Williamson
Baylor Scott & White
Medical Center - College Station
BSA Hospital LLC
CHI/St. Luke’s The Vintage Hospital
CHI/St. Luke’s the
Woodlands Hospital
CHRISTUS Santa Rosa Hospital
- New Braunfels
CHRISTUS Santa Rosa Hospital
- Westover Hills
Dallas Regional Medical Center
Dell Seton Medical Center at
The University of Texas
HCA Healthcare North Cypress
HCA Houston Healthcare
Heart Hospital of Austin
Hendrick Medical Center North
Houston Healthcare Pearland
Houston Healthcare West
Houston Methodist Sugar Land Hospital
Las Palmas Medical Center
McAllen Heart Hospital
Memorial Hermann
Southwest Hospital
Methodist Dallas Medical Center
Methodist Richardson Medical Center
Mission Trail Baptist Hospital
North Central Baptist Hospital
Seton Medical Center
Harker Heights
Shannon Medical Center
St. David’s Medical Center
Tarrant County Hospital District
University Medical Center
University of Texas Medical
Branchat Galveston
Wadley Regional Medical Center
Baylor Scott & White - Grapevine
Baylor Scott & White
All Saints Medical Center
Baylor Scott & White Medical Center - Irving
CHI St. Joseph Health
Regional Hospital
CHI/St. Luke’s Patients
CHI/St. Luke’s Sugar land Hospital
CHRISTUS St. Michael Health System
Citizens Medical Center
City Hospital at White Rock
Del Sol Medical Center
HCA Houston Healthcare Northwest
Hillcrest Baptist Medical Center
Hospitals of Providence
- Memorial Campus
Houston Healthcare Mainland
Houston Methodist
Clear Lake Hospital
Laredo Medical Center
Longview Regional Medical Center
Lubbock Heart Hospital
Medical City Arlington
Medical City Denton
Medical City Fort Worth
Methodist Charlton Medical Center
Palestine Regional Medical Center
Paris Regional Medical Center
Parkland Health & Hospital System
Round Rock Medical Center
Texas Health Harris Methodist
Texas Health Harris Methodist Hospital Alliance
Texas Health Harris Methodist Hospital Southwest
Texas Health Huguley Hospital
Texas Health Presbyterian Denton
Texas Health Presbyterian Hospital Plano
Texas Vista Medical Center
The Heart Hospital Baylor Plano
The University of Texas
Medical Branch Clear Lake Campus
Baptist Hospital of Southeast Texas
Baylor Scott & White Heart and Vascular - FW


Baylor Scott & White Medial Center - Lakeway
Cedar Park Regional Medical Center
CHI/St. Luke’s Lakeside Hospital
CHRISTUS Hospital - St. Elizabeth
CHRISTUS San Marcos
CHRISTUS Santa Rosa Hospital
- Medical Center
Corpus Christi Medical Center
- Doctors Regional
Doctors Hospital of Laredo
Harlingen Medical Center
Hendrick Medical Center South
Hospitals of Providence East Campus
Houston Methodist Baytown Hospital
Huntsville Memorial Hospital
Lake Granbury Medical Center
Lake Pointe Medical Center
Medical City Alliance
Medical City Dallas Hospital
Medical City Heart and Spine Hospitals
Medical City Plano
Medical City Weatherford
Memorial Hermann
Greater Heights Hospital
Memorial Hermann Katy Hospital
Memorial Hermann Northeast
Memorial Hermann Pearland
Memorial Hermann Sugar Land
Methodist Mansfield Medical Center
Midland Memorial Hospital
Navarro Regional Hospital
Odessa Regional Hospital
St. Joseph Medical Center
Texas Health Hospital Frisco
Texas Regional Medical Center at Sunnyvale
The Heart Hospital of Northwest Texas
The Medical Center Of Southeast Texas
Valley Baptist Medical Center - Brownsville
Wise Health Surgical Hospital at Parkway
Wise Health System
Baylor Scott & White Health - Marble Falls
Baylor Scott & White Medical Center - Centennial
Baylor Scott & White Medical Center - Waxahachie
CHI – St. Joseph Health College Station Hospital
Children’s Hospital of San Antonio
Children’s Medical Center of Dallas
CHRISTUS Santa Rosa San Marcos
CHRISTUS Spohn Hospital Alice
CHRISTUS St. Michael Hospital - Atlanta
Cigarroa Interventional Institute
Cook Children’s Medical Center
Dell Children’s Medical Center of Central Texas
Ennis Regional Medical Center
Guadalupe Regional Medical Center
Hendrick Medical Center Brownwood
Hunt Regional Medical Center
Matagorda Regional Medical Center
Medical City Frisco
Medical City Las Colinas
Medical City Lewisville
Medical City McKinney
Medical City North Hills
Memorial Hermann Cypress Hospital
Methodist Speciality and Transplant Hospital
Nacogdoches Medical Center
Nacogdoches Memorial Hospital
North Austin Medical Center
North Central Baptist Hospital
Parkview Regional Hospital
Peterson Regional Medical Center
Texas Children’s Hospital
Texas Health Presbyterian Hospital
The Heart Hospital Baylor Denton
The Hospitals of Providence Transmountain Campus
University of Texas MD Anderson Cancer Center
University of Texas Medical Branch Clear Lake Campus
Val Verde Regional Medical Center
Valley Baptist Medical Center
Valley Baptist Medical Center
Wise Health System - East Campus
Ogden Regional Medical Center
St. Mark’s Hospital/
Northern Utah Healthcare Corp.
University of Utah Health
Timpanogos Regional Hospital
Intermountain McKay - Dee Hospital
Intermountain Medical Center
Intermountain St. George Regional Hospital
Intermountain Utah Valley Hospital
Mountain View Hospital
Davis Hospital Medical Center
Lakeview Hospital
Salt Lake Regional Medical Center
Ashley Regional Medical Center
Castleview Hospital
Intermountain Primary Children’s Hospital
Jordan Valley Medical Center
Jordan Valley Medical Center
- West Valley Campus
Mountain Point Medical Center
Mountain West Medical Center
The University of Vermont Medical Center
Inova Fairfax Medical Campus
Winchester Medical Center Inc.
Carilion Roanoke Memorial Hospital
VCU - Medical College of Virginia
Lewis Gale Medical Center
Sentara Norfolk General Hospital
Sentara Rockingham Memorial Hospital
Augusta Health
Bon Secours Southside Medical Center
Centra Lynchburg General Hospital
Chesapeake Regional Medical Center
CJW Medical Center
Sentara Martha Jefferson Hospital
Sentara Williamsburg Regional Medical Center
SOVAH Health - Danville
University of Virginia Medical Center
Virginia Hospital Center
Bon Secours Maryview Medical Center
Inova Alexandria Hospital
Inova Loudoun Hospital
Reston Hospital Center
Riverside Regional Medical Center
Sentara Careplex Hospital
Sentara Halifax Regional Hospital
Sentara Leigh Hospital
Sentara Northern Virginia Medical Center
Sentara Virginia Beach General Hospital
Bon Secours - Memorial Regional Medical Center
Bon Secours Mercy Health - St. Mary’s Hospital
Henrico Doctors Hospital
LewisGale Hospital Montgomery
Mary Washington Healthcare
Sentara Obici Hospital
Sentara Princess Anne Hospital
SOVAH Health - Martinsville
Carilion New River Valley Medical
Children’s Hospital of The King’s Daughters, Inc.
Clinch Valley Medical Center
Fauquier Health
Johnston Memorial Hospital
Spotsylvania Regional Medical Center
Stonesprings Hospital Center
Warren Memorial Hospital
Bon Secours Southampton Medical
Bon Secours St. Francis Medical Center
Centra Southside Community Hospital
Fauquier Hospital
LewisGale Hospital Alleghany
LewisGale Hospital Pulaski
Mary Immaculate Hospital
Page Memorial Hospital
Riverside Walter Reed Hospital
Shenandoah Memorial Hospital
Stafford Hospital
Twin County Regional Healthcare
UVA Prince William Medical Center
Virginia Commonwealth University Medical Center
Wythe County Community Hospital
WASHINGTON
Deaconess Hospital MultiCare Health System
MultiCare Tacoma General Hospital
Virginia Mason Medical Center
PeaceHealth St. Joseph Medical Center
Providence Regional Medical Center
Providence Sacred Heart Medical Center
Swedish Health Services
VMFH St. Joseph Medical Center
VMFH St. Michael Medical Center
Confluence Health Central Washington Hospital & Clinics
MultiCare Auburn Medical Center
MultiCare Good Samaritan Hospital
Overlake Hospital Medical Center


PeaceHealth Southwest Medical Center
Providence St. Peter Hospital
University of Washington Medical Center - Montlake
Evergreen Healthcare
Kadlec Regional Medical Center
Legacy Salmon Creek Medical Center
Astria Sunnyside Hospital
Capital Medical Center
Grays Harbor Community Hospital
Providence St. Mary’s Medical Center
Seattle Children’s Hospital
St. John Medical Center
Swedish Edmonds Hospital
Swedish Medical Center - Issaquah
Trios Health
University of Washington Medical Center - Northwest
Valley Medical Center
Virginia Mason Memorial
VMFH St. Anne Hospital
VMFH St. Francis Hospital
Mon Health Medical Center
Wheeling Hospital
Camden - Clark Medical Center
St. Mary’s Medical Center
Charleston Area Medical Center
Raleigh General Hospital
WVU Medicine
CAMC Memorial Hospital
Berkeley Medical Center
St. Francis Hospital
Thomas Memorial Hospital
Weirton Medical Center
WVU Medicine United Hospital Center
Beckley Appalachian Regional Healthcare
Logan Regional Medical Center
Princeton Community Hospital
Reynolds Memorial Hospital
Aurora St. Luke’s Medical Center
Marshfield Medical Center
UW Health
Ascension Columbia St. Mary’s Hospital
Gundersen Lutheran Health System
Marshfield Medical Center - Weston
Mercy Hospital and Trauma Center
Ascension Columbia St. Mary’s Hospital
Aurora BayCare Medical Center
Aurora Grafton
ThedaCare Regional Medical Center
Aurora Medical Center Summit
SSM Health St. Mary’s Hospital - Madison
UnityPoint Health - Meriter
Waukesha Memorial Hospital
Ascension NE Wisconsin
St. Elizabeth Hospital
Aspirus Wausau Hospital
Bellin Memorial Hospital
Froedtert Hospital
Holy Family Memorial
HSHS St. Vincent Hospital
Mayo Clinic Health System
- Eau Claire Hospital
ProHealth Waukesha
Memorial Hospital
St. Agnes Hospital
Aurora Medical Center in Kenosha
Beloit Memorial Hospital
Froedtert South, Inc.
HSHS Sacred Heart Hospital
Marshfield Medical Center - Eau Claire
The Monroe Clinic
Watertown Regional Medical Center
Wheaton Franciscan Healthcare - All Saints, Inc.
Wheaton Franciscan Healthcare - Franklin, Inc.
Wheaton Franciscan Healthcare - St. Francis, Inc.
Wheaton Franciscan Inc.
- Elmbrook Memorial Campus
Ascension Columbia St. Mary’s Hospital Milwaukee
Ascension NE Wisconsin Mercy Hospital
Aspirus Stevens Point Hospital
Aurora Medical Center Oshkosh
Aurora Sheboygan Memorial Medical Center
Children’s Wisconsin
Community Memorial Hospital
HSHS St. Mary’s Hospital
Mayo Clinic Health System
- Franciscan Healthcare
Mercyhealth Hospital and Medical Center - Walworth
Oconomowoc Memorial Hospital
Wheaton Franciscan - St. Joseph
Wyoming Medical Center
Campbell County Health
Sheridan Memorial Hospital
Cheyenne Regional Medical Center
Evanston Regional Hospital
SageWest Health Care - Riverton
SageWest Healthcare
Lander
culating eGFR in patients, opting to adopt the algorithm en dorsed by the National Kidney Foundation. She notes there also has been a broader push among clinicians in recent years to consider the impact of social drivers like income, housing status, and access to food and transportation on patients of color when making clinical assessments.
“I think a lot of times when we’re measuring race we’re actually measuring racism, both structurally and interper sonally,” Saunders says.
Much of the recent attention to ward removing race in clinical as sessments began with the publica tion of that 2020 article in the New England Journal of Medicine, which listed about a dozen tools providers use when assessing everything from lung function to a patient’s risk of dying in the hospital from heart fail ure. Such tools could lead to issues such as nonwhite patients experienc ing delays in care that white patients don’t face, the article notes.
“Many of these race-adjusted algo rithms guide decisions in ways that may direct more attention or resourc es to white patients than to members of racial and ethnic minorities,” wrote the authors, from Massachusetts General Hospital, Harvard Medical School and NYU Langone Health. “If doctors and clinical educators rigor ously analyze algorithms that include race correction, they can judge, with fresh eyes, whether the use of race or ethnicity is appropriate.”
No simple solution. A study pub lished in May 2021 by the American Journal of Obstetrics and Gynecol ogy introduced an updated model that does not factor in race when es timating whether women will have a successful vaginal birth after cesarean section, or VBAC. By lowering the estimated chance of success for women of color, a previous version of the VBAC calculator – a tool singled out in the NEJM piece – could push them toward a C-section, which is a major surgical procedure many maternal health experts believe is performed too often.
says Dr. Malika Fair, senior director of equity and social accountability for the Association of American Medical Colleges. “Their intent when they were being used sometimes was to identify health inequities.”
Fair says unilaterally removing race from every algorithm is a feasible approach, but fails to answer whether doing so would make things better or worse for patients. “We have to take the time to figure that out so that we don’t end up inadvertently creating more racial health inequities when we remove race from the equation,” Fair says.
Notably, a 2021 study published in The Lancet Oncology found that re moving race from an eGFR equation could undercut cancer treatment in Black patients.
Spurring change. Dr. Megan Mahoney, chief of staff for Stanford Health Care and a professor of medi cine at Stanford University, says pro fessional medical societies can play a huge part in providing and promot ing guidance on alternatives that cli nicians can use to assess disease risk without factoring in race. Yet much of the action taken thus far has been led by individual hospitals and health systems, which have made policy deci sions after deliberation and consider ation by their own experts.
Mahoney says medical societies can streamline the decision process for hospitals by serving as a trusted arbiter to review the evidence and pro vide guidance that most will accept.
“A particular health care system can do it, it’s just that it’s going to be harder to get buy-in from those who are actually implementing the change – the physicians on the front line – without the professional societies backing them,” Mahoney says.
On the other hand, adjusting for race in some cases may have benefits if it results in minority groups potentially receiving more consideration. For example, race adjustment within an atherosclerotic cardiovascular disease risk estimator – which gauges the risk of having an event like a stroke and helps clini cians determine when to start patients on cholesterol-lowering medication – can automatically classify patients who identify as Black as being at higher risk than white patients, making earlier detection and intervention more likely for Black patients.
“Using race in these clinical algorithms hasn’t been all bad,”
She agrees it’s important to identify the root causes of health disparities that have led to differences in risk outcomes. But Mahoney fears leaving race-based algorithms in place could reinforce concepts that tie race to biology, and could have long-term social and clinical ramifications.
“The perpetuation of race as a biological factor both in medical education and in medicine in gen eral: The risk of that far outweighs that minor benefit some racial groups might be getting from the current state,” Mahoney says. “We are really putting our medi cal students and a whole generation of trainees at a disadvantage when the concept of biological race is reinforced in their training.”











Consider
WHEN YOU’RE preg nant, deciding where to have your baby is a practical and per sonal matter, an edu cated and emotional choice. Asking ques tions and doing your own research in ad vance helps you make an informed decision – one you feel comfortable with – about where you want to give birth.
Where you deliver your baby is closely tied to your maternity care provider, of course. “People are usually going to make that decision based on their first finding a physician or midwife they feel that they connect with,” says Dr. Jennifer Frink, an OB-GYN and medical director of the women’s health service line at Ascension Michigan, who practices out of Ascension Borgess Hospital in Kalamazoo.
Shared decision-making is an impor tant health care approach, Frink says. “You want your providers – physician or midwife – and the hospital to embrace this philosophy,” she says. “Your concerns, your fears, your wants and hopes about how the labor experience goes – you want all those components to be heard and val ued by the care team that’s working with you. By the same token, you want to have a team of professionals that, once they listen to those things, are going to give you some options that are medically ap propriate for you.”
Checking each hospital’s quality data can help ensure the best outcomes for you and your baby. Knowing what you want in terms of labor and delivery options helps you and your doctor shape an individual birth plan. Strong support – from breastfeeding guidance to having your partner at your side – makes a huge difference in this unique, unforgettable experience.
Public data on maternal and fetal outcomes is increasingly available from indi vidual maternity hospitals and statewide websites. If you can’t find it, ask. The U.S. News ratings of Best Hospitals for Maternity Care can help; see Page 83 for high-performing hospitals and usnews.com/bestmaternityhospitals for more information. The following indicators can help you compare facilities: C-section rate. Vaginal deliveries, when possible, are associated with fewer risks and better outcomes than cesarean sections. To gauge hospital quality in general, ask or search online for C-section rates. Data shows that a facility, not just individual physicians, drives C-section rates, says Dr. Holly Loudon, an
OB-GYN and chair of the department of obstetrics, gynecology and reproductive science at Mount Sinai West and Mount Sinai Morningside in New York City. “It’s really important to look at that C-section rate and compare it with other hospitals in the region when you’re choosing where you want to deliver,” Loudon says. High-risk academic centers often have a higher Csection rate because they have more highrisk deliveries and multiple births.
VBAC rate. In the past, it was almost as sumed that women who delivered their first babies by C-section would deliver any subse quent babies by C-section, as well. However, a vaginal birth is possible in many cases. Two similar terms are used for this option. TOLAC, or “trial of labor after cesarean,” and VBAC, which means “vaginal birth after cesarean,” and implies success.
An uncommon but possible complica tion is when the scar on the uterus from the previous C-section separates during the vaginal birth attempt, known as uter ine rupture, which is a medical emergency. Women interested in VBAC receive coun seling from their doctors to weigh the risks and benefits.

NTSV C-section rate. This is the C-sec tion rate for first time mothers with lowrisk pregnancies; it stands for “nulliparous, term, singleton, vertex.” In other words, these women aren’t having a multiple birth like twins or triplets, aren’t delivering pre maturely and their baby is not in a breech or other higher-risk position during birth – yet they’re undergoing cesarean sections.
Early elective delivery rate. When C-sections are scheduled (or labor is in duced) before 39 weeks of gestation – with out medical necessity – it’s known as early elective delivery. A high rate is considered a red flag in terms of maternity hospital quality. “We know that babies that are born before 39 weeks ‘just because’ don’t do as well as babies that are allowed to deliver when their moms go into labor naturally,” Frink says. “We also know that people who have inductions before 39 weeks ‘just be cause’ tend to have a higher risk of ending up with a C-section.”
Early deliveries aren’t always avoidable,
she notes. But there are pretty strict criteria about when that’s the case.
Episiotomy rate. An episiotomy is a surgical cut made to the vagina during childbirth. Routine use of episiotomy is not recommended, except when indicated in certain clinical situations. “Episiotomies have become something that used to be done routinely and now are very rarely needed,” Loudon says.
Items to address about your maternity care include:
l Does the facility have maternal-fetal medicine spe
labor positions involving leaning or sitting on the ball. Birthing tubs can make movement more comfortable during labor and may enable water births for low-risk, single, full-term pregnancies.
l Can you have at least one support person with you? If you’re hav ing a doula at your birth, make sure that person doesn’t “count” as the single support person.
l Will you have induced labor? What goes into that decision? Cer tain pregnancy complications or medical conditions may make inducing labor safer, rather than waiting for contractions to start.
l Does your facility offer VBAC/TOLAC? If you’re interested in VBAC, ask if the facility allows it. Because trying to have a VBAC comes with the remote risk of uterine rupture, a hospital must be equipped to quickly respond. “The risk is less than 1% for an average patient undergoing a trial of labor,” Cormano says. “But it can be a very dangerous outcome. It requires an emer gency C-section. It requires being in a setting where people can respond within seconds.”
l Do you offer gentle C-section? “We’re doing more with what some people are calling ‘gen tle cesareans’ or ‘family-centered cesareans,’ where we use clear drapes so you can see your baby right after they’re born through a clear drape,” Loudon says. “And then have imme diate skin-to-skin contact and even breastfeeding right away.”
l Is delayed cord clamping available? That al lows extra time for nutrient-rich blood in the placenta and cord to flow to the baby.
If your pregnancy is considered high risk, you might also want to know if the hospital
cialists or perinatologists? For women in a high-risk category, this is pertinent information.
l Is there the option for laboring with a midwife or doula? When hospitals have these support components, C-section rates are reduced, notes Dr. Julia Cormano, an OB-GYN and assistant professor of obstetrics, gynecolo gy and reproductive sciences with UC San Diego Health.
l Is group prenatal care an option? Programs like Cen teringPregnancy allow expectant mothers at similar pregnancy stages to receive prenatal education and social support in a group setting. Emerging research suggests that group prenatal care is associated with a lower risk of having a preterm birth or a baby with a low birth weight.
l What pain-control options are offered, including and beyond epidurals? What labor positions can you deliver in? Can you walk around? Are birthing balls or birth ing tubs available? Birthing balls can enable alternative

has a neonatal intensive care unit and if an anesthesiologist and pediatrician are available around the clock. How often can you see your baby in the NICU? Some hospitals offer parents tech options like real-time video access to their newborns. If your baby unex pectedly is in need of NICU care, and the hospital does not have a NICU, where does the baby get transferred to?
Breastfeeding is shown to be optimal for babies, but it’s definitely a learning experience for new mothers. Ask about international board-certified lactation consultants on staff.
You can also look for Baby-Friendly facilities. Baby-Friendly hospitals and birthing centers are designated as such for their high standards in supporting and enabling breastfeeding as soon as possible after birth. Rooming-in for healthy babies and mothers, and maternity staff that’s fully trained in breastfeeding care and problem-solving for feeding difficulties, make continued breast feeding more likely when families go home. l
HILDBIRTH is often a joyous event. And the hospital where a pregnant patient delivers can play a big role in mak ing it a positive experience. When it comes to ma ternity care for uncomplicated pregnancies, the best hospitals achieve safe outcomes, offer sound care without performing unnecessary inter ventions and support patients who choose to breastfeed. The hospitals listed here excel in these respects. To identify them, we surveyed maternity centers across the nation and obtained detailed data from nearly 600. For example, we collected stats on each hospital’s rate of cesarean section.
Reducing risks. C-section, one of the oldest medical pro cedures known to humanity, can be lifesaving. But like all surgeries, it has risks, including potentially dangerous blood loss, and it’s costlier and has a longer recovery time than vaginal delivery. C-section also is linked with long-term problems in the newborn, such as higher rates of asthma and allergies. There are long-term risks for the mother, too – and for any future children. Internal scarring from the operation can, in subsequent preg nancies, lead to placenta accreta, a dangerous condition. For these rea sons, experts discourage unnecessary C-sections. Our methodology rewards hospitals for achieving low C-section rates; this measure counted for 30% of each hospital’s overall score.
Experts also advise against induc ing labor or performing a C-section
if a patient is more than a week away from her due date, unless there’s a compelling medi cal reason for initiating an early elective delivery. Our methodology checks whether a hospital has a reasonable early elective delivery rate of 5% or less. This measure counted for one-tenth of each hospital’s over all score.
While labor and delivery usually end well, com plications can occur. Most have no lasting consequences. But no parent wants to see their helpless newborn whisked away to a neonatal intensive care unit. We collected data on each hospital’s rate of newborn complications, both moderate and severe, and weighed it at 25%.
Breastfeeding has benefits for a baby, including a stronger immune system. That’s why experts encourage new parents to feed breast milk if possible. But hospitals don’t always re inforce that message – or give patients the support they need to lactate and nurse. Each hospital’s success in encouraging and supporting breastfeeding counted for 25%.
The last 10% of the methodology rewarded hospitals that routinely offer vaginal birth after cesarean, or VBAC, to women who have had a previous C-section and want to avoid having another one.
The tables that follow also display the availability of several features that may interest you but that don’t factor into the methodology, such as whether a hospital welcomes partners to stay overnight. For more, check out usnews.com/bestmaternityhospitals.
Thomas Hospital, Fairhope 18.4% 2% 4.1% 58.3% Yes No No - Yes Yes
ARIZONA
Banner Casa Grande Medical Center, Casa Grande 21.8% 0% 1.8% 14.4% Yes No No No Yes Yes
Banner Del E. Webb Medical Center, Sun City West 15.9% 0% 2.1% 55.6% Yes Yes Yes No Yes Yes
Banner Desert Medical Center, Mesa 18.5% 0% 1.7% 51.6% Yes Yes Yes Yes Yes Yes
Banner Estrella Medical Center, Phoenix 16.7% 1% 2.2% 43.9% Yes Yes Yes Yes Yes Yes
Banner Gateway Medical Center, Gilbert 19.9% 3% 1.5% 40.6% Yes No Yes Yes Yes Yes
Banner Ironwood Medical Center, San Tan Valley 11.2% 0% 2.1% 52.0% Yes Yes Yes No Yes Yes
Banner Thunderbird Medical Center, Glendale 24.1% 1% 1.2% 43.1% Yes No Yes Yes Yes Yes
Banner-University Medical Center Phoenix 17.8% 0% 2.7% 39.2% Yes Yes Yes Yes Yes Yes
TMC Healthcare-Tucson 20.5% 4% 1.8% 44.9% Yes Yes Yes Yes Yes Yes
CALIFORNIA
Emanate Health Queen of The Valley Hospital, West Covina 21.6% 1% 2.4% 35.9% Yes No No Yes Yes Yes
Hoag Memorial Hospital Presbyterian, Newport Beach 25.9% 3% 1.6% 57.2% Yes Yes Yes Yes Yes Yes Huntington Hospital, Pasadena 22.2% 0% 2.3% 42.2% Yes No No Yes Yes Yes
Kaiser Permanente Anaheim and Irvine Med. Centers, Anaheim 22.7% 0% 1.5% 67.1% Yes Yes No Yes Yes Yes
Kaiser Permanente Baldwin Park Medical Center, Baldwin Park 22.3% 1% 1.0% 71.1% Yes - - Yes - Kaiser Permanente Downey Medical Center, Downey 21.5% 0% 2.7% 60.8% Yes Yes No Yes Yes Yes
Kaiser Permanente Fontana and Ontario Med. Centers, Fontana 20.0% 0% 2.1% 58.0% Yes Yes No Yes Yes Yes
Kaiser Permanente Los Angeles Medical Center 22.3% 0% 2.2% 53.1% Yes Yes Yes Yes Yes Yes
Kaiser Permanente Moreno Valley Medical Ctr., Moreno Valley 22.0% 0% 4.2% 70.3% Yes Yes No Yes Yes Yes
Kaiser Permanente Panorama City Medical Ctr., Panorama City 16.6% 0% 2.3% 58.1% Yes Yes No Yes Yes Yes
Kaiser Permanente Riverside Medical Center, Riverside 21.6% 1% 1.8% 68.9% Yes Yes No Yes Yes Yes
Kaiser Permanente San Diego Zion and San Diego Med. Ctr. 22.5% 0% 2.9% 60.9% Yes Yes No Yes Yes Yes
Kaiser Permanente South Bay Medical Center, Harbor City 20.6% 1% 2.5% 65.1% Yes Yes No Yes Yes Yes
Kaiser Permanente Woodland Hills Med. Ctr., Woodland Hills 25.0% 0% 2.0% 65.9% Yes Yes - No Yes Yes
Kaweah Health Medical Center, Visalia 24.7% 1% 1.4% 50.9% Yes Yes No No Yes Yes
Loma Linda University Children’s Hospital, Loma Linda 18.5% 0% 4.0% 58.1% Yes No No Yes Yes Yes
Loma Linda University Medical Center-Murrieta 20.7% 0% 4.3% 70.4% Yes Yes No Yes Yes Yes
Lucile Packard Children’s Hospital Stanford, Palo Alto 21.9% 0% 2.9% 65.5% Yes Yes No Yes Yes Yes
MemorialCare Miller Children’s & Women’s Hosp. Long Beach 23.7% 0% 2.8% 51.3% Yes No No Yes Yes Yes MemorialCare Orange Coast Medical Center, Fountain Valley 24.8% 4% 1.8% 56.4% Yes - - Yes - MemorialCare Saddleback Medical Center, Laguna Hills 23.2% 10% 1.3% 54.4% Yes - - Yes - NorthBay Medical Center, Fairfield 24.2% 0% 0.9% 75.5% Yes No No Yes Yes Yes Palomar Medical Center Escondido 17.8% 0% 3.5% 59.8% Yes No No No Yes Yes
Palomar Medical Center Poway 20.1% 0% 1.2% 78.9% Yes No Yes Yes Yes Yes Providence St. Jude Medical Center, Fullerton 20.9% 0% 2.0% 49.5% Yes No Yes Yes Yes Yes Redlands Community Hospital, Redlands 20.5% 3% 2.6% 75.1% Yes No No Yes Yes Yes
Salinas Valley Memorial Healthcare System, Salinas 23.6% 0% 1.3% 61.0% Yes No No Yes Yes Yes
Santa Clara Valley Medical Center, San Jose
Sharp Chula Vista Medical Center, Chula Vista
Stanford Health Care-ValleyCare, Pleasanton
COLORADO continued
SCL Health Saint Joseph Hospital,
SCL Health St. Mary’s Medical Center, Grand Junction
UCHealth Longs Peak Hospital, Longmont
UCHealth Medical Center of the Rockies, Loveland
UCHealth Memorial Hospital, Colorado Springs
UCHealth Poudre Valley Hospital, Fort Collins
UCHealth University of Colorado Hospital, Aurora
UCHealth Yampa Valley Medical Center, Steamboat Springs
Hospital of Central Connecticut, New Britain
William W. Backus Hospital, Norwich
Ascension Sacred Heart Pensacola Hospital, Pensacola
Ascension St. Vincent’s Clay County, Middleburg 15.9%
Ascension St. Vincent’s Southside Hospital, Jacksonville 16.1%
Baptist Medical Center Beaches, Jacksonville Beach 18.3%
Lakeland Regional Health Medical Center, Lakeland 22.5%
NCH Baker Hospital, Naples 19.9%
Sarasota Memorial Hospital, Sarasota 23.5%
UF Health Shands Hospital, Gainesville 24.7%
2.1%
1.1% 46.5%
2.3% 32.3%
1.6% 69.3%
St. Alphonsus Regional Medical Center, Boise 19.8% 0% 3.2% 62.7%
St. Luke’s Magic Valley Medical Center, Twin Falls 26.5% 1% 1.9% 55.7%
St. Luke’s Nampa Hospital, Nampa 20.7% 1% 2.3% 72.6%
St. Luke’s Regional Medical Center, Boise 24.1% 3% 2.4% 72.1%
Advocate Christ Medical Center, Oak Lawn 26.2% 0% 1.7% 35.8% Yes Yes No Yes Yes Yes
Advocate Condell Medical Center, Libertyville 26.0% 0% 2.3% 64.4% Yes No Yes No Yes Yes
Advocate Good Samaritan Hospital, Downers Grove 26.2% 0% 1.9% 39.9% Yes No No Yes Yes Yes
Advocate Good Shepherd Hospital, Barrington 23.8% 0% 1.4% 70.8% Yes No No No Yes Yes
Advocate Illinois Masonic Medical Center, Chicago 23.2% 3% 2.4% 65.0%
Advocate Lutheran General Hospital, Park Ridge 25.6% 0% 1.6% 48.0%
Advocate Sherman Hospital, Elgin 19.9% 0% 2.6% 57.9%
Advocate Trinity Hospital, Chicago 19.0% 0% 2.3% 23.8%
Alton Memorial Hospital, Alton 16.2%
Edward Hospital, Naperville 24.9%
Elmhurst Hospital, Elmhurst
Northwestern Medicine Kishwaukee Hospital, DeKalb
Northwestern Medicine Lake Forest Hospital, Lake Forest
Northwestern Memorial Hospital, Chicago
Rush Copley Medical Center,
2.2% 57.6%
1.9%







Hospital,
Hospital of Baltimore
of Maryland Upper Chesapeake Medical Center,
of Maryland Shore Medical Center
Easton
Beth Israel Deaconess Medical Center, Boston 20.7% 0% 3.3% 43.9% Yes No Yes Yes Yes Yes
Boston Medical Center 20.3% 0% 3.3% 42.3% Yes Yes Yes Yes Yes Yes Southcoast Hospitals-Fall River, New Bedford & Wareham 17.1% 0% 2.7% 43.8% Yes Yes Yes No Yes Yes
Tufts Medical Center, Boston 21.1% 7% 2.0% 48.1% Yes - - Yes - UMass Memorial Medical Center, Worcester 21.3% 2% 3.0% 41.1% Yes Yes Yes Yes Yes Yes
Beaumont Hospital-Farmington Hills 21.4% 0% 2.5% 26.2% Yes No Yes No Yes Yes Beaumont Hospital-Grosse Pointe 25.7% 3% 1.7% 58.4% Yes Yes Yes No Yes Yes
Beaumont Hospital-Royal Oak 25.9% 0% 1.8% 60.5% Yes Yes Yes Yes Yes Yes
Beaumont Hospital-Troy 24.0% 0% 1.8% 52.7% Yes Yes Yes Yes Yes Yes
Beaumont Hospital-Wayne 22.9% 0% 2.0% 36.6% Yes No Yes No Yes Yes
McLaren Greater Lansing Hospital, Lansing 19.6% 3% 2.0% 41.2% Yes No Yes - Yes Yes
Spectrum Health Big Rapids Hospital, Big Rapids 20.0% 0% 1.4% 55.3% No No Yes No Yes Yes
Spectrum Health Gerber Memorial, Fremont 20.6% 0% 2.8% 63.6% No Yes Yes No Yes Yes
Spectrum Health Pennock, Hastings 4.8% 0% 2.8% 58.9% No Yes Yes No Yes Yes
Spectrum Health Zeeland Community Hospital, Zeeland 17.0% 0% 2.3% 64.0% No No Yes No Yes Yes
Spectrum Health-Butterworth & Blodgett Campuses, Grand Rapids 24.3% 5% 2.2% 58.6% Yes Yes Yes Yes Yes Yes U. of Michigan Health Von Voigtlander
Health Medical Center-Hopewell, Pennington
Medical Center, Pompton Plains
Englewood Hospital, Englewood
Medical Center-Elmer
Jefferson Health-Stratford, Cherry Hill & Washington Township
Jersey Shore U. Med. Ctr. at Hackensack Meridian Hlth., Neptune 23.2% 0% 3.2% 51.4% Yes Yes Yes Yes Yes Yes Morristown Medical Center, Morristown 22.7% 0% 1.8% 59.0% Yes Yes Yes Yes Yes Yes Newton Medical Center-New Jersey, Newton 21.8% 0% 2.5% 62.2% No Yes Yes No Yes Yes Ocean U. Med. Ctr. at Hackensack Meridian Hlth., Brick Township 23.8% 1% 1.6% 43.1% Yes Yes No No Yes Yes
Overlook Medical Center, Summit 24.3% 0% 1.6% 55.7% Yes Yes Yes Yes Yes Yes Pascack Valley Med. Ctr. at Hackensack Meridian Hlth., Westwood 23.1% 2% 2.9% 54.1% Yes Yes Yes No Yes Yes

NEW YORK
Cayuga Medical Center
Ithaca
Thompson Hospital, Canandaigua
Island
Med.
Sinai Morningside & Mount Sinai West Hospitals
H. Noyes Memorial Hospital, Dansville
Joseph’s Health Hospital, Syracuse
Peter’s Hospital-Albany
Atrium Health-Cabarrus, Concord
Atrium Health-Pineville, Charlotte 20.7% 2% 1.6% 49.6% Yes Yes No No Yes Yes Atrium Health-Union, Monroe 19.6% 3% 3.2% 35.4% Yes Yes No Yes Yes Yes
Duke Regional Hospital, Durham 16.8% 0% 2.8% 70.1% Yes Yes Yes No Yes Yes Duke University Hospital, Durham 25.7% 0% 2.4% 53.4% Yes Yes Yes Yes Yes Yes
FirstHealth Moore Regional Hospital, Pinehurst 25.5% 0% 1.4% 46.4% Yes Yes No Yes Yes Yes
Harris Regional Hospital, Sylva 13.8% 0% 3.5% 82.1% No Yes Yes - Yes Yes
Moses H. Cone Memorial Hospital, Greensboro 23.2% 0% 3.3% 44.5% Yes Yes Yes Yes Yes Yes
Sentara Albemarle Medical Center, Elizabeth City 17.9% 0% 2.5% 49.3% Yes - Yes No Yes Yes UNC Rex Hospital, Raleigh 23.0% 0% 1.6% 51.0% Yes Yes Yes Yes Yes Yes
University of North Carolina Hospitals, Chapel Hill 17.9% 0% 2.1% 57.2% Yes Yes Yes Yes Yes Yes
NORTH DAKOTA
Sanford Medical Center Bismarck 14.4% 2% 2.2% 62.9% Yes - - Yes - Sanford Medical Center Fargo 23.6% 3% 3.1% 52.2% Yes - - Yes - OHIO
Atrium Medical Center-Middletown 14.3% 0% 3.3% 59.4% Yes Yes Yes No Yes Yes Bethesda North Hospital, Cincinnati 26.5% 2% 1.8% 47.4% Yes Yes Yes No Yes Yes Cleveland Clinic Fairview Hospital 21.6% 4% 3.1% 66.0% Yes Yes Yes Yes Yes Yes Cleveland Clinic Hillcrest Hospital 25.5% 3% 2.4% 55.8% Yes Yes Yes Yes Yes Yes Cleveland Clinic Mercy Hospital, Canton 15.3% 0% 0.9% 44.5% Yes Yes Yes Yes Yes Yes Kettering Health Main Campus, Kettering 22.0% 0% 2.3% 62.7% Yes No No Yes Yes Yes Soin Medical Center, Beavercreek 16.5% 1% 2.2% 48.1% Yes Yes No No Yes Yes University Hospitals Portage Medical Center, Ravenna 20.0% 0% 3.8% 56.4% Yes Yes Yes No Yes Yes
County Memorial Hospital, Lawton
Medical Center,
PENNSYLVANIA
Carilion Roanoke Memorial Hospital, Roanoke
Inova Fair Oaks Hospital, Fairfax 26.0% 0% 2.0% 62.5% Yes Yes Yes Yes Yes Yes Sentara Martha Jefferson Hospital, Charlottesville
Sentara Northern Virginia Medical Center, Woodbridge 22.1% 0% 2.8% 42.9% Yes No Yes Yes Yes Yes Sentara RMH Medical Center, Harrisonburg 25.1% 1% 2.6% 59.8% Yes Yes Yes No Yes Yes Sentara Williamsburg Regional Medical Center, Williamsburg 16.0% 0% 3.0% 70.6% Yes Yes Yes No Yes Yes
Health Community Memorial Hospital, South Hill
Medical Center, Richmond
Medical Center,
If you’re noticing these red flags, it could be time to move on
by Ruben Castaneda and Angela Haupt ©STAYING W ITH A DOCTOR or other provider you’re not happy with is as harmful as staying in a relationship you know is bad because it’s easier than making a change. But parting ways may be the healthiest move. “If you’re not happy with your doctor, you’re not going to have a good relationship. That trust won’t be there, so you might hesitate to see them,” says Michael Urban, senior lecturer and director of the doctorate of occupational therapy program at the University of New Haven in Connecticut. “And you won’t tell them everything about your health when you do go, which could put your health at risk.”
Changing doctors can be a challenging process, however. Before you embark on that path, analyze whether a change is necessary. Here are 11 signs it’s time to fire your doctor:
1. You don’t mesh. You don’t need to see eye to eye on everything, but it’s helpful if you work well together. If you want a partnership, for example, a doctor who spouts commands is not the best fit; if you value a warm bedside manner, consider ditching a formal, distant physician.
“Some patients like doctors who are very direct and blunt,” says Dr. Kenny Lin, a family physician based in Washington, D.C. “And some patients can’t stand that type of doctor because they think he or she isn’t empathetic enough or doesn’t provide enough options.” When there’s a mismatch, neither person is at fault – but it could be grounds for termination.
2. Your time isn’t respected.
Do you routinely wait an hour to see your physician, only to feel like you’re being rushed through the visit? If your doctor doesn’t take the time to answer your questions or address your concerns, there’s a problem. “If your doctor’s not giving you the time you need, they’re not listening to you fully,” Urban says. “They’re not giving you the full care that you need.”
The medical community is becoming in-



creasingly sensitive to patients’ precious time. If your doctor’s chronic lateness makes you grind your teeth, why not have a look elsewhere?
3. You’re kept in the dark. A doctor should be open and thorough about why he recommends a certain treatment or orders a specific test, plus share all results with you. If he doesn’t explain a decision, or “not to your satisfaction, at that point a doctor is bad,” Lin says.
It’s also important that information is shared using terms you understand, rather than complicated medical jargon; otherwise, explanations are meaningless. Your health is too important for you to be left feeling confused or uninformed.
4. You’re not being heard.
Listening is one of the most important skills a physician can have, says Dr. Neel Anand, professor of orthopedic surgery and medical director of the Cedars-Sinai Spine Center in Los Angeles.
A good doctor listens to a patient’s description of pain and

other symptoms. “As physicians, we’re a busy bunch,” he says. “But our most important time spent in a day is with our patients. If we don’t allow them to give us a complete picture of their overall health, we can’t help them effectively maximize it. It’s best to go with the doctor who puts down the chart and actively listens to what’s going on with you.”
5. You find the office staff unprofessional. The receptionists are the link between you and the doctor. If they blow you off – or neglect to give a message to the physician about side effects you’re experiencing due to a new medication, for example – your health could be at risk. Even if you like your doctor, a bad experience with office staff could be grounds for your exit.

6. You don’t feel comfortable.
Doctors need to know intimate details you may not even share with friends or family members. If you’re unable to disclose such facts, you and your doctor may not be the right match.

A sense of unease about her decisions and recommendations, even if you can’t put your finger on exactly why you feel uncomfortable, is also a perfectly legitimate reason for cutting the cord, says Don Powell, president and CEO of the American Institute


for Preventive Medicine, which promotes healthy behavior through well ness programs and publications.
Beware of sloppy medical mistakes, too: If your doctor prescribes a drug you’re allergic to – and you know that information is in your medical history – a separation may be needed.
7. Your care isn’t coordinated.
Your primary care physician should be the quarterback of your health care team, managing each step of the medical process. That means keeping track of any reports and instructions from the specialists you see and talking with you about their recommendations. If that’s not happening, important aspects of your health care could slip through the cracks.
8. You can’t get access.
A good doctor is available for follow-up questions and concerns. Pa tient advocate Trisha Torrey, founder of the Alliance of Professional Health Advocates and author of “You Bet Your Life! The 10 Mistakes
Every Patient Makes,” recalls the time her husband developed severe tooth pain on a weekend. His dentist’s voicemail included a cell phone
number and the promise of a quick response. But her husband never heard back. An emergency clinic visit and root canal later, he told his dentist she was fired.
A growing number of doctors are making themselves available to patients via email, text message and virtual platforms. At the very least, you need to know that in an emergency, you won’t be left hanging.
9. Your care isn’t holistic.
While most physicians can capably prescribe medication and order tests, it’s important to understand if your physician considers how a new drug or protocol will impact your lifestyle, says Dr. Joseph Giaimo, a pulmonologist in Palm Beach Gardens, Florida, and immediate pastpresident of the American Osteopathic Association.
If your doctor isn’t addressing your medical issue from a “mind, body, spirit” perspective, she might not be for you. The best health outcomes will happen when you are able to talk to your physician about lifestyle issues like eating habits, how much exercise you should get and whether you’re interacting with other people enough to avoid social isolation.
10. Your doctor is a reluctant learner.
Whether your doctor went to medical school three or 30 years ago, make sure you have access to his curriculum vitae. The CV, or résumé, can offer a great picture of how in touch your doctor is with medical advances, Anand says.
For example, techniques to treat back pain have advanced in the last 30 years. “You want to make sure (your doctor) is keeping pace,”
Anand says. The CV will tell you what conferences the physician has attended, what continuing education he is receiv ing and whether he is training other medical professionals in the field. A doctor could provide such education by speaking at conferences, conducting research studies, or authoring journal articles or textbook chapters in a given specialty, be it cardiovascular health or spinal conditions.
11. You’re not treated with respect.
If your physician has you wondering why doctors are so rude, it’s time to split up. Same goes if she trivializes your concerns. One of the clearest signs you should move on is if she walks out of the room while you’re still talking.
There are online tools patients can use to see how other people have rated particular doctors.
For example, ProPublica’s Vital Signs API database provides in formation on 1.3 million doctors and other health care profes sionals throughout the country.
The database includes details on the provider’s specialty, location and contact information; standing with federal health programs; office visits and costs; relationships with drug and medical device companies; prescribing patterns and habits; and surgical per formance. Healthgrades, another online tool, has more than 10 million patient ratings and reviews across a wide range of specialties.
Urban suggests not making judg ments based on patient reviews alone. “When people are happy, they don’t always leave comments. I’ve seen some doctors who are great who’ve had many negative comments,” he says. Ask for recommendations from friends and other people in your area, which you can do in online forums.
When considering a new doctor, ask if you can schedule a quick meet and greet. If he is willing to take a few minutes to speak with you, that shows he is invested in listening to you down the road. You could even just drop by the office to get a sense of the environment. If the office is clean and the staff is calm and profes sional, those are signs of a good fit. l
Nationwide Children’s Hospital is a national and global destination for pediatric health care--designed to manage the most complex of diseases and treat the sickest patients.
We build research programs to assure tomorrow’s breakthroughs help children everywhere.
We support the needs of the whole family--whether they come to us from around the corner or around the globe.



We are one of the country’s largest not-for-profit freestanding pediatric health care networks. Our nearly 14,000 hospital staff and 1,600 medical staff have been providing the best possible care since 1892.

The word impossible isn’t spoken here.



Successful aging hinges on at least six factors you can control

IF YOU WANT to see what successful aging looks like, take a look at how Larry Gondelman and Pamela Roddy are doing.
At age 70, Gondelman, a lawyer in Washington, D.C., at tends dozens of concerts a year, from hip-hop to rock and every genre in between. He teaches class es on topics such as the history of rock and roll and tales of songwriters and their works through an organization that offers continuing education classes for seniors. He’s also the “supreme com missioner” of a rigorous weekly pickup full-court basketball game that’s well into its fourth decade. Gondelman competes with law school friends he’s known for more than 40 years as well as some of their sons.
While still active at the law firm, Gondelman’s no longer in the daily grind. He works on bigpicture issues, helping with strategy and ethical questions. “It’s the best,” Gondelman says of this stage of his life. “Every day there’s something ex citing to do.”
Roddy, of Bethesda, Maryland, feels equally en thusiastic. Now 82, she stopped working at age 75, after a long career that started in academia, moved to private scientific research and ended with the federal government, where she worked as an ad ministrator. Now, she plays tennis up to three times a week, takes online Zumba classes, lifts weights at home and is learning to play pickleball. She’s in several book clubs and takes three to four 90-minute continuing education classes a week, on literature, history and economics. Roddy also volunteers at Maryland Responds, helping manage distribution of COVID-19 vaccines and testing programs.
“I’m very happy,” Roddy says. “Retirement has enabled me to more fully enjoy my husband, Jim, my children and grandchildren and many friends. I continue to experience the mental and physical toll from taking care of sick and dying loved ones. However, this toll is partially offset by the knowledge that I am doing the best I can – and the luck of continued good health.”
Increased life expectancy. Gondelman and Roddy are examples of what gerontology experts would call successful aging. Thanks to investments over time in public health, medical care and education, life spans in the developed world have increased dramatically in the past 12 decades, says Dr. Linda Fried, dean of the Columbia University Mailman School of Public Health. She’s also the director of the Robert N. Butler Columbia Aging Center.
In 1900, the average life expectancy for men and women in the U.S. was 47 years, she says. As of the first half of 2020, average life expectancy was nearly 78 years, according to the Centers for Disease Control and Prevention. Life expectancy was 80.5 years for women and 75 years for men.
The idea that living longer necessarily means enduring significant de clines in health has changed in the last two decades, Fried says. “In the last
©
20 years, public health scientists have shown it’s possible to live a long life with health,” she says. “It’s possible to increase your health span as long as your life span. Some decline in health and function is inevitable. But the image that older life is about decrepitude turns out not to be right.”

While some physical and mental slowdown is to be expected with advancing age, research suggests such degradation isn’t as severe as previously thought, says Jennifer Ailshire, an associate professor of gerontology with the Leonard Davis School of Gerontology at the University of Southern California. The expec tation used to be that the course of a person’s life would resemble a graphic in which a person climbs up a set of stairs, gaining in abilities, then hits a peak somewhere before or around middle age. That would be followed by a steady downward spiral in physiological and physical abilities. That belief is outdated. “It’s a para digm shift that’s happened maybe in the last 10 years,” she says. Many baby boomers – people born between 1946 and 1964 – are maintaining good fitness and high levels of cognitive health as they are aging, she says.
This change in expectations about what older life looks like is occurring as the popula tion is rapidly aging. There are about 74 million baby boomers in the U.S. By 2030, all baby boomers will be 65 years or older, according to the U.S. Census Bureau. That year, for the first time, seniors will outnumber children in the U.S., bureau demographers project.
Defining success. In their 1998 book “Suc cessful Aging,” Dr. John W. Rowe and Robert L. Kahn provide a definition of what that en tails, which many experts in gerontology still refer to as a benchmark. Rowe and Kahn define successful aging as: being free of disease or dis ability, maintaining high physical and cognitive abilities, and interacting with others in mean ingful ways.
That doesn’t mean that people who are disabled, homebound, have cognitive deficits or are suffering from chronic and potentially terminal illnesses like cancer or diabetes are “failures,” says Harry “Rick” Moody, a visiting faculty member at Fielding Graduate Univer sity in Santa Barbara, California. Moody has spent decades working in the field of gerontol ogy, and wrote a textbook on the topic.
“No matter what your situation, there are op
portunities for living a meaningful and positive life,” he says. “We should avoid putting people in categories that make it sound like their lives are a ‘failure.’ ” It’s important to keep in mind that aging successfully doesn’t mean you start jumping out of airplanes or bungee jumping in your later years, Moody says. “It doesn’t mean you have all the skills and abilities you had when you were younger,” he explains. “As you get older your memory and hearing will likely get worse. Declinations will happen, but you can compensate. For example, I wear hearing aids.” Moody is 77. “If you compensate, you’ll age successfully. If you don’t, you won’t age successfully.”
Here are six strategies for aging successfully:
1. Don’t feel limited by age. If you’ve enjoyed certain ac tivities throughout your life, continue them, Ailshire says. De pending on your physical abilities, you may have to make some adaptations. For example, if you love singles tennis but have a hard time covering the court by yourself now, switch to doubles. If you’ve always had fun dancing, don’t stop the music. “My grandmother would go out dancing into her 80s,” she says.
2. Keep learning and growing. Adopting new skills and hobbies or developing “encore careers” can help people age successfully, Ailshire says. In particular, learning a new language or how to play a musical instrument can help you maintain your cognitive abilities, research suggests.
If you need to work for financial reasons, you might look for jobs that are challenging in new ways. For example, you might train for a post in a different department at your company, she says. Or, people who have worked a desk job might look for a caregiving role or something in the service industry. Some people develop an encore career in which they hope to use their skills to help make the world better, in fields like education, the environment, social services and the nonprofit arena.
a day or not, make sure you get plenty of walking in each week. Introduce some forms of aerobic exercise, to the point of getting a rapid heartbeat and being out of breath.”
It may be helpful to consult with a personal trainer who can tailor your exercise routine to your physi cal requirements and limits. It’s also important to pay attention to the risks of advancing age, like the possibility of falling.
5. Cultivate social connections. “As we grow older, it’s inevitable that old ties will fray,” Moody says. “People die, move away, get remarried, go in different directions. Adapting is what we need to do.”
Besides staying in contact with the people already in your orbit, that means making new friends. “In particular, cultivate ties with other generations,” he says. “It’s not always easy, but essential. Move on from grieving the loss of what cannot be re stored. Feed the opportunities for connection and look for unexpected opportunities.” They can present themselves through volunteering, mentoring younger colleagues or playing sports.
Gondelman, for example, main tains friendships with younger asso ciates at his law firm, some of whom he met when he ran the firm’s sum mer associates program. He’d some times talk about music with them and introduce them to bands they hadn’t heard of. He’s also friendly with players in his weekly basketball game who are decades younger.
3. Eat a healthy diet. As you get older, your metabolism naturally slows down. Moody recommends consuming more fruits and vegetables and fewer processed foods to maintain your physical and cognitive health. The Mediterranean diet (see Page 99), which emphasizes fresh fruits and vegetables and whole grains, is an eating regimen that fits Moody’s rec ommendations, and is highly touted by many registered di etitians as a healthy and sustainable eating plan.
“Modestly reducing calories can make a difference because belly fat tends to increase with age,” Moody says. Keep an eye on your consumption of sugar, which can lead to weight gain and diabetes, and of salt, which is associated with high blood pressure.
4. Get some exercise. If you’re playing tennis, pickleball or even pickup hoops into your older years, great. If not, try walk ing and some weight training. “Dramatic and heroic exercise is not needed,” Moody says. “Whether you reach 10,000 steps
6. Adapt to losses. Remember, experiencing some cognitive defi cits and physical limitations are to be expected as you age, Moody says. There are lots of practical ways to compensate. For example, if your short-term memory isn’t as sharp as it once was, carry a notebook and write everything down. If your joints aren’t up to full-court basket ball anymore, try half-court games. And always, get enough sleep, so you can be at your best cognitively and physically.
“Adapting to losses doesn’t mean ducking your head or hiding out,” he says. “Creative strategies help. The great pianist Arthur Rubinstein, when he got old, used to deliberately slow down before a fast segment, in order to create the impression of playing faster.” l
This article was written with the support of a journalism fellowship from The Gerontological Society of America, The Journalists Network on Generations and The John A. Hartford Foundation. Castaneda was one of 17 distinguished reporters across the country selected to participate in the Journalists in Aging Fellows Program in 2021.
OU DON’T HAVE to hop on an airplane to enjoy the numerous documented health benefits of a Mediter ranean diet, consistently a standout in the annual U.S. News Best Diets rank ings. (For a wealth of information on the eating plans featured, visit usnews.com/diets.) In fact, you’ll be working with many familiar ingredients, such as pasta. The difference lies in how these ingredients are served – and what they’re partnered with on the plate. Here are a few tips to help you get started:
One of the best things about the Mediterranean diet is that it really isn’t a “diet” at all. Flavor is front and center in this style of eating, which is steeped in a rich culinary and cultural heritage. Medi terranean vegetables in particular steal the show in dishes like Pantescan salad with capers (a flavorful tomato and po tato salad), orecchiette con cime di rapa (pasta with broccoli rabe and chile peppers) or fattoush (a vegetable and pita bread salad).
To give ordinary foods a Medi terranean flair, brighten them with a squeeze of fresh lemon or orange juice, add a drizzle of extra virgin olive oil and season them with a generous handful of fresh herbs. Not only do these ingredients add acidity, richness and inviting aromas, but also they’re a healthy way to season dishes without relying too heavily on salt.
Olive oil is your go to fat. It’s just as appropriate drizzled over vegetable salads as it is as the base of sauteed onions and to matoes. Olive oil is a source of heart healthy monounsaturated fats and polyphenols.
Having a little bit of fat with your meals can help you better absorb the fat soluble vitamins (A, D, E and K) in foods; can reduce the glycemic response of a meal, meaning your blood

sugar won’t spike as much; and can also contribute to sa tiety, so you aren’t immediately hungry again. In one study of more than 90,000 people, those eating more than ½ tablespoon of olive oil per day had a 14% to 17% lower risk of heart disease compared with people who didn’t eat olive oil. The scientists also found that replacing 5 grams per day of butter, margarine, mayonnaise or dairy fat with the equivalent amount of olive oil was linked with a 5% to 7% lower risk of heart disease.


A product labeled “extra virgin olive oil” was naturally extracted (cold processed) with no heat or chemicals and has more of its original flavors and nutrients intact. Extra virgin is the highest-quality virgin olive oil, meeting both chemical (acidity) and sensory (taste and smell) standards set by the International Olive Council.
For the best health benefits, it’s important to store olive oil without exposure to light, heat and oxygen, and to use it before the best-by date on the bottle.
While most Americans gener ally eat enough protein, we tend to over-sample from the meat and poultry categories and fall short on seafood and plant-based proteins like legumes. One easy way to embrace the Mediterranean diet is to have seafood-based meals a few times per week.
Not all fish are created equal in the flavor and texture department. Grilled shrimp and grilled octopus have a pleasant, meaty texture, while salmon can be buttery and almost steak-like in its richness. Pan-fried sardine or salmon patties are also a delicious choice. For an affordable and easy weeknight option, turn to canned or pouched tuna or salmon.
4. Bring on the beans.
There are plenty of plant-based Mediterranean dishes that provide protein. Many popular reci pes feature this combination of protein and fiber, among them pasta e fagioli (an Italian pasta and bean soup) and espinacas con garbanzos (a Span ish dish made of stewed chickpeas and spinach).
Try using lentils in a casserole or vegetarian Bolognese sauce, mixing chickpeas or cannel lini beans into pasta or grain bowls, or choosing hummus or a nut-based trail mix as a snack. Ad ditionally, walnuts and flaxseed offer plant-based sources of omega-3 fatty acids and are important to eat if fish is not frequently on your menu.
5. Find fermented dairy foods.

In the traditional Mediterranean diet, milk spoiled quickly, so it was often enjoyed in small amounts in its fermented form – as yogurt or artisan cheese. Fermented foods are linked with healthy changes to the gut microbiome.


Although dairy is important in a Mediterranean diet, the focus is on quality over quantity. A small amount of a flavorful cheese can be the perfect finishing touch to a mixed green and tomato salad or a warm bowl of wholewheat pasta. Creamy, protein-filled Greek yogurt is de lightful in a breakfast bowl with fresh fruit, mixed nuts and a drizzle of honey. To explore the savory side of yogurt,
make a tzatziki sauce with Greek yogurt, gar lic and fresh herbs and serve it as a dip for fresh or roasted vegetables.
6. Embrace the rest of the lifestyle, too. The base of the Mediterranean diet pyramid we use at Oldways depicts images of people eating together, cooking together and being active to illustrate that these practices are an important part of an overall Mediterranean lifestyle that can help us manage stress and maintain our health. Traditionally, Mediterranean meals were not rushed eat ing occasions in a cubicle or drive-through, but rather were a time for socializing with loved ones. And in places like Italy, Spain and Greece, dinner is often followed by an evening walk. While many people have sacrificed mindful meals in managing their busy lifestyles, the tide may be turning. For some families, the COVID-19 pandemic cre ated space to reclaim mealtime and savor home-cooked recipes with loved ones. No matter where you are, you can take a Mediterranean staycation by embracing the key ele ments of the diet and lifestyle – and be well on your way to better health and well-being. l
Kelly LeBlanc is a registered dietitian and director of nutrition at Oldways, a nonprofit organization that inspires people to rediscover the joys of the old ways of eating.












©
F YOU WANT to build bigger biceps or get an elusive six-pack, strength training is an essential component for making it happen. But even if maxing out your muscle size isn’t your objec tive, strength training might still be the best way to hit your health goals.
“A lot of people believe that if they don’t want to look like a bodybuilder, they shouldn’t perform resistance training,” says Michael Rebold, an associate professor who heads up the integrative exercise science program at Hiram College in Ohio. “So the only form of exercise they do is aerobic –and then they wonder why they’re having trouble making significant improvements in their (overall) health.”
Before your next workout, consider 11 additional science-backed benefits of strength training:
In a 2014 study published in the journal Obesity, Harvard researchers followed 10,500 men for 12 years and found that strength training is more effective at preventing increases in abdominal fat than cardio vascular exercise.
“When people incorporate strength training into their exercise routine, they not only burn calories, but increase lean muscle mass, which stimulates the metabolism,” Re bold says. Muscle mass is a major factor in determining basal metabolic rate, or the number of calories the body burns per day to keep you alive.
Abdominal fat (aka visceral fat) is located in and around the vital organs and is linked to a higher risk of cardiovascular disease. That’s because visceral fat appears to trigger the release of certain proteins and hormones that cause inflammation, which has been shown to damage blood vessels, boost blood pressure and lead to other cardiac problems. Curbing any excess abdominal fat through strength training can certainly improve heart health.
For example, 2013 research published in the Journal of Applied Physiology demonstrated that young men who regularly strength train have better-functioning HDL, or good cholesterol, compared with those who never pump iron. Rebold explains that strength training improves blood pressure and triglyceride levels similarly to car diovascular exercise, but it has an even stronger beneficial effect on HDL.
Rebold says anyone with Type 2 diabetes should incorporate resistance training. Research has shown that, in addition to building muscle, strength training also improves the muscle’s ability to take in and use glucose, or blood sugar.

“In your muscle cells, you have these transporters that pick up glucose from the blood and deliver it to the mus cle cells,” Rebold says. This “improves their functioning to pick up a lot more glucose from the blood and (deposit it) into muscle, thereby decreasing blood sugar levels.”
Visceral fat not only increases the risk of heart disease and diabetes, but it’s also linked to an increased risk of cancer. Research from the journal On cogene published in 2017 showed that visceral fat cells produce high levels of a cancer-triggering protein called fibroblast growth factor-2, or FGF2.
{
Muscle strength may be a better gauge of health than BMI.|

“Having a good muscle base is important for all movement, balance, coordination and injury prevention,” explains Dr. Adam Rivadeneyra, a sports medicine physician with Hoag Orthopedic Institute in Irvine, California. “If a muscle is too weak, it puts more stress on its connecting tendon and (over time) can result in tendinitis.”
Strength training also increases the number and diameter of collagen fibrils in tendons to increase their strength and help prevent injury, according to a 2015 review published in the International Journal of Sports Physical Therapy, a publication of the International Federation of Sports Physical Therapy.
Runner’s high gets a lot of hype, but strength training also improves symptoms of clinical depression and anxiety. Exercise-triggered endorphins may play a role, but strength training also provides an opportunity to overcome obstacles in a controlled, predictable environment, increasing mental resilience, according to findings from Harvard Medical School.
For the greatest anti-anxiety effects, a 2014 review published in the journal Frontiers in Psychology showed that using low to moderately heavy weights that you can lift for at least 10 to 12 reps works best.
It’s time to rethink your stretching routine. By taking your joints through their full range of motion during strength exercises, you can increase that range of motion over time. Results from a 2017 study in the journal Isokinetics and Exercise Science show that strength training improves flexibility in both men and women.
A previous North American Journal of Sports Physical Therapy study from 2006 suggested that eccentric strength exercises may provide the biggest benefit, improving hamstring flexibility twice as well as static stretching. Eccentric exercises are any that emphasize muscle lengthening, rather than shortening. Examples might include the lowering phase of a squat or raising the bar during a lat pull-down, Rivadeneyra says.

Sure, exercise impacts body composition and physique. But research, including a 2013 Journal of Extension study of middle-aged and older women, shows that consistent strength training improves body image and perceived
physical appearance – no matter what the actual aesthetic results.
Improvements in mental health and energy levels, as well as feelings of accomplishment, are the likely catalysts for improved overall body image, according to researchers.
Strong bodies have strong bones, with strength training significantly increasing bone mineral density, Rivadeneyra says. He explains that any weight-bearing exercise in which you’re standing and gravity is pulling down on your body lightly stresses and strengthens the bones and muscles.
Plus, every time a muscle contracts, it pulls on the bones it’s attached to, which stimulates the cells within the bone to produce structural proteins and move minerals into the bone, he says.
For the greatest results, prioritize standing weightbearing, strength-training moves such as squats and lunges. In a 2014 Journal of Family and Community Medicine study, just 12 weeks of strength training with squats increased lower spine and femur (thigh) bone mineral density by 2.9% and 4.9%, respectively.
Boosted brain health Strength training can improve brain power across a person’s lifespan, but the effects are perhaps the strongest in older adults suffering from cognitive decline. In one 2016 study in the Journal of the American Geriatrics Society, when men and women ages 55 through 86 with mild impairment performed twiceweekly weight training for six months, subjects significantly improved their scores on cognitive tests. However, when participants spent their workouts stretching, their cognitive test scores declined.
The key might be getting the blood flowing, Rebold says, noting that high-intensity strength training increases the flow of blood, oxygen and other nutrients throughout the body, including the brain. In the study, adults lifted 80% of their 1RM, or the maximum amount of weight they could lift for one rep. That roughly equates to the amount of weight they could lift for eight reps without breaking form.
One of strength training’s many benefits is a longer life. A 2015 study in The Lancet found that grip strength accurately predicts death from any cause. A 2017 report in Current Opinion in Clinical Nutrition and Metabolic Care suggested that muscle strength and lean muscle mass may serve as better measures of a person’s overall health than body mass index or BMI. l
























These 20 medical centers excel in treating patients with complex diagnoses and those with relatively routine needs. Each is nationally ranked in 9 or more of the 15 Best Hospitals specialties and is rated “high performing” in most or all of 20 common procedures and conditions (see Page 190 and usnews.com/best-hospitals). Honor Roll standing is based on points. A hospital that was ranked No. 1 in all specialties and rated high performing in all procedures and conditions would have received 531 points. The 20 highest scorers qualified for the Honor Roll.
Mayo Clinic Rochester, Minnesota
points
Cedars-Sinai Medical Center Los Angeles, California
points
Langone Hospitals New York, New York 425 points
Cleveland Clinic Cleveland, Ohio
points
Johns Hopkins Hospital Baltimore, Maryland
points
UCLA Medical Center
Angeles, California
points
New York-Presbyterian Hospital-Columbia and Cornell New York, New York
points
General Hospital Boston, Massachusetts
points
Memorial Hospital Chicago, Illinois
points
Stanford Health CareStanford Hospital Stanford, California
points
Barnes-Jewish Hospital St. Louis, Missouri
points
UCSF Health-UCSF Medical Center San Francisco, California
points
Hospitals of the University of PennsylvaniaPenn Presbyterian Philadelphia, Pennsylvania 322 points
Brigham and Women’s Hospital Boston, Massachusetts 317 points
Houston Methodist Hospital Houston, Texas 306 points
Mount Sinai Hospital New York, New York 300 points
University of Michigan Health-Ann Arbor Ann Arbor, Michigan
points
Clinic-Phoenix Phoenix, Arizona
points
University Medical Center Nashville, Tennessee
points
Rush University Medical Center Chicago, Illinois
points
OR MORE THAN three decades, the mis sion of the Best Hospitals rankings has been to help guide patients, in consultation with their doctors, to the right place when they need a high level of specialty care. These are patients whose surgery or condition is complex. Or whose advanced age, physical infirmity or exist ing medical condition limits their options.
Such people account for a small fraction of hospital patients, but they add up to millions of individuals, and many hospitals may not be able to meet their needs. A hospital ranked by U.S. News in cancer, say, is likely to have the expertise and capability to enroll an elderly patient with a metastatic tumor into a clinical trial for an unproven but innovative treatment.
Some community hospitals also can provide access to such experimental therapies. But not all.
The following pages offer hospital rankings in 15 special ties, from cancer to urology. Of more than 4,500 hospitals evaluated by U.S. News this year, only 164 performed well enough to be ranked in any specialty. In 12 of 15 specialties, analysis of objective data from the federal government and other sources generated the main factors determining whether a hospital was ranked. Some kinds of data, such as death rates, are intimately related to quality. Numbers of patients and the balance of nurses to patients are examples of data that are also important, although the quality connection may seem less evident. To capture medical experts’ opinions, we also factored in results from annual surveys of specialist physi
































cians who were asked to name hospitals they consider best in their specialty at handling difficult cases. Hospitals in the other three specialties (ophthalmology, psychiatry and rheumatology) were ranked solely on the basis of the annual physician surveys. That’s because reliable objective data aren’t available for those areas of care.
Based on input from experts and medical studies, we have revised the ranking methodologies over time to make the rankings even more useful to consumers. This year, for example, the obstetrics and gynecology ranking factored in whether each hospital had
completed a U.S. News survey designed to provide the public with more transpar ent information about its maternity care.

Beyond the specialty rankings, we ex panded a set of hospital ratings that give patients information about which hospi tals excel in specific procedures or in caring for patients with certain conditions. New this year are ratings in ovarian cancer sur gery, prostate cancer surgery and uterine cancer surgery. Hospital performance in these areas can be found in the Best Regional Hospitals rankings (Page 190), which combine data from the specialty rankings and the procedures and condi tions ratings to help consumers identify hospitals with expertise in numerous areas of care. More detail is available at usnews.com/best-hospitals.
To be considered for ranking in 11 of the data-driven specialties, a hospital had to meet any of four criteria: It had to be a teaching hospital, or be affiliated with a medical school, or have at least 200 beds, or have at least 100 beds and offer at least four out of eight advanced medical technologies.
The hospitals next had to meet a vol ume requirement in each specialty – a minimum number of Medicare inpatients from 2018 to 2020 who received certain procedures and treatment for specific conditions. A hospital that fell short was still eligible if nominated in the specialty by at least 1% of physicians responding to the expert opinion survey.
At the end of the process, 2,203 hospitals remained candidates for ranking in at least one spe cialty. Each received a U.S. News score of 0 to 100 based on four elements, de scribed below. The top 50 hospitals in each specialty were ranked. Scores and data for the rest are at usnews.com. The four elements and their weights in most specialties are:
Patient outcomes (37.5%). Success at keeping patients alive and getting them home was judged by the proportion of Medicare inpatients with certain condi tions in 2018, 2019 and 2020 who died within 30 days of admission or were dis charged to another health care facility. Both rates were adjusted to account for the severity of patients’ illnesses, the com plexity of their care, and risk-elevating factors such as advanced age, obesity, high
blood pressure and poverty (as reflected by whether they received Medicaid).
A widely used approach to so-called risk adjustment was employed to adjust each patient’s risk in calculating odds of a good outcome. To avoid penalizing in stitutions receiving the sickest patients, we excluded from our analysis patients transferred in from another hospital. A score of 5 indicates the best chance of survival or discharge to home (and 1 the worst) relative to other hospitals.
Patient experience (5%). Most hos pitals are required to assess patients’ satisfaction with their experience using a survey known as the Hospital Consumer Assessment of Healthcare Providers and Systems, or HCAHPS. The score reflects how many patients had a positive overall experience during hospitalization.
Other care-related indicators (30%). The balance of patients per nurse and the hospital’s number of patients – an indica tor of its degree of experience in a spe cialty – are examples of these factors.
Expert opinion (27.5%). Specialists were asked to name up to five hospitals that they consider best in their area of expertise for patients with the most dif ficult medical problems. In the 2022 survey alone, responses were tallied from more than 32,000 physicians. The figures shown under “% of specialists recommend ing hospital” in the tables are the average percentages of specialists in 2020, 2021 and 2022 who recommended a hospital. In rehabilitation, expert opinion carried a weight of 50%. In the three specialties based entirely on expert opinion, a hospital had to be cited by at least 5% of responding physicians in the latest three years of U.S. News surveys to be ranked. That created lists of 12 hospitals in ophthalmology, 11 in psychiatry and 11 in rheumatology.
If you’ve consulted past editions of Best Hospitals, you may notice that a hospital you’re considering has risen or fallen in the rankings. A decline shouldn’t auto matically be interpreted as a decline in performance; rather, it may be because of changes to the methodology or because other hospitals improved.
No hospital, no matter how excellent, is best for every patient. You’ll want to add your own fact-gathering to ours and consult with your doctor or other health professional as you weigh your options. l
CARF: accredited by the Commission on Accreditation of Rehabilitation Facilities International as of April 30, 2022.
Completion of care rate: how often a hospital avoids needing to transfer patients to an acute-care hospital during their rehabilitation.
Discharge to home score: reflects proportion of patients who, at discharge, went home rather than to a nursing home or other facility.
FACT accreditation level: hospital meets Foundation for the Accreditation of Cellular Therapy standards as of March 1, 2022, for harvesting and transplanting stem cells from a patient’s own bone marrow and tissue (level 1) and from a donor (level 2) to treat cancer.
Flu vaccination rate: percentage of hospital’s staff who received a seasonal flu vaccine.
NAEC epilepsy center: designated by the National Association of Epilepsy Centers as of March 1, 2022, as a regional or na tional referral facility (level 4) for staffing, technology and training in epilepsy care.
NCI cancer center: designated by the National Cancer Institute as of March 29, 2022, as a clinical or comprehensive cancer hospital.
NIA Alzheimer’s center: designated by the National Institute on Aging as of Feb. 7, 2022, as an Alzheimer’s Disease Center, indicating high quality of research and clinical care.
Number of patients: except in rehabilita tion, estimated number of Medicare inpatients in 2018, 2019 and 2020 who received certain high-level care as defined by U.S. News. (In some cases, data from 2017 were used to adjust for the pan demic’s impact on 2020 data.) Based on an adjustment to the number of such pa tients with traditional Medicare insurance. In geriatrics, only patients ages 75 and older are included. In rehabilitation, only patients treated in 2020 are included.
A Nurse Magnet hospital: recognized by the American Nurses Credentialing Center as of Jan. 4, 2022, for nursing excellence.
Nurse staffing score: relative balance of nonsupervisory registered nurses (inpatient and outpatient) to average daily number of all patients. Inpatient staffing receives greater weight. Agency and temporary nurses are not counted.
Patient experience: percentage of patients who responded positively to a survey about the overall quality of their stay.
Patient services score: number of services offered out of the number considered important to quality (such as genetic testing in cancer and an Alzheimer’s center in geriatrics).
% of specialists recommending hospital: percentage of physicians responding to U.S. News surveys in 2020, 2021 and 2022 who named the hospital as among the best in their specialty for especially challenging cases and procedures, setting aside location and cost.
Public transparency: indicates whether hospital publicly reports its performance through the American College of Cardiology, the American Heart Association and the Society of Thoracic Surgeons (in cardiology & heart surgery) or the American Heart Association (in neurology & neurosurgery), and whether hospital completed a U.S. News survey about maternity care (in obstetrics & gynecology).
Rank: based on U.S. News score except in ophthalmology, psychiatry and rheumatology, where specialist recommendations determined rank.
Readmission prevention rate: how often hospital keeps patients from being readmitted to an acute-care hospital within the 30 days following discharge.
Successful discharge rate: how often patients go directly home from this hospital and remain at home, rather than requiring further institutional care. Survival score: reflects patient survival rate in the specialty within 30 days of admission.
Technology score: reflects availability of technologies considered important to a high quality of care, such as PET/CT scanner in pulmonology and diagnostic radioisotope services in urology.
Trauma center: indicates Level 1 or 2 trauma center certification. Such a center can care properly for the most severe injuries.
U.S. News score: summary of quality of hospital inpatient care. In most special ties, survival is worth 30%, discharge to home 7.5%, operational quality data such as nurse staffing and patient vol ume 30%, specialists’ recommendations 27.5%, and patient experience 5%.


We bring the cures of tomorrow to the people who need them today.

Lee
Cancer Center
Southwestern Medical Center,
Hutchinson Cancer Center/U. of Washington Med. Ctr.,
Mount Sinai Hospital, New York
Houston Methodist Hospital
Orlando
Beth Israel Deaconess Medical Center, Boston
Rush University Medical Center, Chicago
Huntsman Cancer Institute at the U. of Utah, Salt Lake City

U. of Kentucky Albert B. Chandler Hospital, Lexington
Duncan Comp. Cancer Ctr. at Baylor St. Luke’s Med. Ctr., Houston
Montefiore Medical Center, Bronx, N.Y.
OHSU Hospital-Knight Cancer Institute, Portland, Ore. 57.2
Vanderbilt University Medical Center, Nashville, Tenn. 57.0
UC Davis Medical Center, Sacramento, Calif. 56.8
University of Michigan Health Rogel Cancer Center, Ann Arbor
North Shore University Hosp. at Northwell Health, Manhasset, N.Y. 55.5
Thos. Jefferson U. Hosps.-Sidney Kimmel Cancer Ctr., Philadelphia 55.5
University Hospital, Atlanta
Georgetown University Hospital, Washington, D.C.
Health Fairview U. of Minnesota Medical Center,
Medical Center, Orange, Calif.
University of Kansas Hospital, Kansas City
Medical Center,
Cancer Ctr.-U. of Miami Hosp.
Hill Hospital at Northwell Health,
4,131 1.9
2,108 1.5
6.2%
1.3%
2 8 7.0%
8 1.4%
8 0.3%
2 8 0.2%
2 8 0.5%
1,645 2.1 No 2 8 0.6%
1,443 2.2
2 8 1.3%
1,452 1.8 Yes 2 8 1.0%
866 2.0 Yes 0 8 0.5%
2,716 2.5 Yes 2 8 0.6%
91% 1,780 2.2 Yes 2 8 0.9%
91% 2,379 2.3 Yes 2 8 3.0%
89% 1,621 2.7
2,865 2.7
90% 2,043 2.4
90% 1,933 2.1
2,376 2.2
1,615 2.0
1,055 2.0
2,283
1,633
2 8 0.9%
2 8 3.6%
2 8 0.5%
2 8 1.0%
1.5%
2 8 0.9%
2 8 0.6%
2 8 1.3%
0.5%
0.0%
1.8%
0.6%







When City Ballet of San Diego’s Chiara Valle continued to have agonizing leg pain after a previous hospital misdiagnosed an aggressive bone cancer, she knew she needed a second opinion if she ever wanted to dance again. Chiara turned to Montefiore Einstein to get back to The Washington Ballet, and is now with City Ballet of San Diego. Everyday Montefiore Einstein is helping passionate people keep doing what they love.


 See Chiara’s story at montefiore.org/chiara
See Chiara’s story at montefiore.org/chiara

Thanks to Montefiore Einstein, he’s victorious.







Joseph didn’t just need a new heart right away, he needed a hospital that could perform a bloodless transplant. He was referred to Montefiore Einstein, the only hospital within 800 miles that could save his life.

See Joseph’s story at: montefiore.org/joseph

The American College of Cardiology (ACC) applauds those hospitals and health care facilities that have achieved the HeartCARE Center designation and the work of the HeartCARE Center champions who provide leadership in earning this national distinction.

Each of the institutions demonstrates a commitment to world-class cardiovascular care through community engagement coupled with quality improvement in care delivery as well as implementation of disease and procedure-specific accreditation programs. Additionally, the constant support of many qualified and dedicated physicians and cardiovascular care team members, including credentialed Fellows and Associates of the ACC, is essential to each hospital and facility’s ongoing HeartCARE Center achievement.



We recognize their collaborative efforts, purposeful focus, and passion for excellence in working to deliver exceptional care and optimal outcomes for cardiovascular patients.






Please visit CVQuality.acc.org/HCC to learn how hospitals can achieve ACC’s HeartCARE Center recognition.







Albert Einstein Medical Center
Philadelphia, PA
Yolanda Huertas Nixon, ACNP-BC, CRNP, MSN, AACC
Sumeet Mainigi, MD, FACC
Chester County Hospital
West Chester, PA
Ralph G. Smith, IV, RN, AACC




Timothy Boyek, MD, FACC
Conemaugh Memorial Medical Center
Johnstown, PA
Shannon Boyer, RN, AACC
Cyril Nathaniel, MD, FACC
Hackensack University Medical Center
Hackensack, NJ
Tammy Russo, ACNP, AACC
Michael Lim, MD, FACC
Jersey Shore University Medical Center
Neptune, NJ
Jennifer Heck-Kanellidis, DNP, AACC
Brett Sealove, MD, FACC
JFK University Medical Center
Edison, NJ
Jodelle Gold, ACNP-BC, AACC
Raj Ballal, MD, FACC
Lahey Hospital and Medical Center
Burlington, MA
Shauna Holden, NP-C, AACC
Frederic Resnic, MD, FACC
Lawrence General Hospital Lawrence, MA
Kathy Caredeo, RN, AACC
Sunit Mukherjee, MD, FACC
Ocean University Medical Center Brick, NJ
Jennifer Heck-Kanellidis, DNP, AACC
Ali R. Moosvi, MBBS, FACC
Regional Hospital of Scranton Scranton, PA
Debra Jadick, NP, AACC
Sridhar Sampath-Kumar, MD, FACC
Riverview Medical Center Red Bank, NJ
Jennifer Heck-Kanellidis, DNP, AACC
Shaddy K. Younan, MD, FACC
St. Elizabeth Medical Center
Utica, NY
Stephanie Mathias, CCRN, AACC
Michael W. Kelberman, MD, FACC
Bryan Medical Center
Lincoln, NE
Sarah Schroeder, NP, AACC
John Steuter, MD, FACC
Indiana University Health Methodist Hospital Indianapolis, IN
Andrea Price, CPHQ, RCIS, AACC
Richard Kovacs, MD, MACC
Lutheran Hospital Fort Wayne, IN
Amanda Lutter, AGPCNP-BC, AACC
Vijay Chilakamarri, MD, FACC
Parkview Heart Institute Fort Wayne, IN
Angela Starkey, NP, AACC
Patrick B. Gregory, MD, FACC
Spectrum Health Butterworth Hospital
Grand Rapids, MI
John Mulder, IV, MPAS, AACC
David H. W. Wohns, MD, FACC
AdventHealth Carrollwood
Tampa, FL
Joy Viars, ARNP, AACC
Humberto Coto, MD, FACC
AdventHealth Dade City Dade City, FL
Christy N. Burkhart, BSN, CCRN, RN, AACC
Tun Aung, MBBS, FACC
AdventHealth Ocala
Ocala, FL
Lynn Smith, RN, AACC
Robert Feldman, MD, FACC
AdventHealth Sebring Sebring, FL
James E. Leicht, RCIS, AACC
Deepti Bhandare, MD, FACC
AdventHealth Tampa Tampa, FL
Richard N. Dance, PharmD, AACC
Charles Lambert, MD, PhD, MBA, FACC
AdventHealth Wesley Chapel Wesley Chapel, FL
Allison K. Sutton, APRN, FNP-C, AACC
Asad Sawar, MBBS, FACC
AdventHealth Zephyrhills Zephyrhills, FL
Christy N. Burkhart, BSN, CCRN, RN, AACC
Tun Aung, MBBS, FACC Baptist Health Lexington Lexington, KY
Megan C. Switzer, NP, AACC
Azhar Aslam, MBBS, FACC Baptist Health Paducah Paducah, KY
Blair Lane Brockman, NP, AACC Craig Beavers, PharmD, FACC Bayhealth Medical Center Kent Campus Dover, DE
Benjamin Louis Collins, MBA, BSN, AACC John Shuck, MD, FACC
Baylor St. Luke's Medical Center Houston, TX
Lisa Wall, AGPCNP-BC, NP-C, AACC Emerson Perin, MD, FACC CarolinaEast Medical Center New Bern, NC
Laura Nicole Peters, BS, RT, AACC Alex Kirby, MD, FACC
CHI St. Luke's Health Memorial Lufkin Lufkin, TX
Jamie Huckabee, FNP-C, AACC Ravinder Bachireddy, MBBS, FACC Christiana Care Health Services Newark, DE Jennifer Oldham, MSN, RN, AACC Neil Wimmer, MD, FACC
CHRISTUS Mother Frances Hospital - Tyler Tyler, TX
Jamie Moore, RN, AACC James Hoff, MD, FACC
CHRISTUS Ochsner St. Patrick Hospital Lake Charles, LA
Anna Landry, NP, AACC Michael Turner, MD, FACC
To find a hospital or facility that participates in ACC’s quality improvement


or to find the right hospital to meet
Christus St. Frances Cabrini Hospital
Alexandria, LA
Erika McCormick, BSN, CCRN, AACC
Reymond Meadaa, MD, FACC
Frye Regional Medical Center
Hickory, NC
Seth Call, PA-C, AACC
Vincent Patrone, MD, FACC
Jackson-Madison County General Hospital Jackson, TN
Dylan Wilson, BCPS, PharmD, AACC
John Baker, MD, FACC
King's Daughters Medical Center
Ashland, KY
Kristie Turkey, APRN, AACC
Sandeep Krishnan, MD, FACC Lexington Medical Center West Columbia, SC
Dawn Crumpton, BSN, RN, AACC
Robert Malanuk, MD, FACC
Methodist Texsan Hospital San Antonio, TX
Michael Hendricks, MBA, RN, AACC
Obinna Isiguzo, MBBS, FACC
Mon Health Medical Center Morgantown, WV Denise Palmer, RN, AACC
Bradford E. Warden, MD, FACC
Norton Audubon Hospital Louisville, KY
Robert Rogers, APRN, AACC
Ibrahim Fahsah, MD, FACC
Spartanburg Medical Center Spartanburg, SC
Jennifer Smith, MSN, RN, AACC
Nalin K. Srivastava, MD, FACC
The Hospitals of Providence Sierra Campus El Paso, TX
Laura Wilson, AGACNP-BC, AACC
Edward R. Assi, DO, FACC
WVU Medicine Camden Clark Medical Center Parkersburg, WV Kristina Brooks, DNP, AACC
David A. Gnegy, MD, FACC
Adventist Health and Rideout Marysville, CA
Eric Cooper, BSN, MPA, NE-BC, RN-BC, AACC
Rajinder Singh, MBBS, FACC Rose Medical Center Denver, CO
Lauren Meehan, MSN, AACC
Michael R. Wahl, MD, FACC
Saint Joseph Hospital Denver, CO
Jennifer Lynch, APRN, AACC
Jake Michael Chanin, MD, MS, FACC
Saint Mary's Regional Medical Center Reno, NV
Rachael Coe, RN-BC, AACC
Devang M. Desai, MBBS, FACC
The Medical Center of Aurora Aurora, CO
Linda Pilon, CCRN, MSN, NE-BC, AACC
Nelson A. Prager, MD, FACC
UCHealth Memorial Hospital Colorado Springs, CO
Dawn Lovejoy, RN, AACC
Christopher Manhart, DO, FACC

Clinic-Phoenix
Oak,
University Medical Center,
of Michigan Health Frankel
Jolla Hospitals, La Jolla,
Heart & Vascular Inst.
MedStar
Francis Hospital & Heart Center, Roslyn, N.Y.
CentraCare-St. Cloud Hospital, St. Cloud, Minn.
University of Alabama at Birmingham Hospital
Davis Medical Center, Sacramento, Calif.
Montefiore Medical Center, Bronx, N.Y.
Hosp.
Cleveland Clinic Hillcrest Hospital, Mayfield Heights, Ohio
Duke University Hospital, Durham, N.C.
Ohio State University Wexner Medical Center, Columbus
UCSF Health-UCSF Medical Center, San Francisco 59.9
University Hosps. Harrington Heart & Vascular Institute, Cleveland 59.8
Barnes-Jewish Hospital, Saint Louis
UPMC Presbyterian Shadyside, Pittsburgh
Mount Sinai Morningside & Mount Sinai West Hospitals, New York 58.8
Advocate Christ Medical Center, Oak Lawn, Ill. 58.2
Hackensack U. Med. Ctr. at Hackensack Meridian Hlth., N.J. 58.0
Mayo Clinic-Jacksonville, Fla. 57.8
University of Chicago Medical Center
Morristown Medical Center, Morristown, N.J.
University of Kansas Hospital, Kansas City
VCU Medical Center, Richmond, Va.
New York-Presbyterian Brooklyn Methodist Hospital, Brooklyn
Baylor Scott and White The Heart Hospital, Plano, Texas
88%
12,682 2.1
13,575 2.0
2.0
7,432 2.3
4,075 2.7
15,349 2.5
5,918 1.6
1.1%
8 3.0%
8 0.9%
8 3.4%
8 1.2%
8 1.8%
8 1.0%
8 0.0%
8 1.7%
5 8 0.6%
6 8 0.8%
5 8 0.6%
9,269 2.1 Yes 6 8 6.8%
8,918 2.2 Yes 6 8 1.7%
3,143 2.6 Yes 6 8 2.1%
6,309 2.6 Yes 6 8 1.2%
8,677 2.5 Yes 6 8 3.4%
10,044 2.3 Yes 6 8 2.2%
5,422 2.0 No 5 8 0.5%
9,809 2.7 Yes 6 8 0.2%
86% Yes 7,215 2.8 Yes 5 8 0.6%
95%
93%
3,168 2.8 Yes 6 8 2.5%
4,584 2.3 Yes 6 8 1.4%
12,325 2.1 Yes 5 8 1.0%
6,688 2.1 Yes 6 8 0.5%
4,637 1.9 Yes 6 8 0.8%
5,800 1.4 No 5 8 0.2%
7,253 2.7 Yes 5 8 1.7%
Clinic, Rochester, Minn.
General Hospital,
Langone Hospitals,
York-Presbyterian Hospital-Columbia
Medical Center, Los
Health-UCSF Medical Center,
Medicine-University of Washington Medical
Barnes-Jewish Hospital, Saint Louis
Houston Methodist Hospital
Northwestern Memorial Hospital, Chicago
Cleveland Clinic
Cedars-Sinai Medical Center, Los Angeles
University of Texas MD Anderson Cancer Center, Houston
Mount Sinai Hospital, New York
Montefiore Medical Center, Bronx, N.Y.
Johns Hopkins Hospital, Baltimore
University of Chicago Medical Center
NorthShore University Health System-Metro Chicago 69.5
18 UT Southwestern Medical Center, Dallas 69.5
20 Vanderbilt University Medical Center, Nashville, Tenn. 68.8
Memorial Sloan Kettering Cancer Center, New York 67.8
Brigham and Women’s Hospital, Boston 67.1
Hosps. of the U. of Pennsylvania-Penn Presby., Philadelphia 66.7
Beaumont Hospital-Royal Oak, Mich. 66.2
UPMC Presbyterian Shadyside, Pittsburgh 65.7
UC Davis Medical Center, Sacramento, Calif. 65.4
Tampa General Hospital 65.2
Mayo Clinic-Phoenix 64.5
AdventHealth Orlando 64.4
Mayo Clinic-Jacksonville, Fla. 64.3
Stanford Health Care-Stanford Hospital, Stanford, Calif. 64.3
Yale New Haven Hospital, New Haven, Conn.
Hoag Memorial Hospital Presbyterian, Newport Beach, Calif.
UCHealth University of Colorado Hospital, Aurora
Mount Sinai Beth Israel, New York
State University
of Michigan Health-Ann
Shore University Hosp.
Memorial Medical Center,
29.3%
20.7%
5.2%
7.6%
6.1%
4 8 7.0%
4 8 5.7%
4
6.4%
1.4%
2.4%
8 8.2%
4 8 2.2%
1.9 Yes 4 8 1.7%
1,022 2.3 Yes 4 8 3.9%
85% 2,474 2.5 No 4 8 1.4%
92% 525 2.4 Yes 4 8 9.7%
90% 691 2.3 Yes 4 8 2.2%
90% 1,300 1.6 Yes 4 8 0.4%
93% 637 2.2 Yes 4 8 2.2%
91% 754 2.3 Yes 4 8 4.1%
95% 354 2.4 Yes 4 8 0.6%
92% 781 2.4 Yes 4 8 8.1%
91% 861 2.5 Yes 4 8 5.5%
87% 1,445 2.0 Yes 4 8 0.3%
92% 1,063 2.3 Yes 4 8 2.6%
89% 414 2.7 Yes 4 8 0.2%
89% 1,448 2.6 Yes 4 8 0.5%
96% 417 3.2 Yes 4 8 1.7%
89% 3,132 1.9 No 4 8 0.3%
95% 507 2.8 Yes 4 8 1.9%
2.7 Yes 4 8 1.4%
2.0 Yes 4 8 4.2%
2.5 Yes 4 8 0.4%
2.1 Yes 4 8 6.9%
1.4 No 4
Health Care-Stanford
Medical Center,
Medical Center, Los
Eye and Ear, Massachusetts General Hospital,
Hopkins Hospital, Baltimore
Clinic, Rochester, Minn.
Health-UCSF Medical Center,
Memorial Sloan Kettering Cancer Center, New
University of Michigan Health-Ann Arbor
Vanderbilt University Medical Center, Nashville, Tenn.
Hosps. of the U. of Pennsylvania-Penn Presby.,
OHSU Hospital, Portland, Ore.
New York-Presbyterian Hospital-Columbia and Cornell
Barnes-Jewish Hospital, Saint Louis
MUSC Health-University Medical Center, Charleston, S.C.
Tampa General Hospital
University Hospitals Cleveland Medical Center
Mayo Clinic-Phoenix 78.9
Ohio State University Wexner Medical Center, Columbus 77.2
University of Texas MD Anderson Cancer Center, Houston 76.8
UC San Diego Health-La Jolla and Hillcrest Hospitals, San Diego 75.1
University of Alabama at Birmingham Hospital 74.0
Cleveland Clinic 73.6
UW Medicine-University of Washington Medical Center, Seattle 72.9
UPMC Presbyterian Shadyside, Pittsburgh 72.5
NYU Langone Hospitals, New York 71.4
Brigham and Women’s Hospital, Boston
University of Kansas Hospital, Kansas City
University Hospital, Durham, N.C.
Emory University Hospital Midtown, Atlanta
University of Iowa Hospitals and Clinics, Iowa City
New Haven Hospital, New Haven, Conn.
Hosp. and the Medical College of Wis.,
University Medical Center, Chicago
Medical Center of USC, Los Angeles
2.0
8.4%
7.0%
1.9%
12.7%
14.5%
10.2%
5.3%
No 1.5%
Yes 8.7%
Yes 8.3%
Yes 8.2%
8 Yes 1.9%
8 Yes 3.6%
8 Yes 5.3%
8 Yes 4.8%
219 2.6 Yes 8 Yes 0.7%
471 2.6 Yes 8 Yes 1.3%
285 3.2 Yes 8 No 2.0%
632 2.2 Yes 8 Yes 6.5%
854 1.9 Yes 8 No 6.7%
91% 196 2.1 Yes 8 Yes 2.3%
90% 671 2.3 Yes 8 Yes 2.5%
92% 490 2.4 Yes 8 No 7.3%
91% 321 2.3 Yes 8 No 5.9%
92% 581 2.3 Yes 8 Yes 6.7%
89% 254 2.4 Yes 8 Yes 3.0%
2.4 Yes 8 Yes 2.5%
2.1 Yes 8 Yes 2.7%
211 2.1 Yes 8 Yes 2.5%
696 1.7 No 8 No 2.6%
8 Yes 8.2%
8 Yes 1.1%
8 Yes 0.8%
8 Yes 1.0%
8 Yes
Clinic, Rochester, Minn.
Medical Center,
Medical Center, Los Angeles
Clinic
Langone Hospitals,
Keck Medical Center of USC, Los Angeles
Northwestern Memorial Hospital, Chicago
Houston Methodist Hospital
Clinic-Phoenix
Hopkins Hospital,
San Diego Health-La Jolla
New York-Presbyterian Hospital-Columbia
Mount Sinai Hospital, New York
University of Chicago Medical Center
Hosps. of the U. of Pennsylvania-Penn Presby., Philadelphia 73.9
15 Stanford Health Care-Stanford Hospital, Stanford, Calif. 73.9
17 UPMC Presbyterian Shadyside, Pittsburgh 73.2
18 Massachusetts General Hospital, Boston 72.8
19 Memorial Sloan Kettering Cancer Center, New York 72.4
20 Barnes-Jewish Hospital, Saint Louis 72.2
8
6.6%
8
6.9%
No 16.8%
6.2%
8 Yes 2.5%
8 Yes 5.4%
7 8 No 2.1%
5.1%
2.9%
Yes 5.5%
88% 5,379 2.3 Yes 7 8 Yes 6.1%
90% 3,010 2.3 Yes 7 8 Yes 3.9%
91% 4,510 2.5 Yes 7 8 Yes 5.8%
94% 3,643 2.7 Yes 7 8 Yes 2.7%
5 92% 7,006 2.3 Yes 7 8 Yes 4.2%
5 94% 5,950 2.6 Yes 7 8 Yes 8.3%
5 95% 5,106 2.4 Yes 6 8 No 2.8%
5 90% 6,112 2.5 Yes 7 8 Yes 4.0%
21 Mayo Clinic-Jacksonville, Fla. 72.1 5 5 95% 2,979 2.8 Yes 7 8 No 5.4%
22 UCSF Health-UCSF Medical Center, San Francisco 71.6 5 5 91% 2,890 2.6 Yes 7 8 Yes 5.2%
23 OHSU Hospital, Portland, Ore. 71.5 5 5 91% 2,557 2.2 Yes 7 8 Yes 0.9%
24 Beaumont Hospital-Royal Oak, Mich. 71.3
Jefferson Health-Thomas Jefferson U. Hospitals, Philadelphia 70.8
University of Michigan Health-Ann Arbor 70.8
Brigham and Women’s Hospital, Boston 70.1
St. Francis Hospital & Heart Center, Roslyn, N.Y. 70.1
Duke University Hospital, Durham, N.C.
North Shore University Hosp. at Northwell Health, Manhasset, N.Y.
Baylor St. Luke’s Medical Center, Houston 69.5
University of Texas MD Anderson Cancer Center, Houston 68.7
Israel Deaconess Medical Center,
Baylor University Medical Center,
Queen’s Medical Center,
General Hospital
5 87% 6,372 2.0 Yes 7 8 Yes 0.3%
90% 4,388 2.1 Yes 7 8 Yes 1.8%
92% 4,699 2.7 Yes 7 8 Yes 5.7%
92% 5,029 2.4 Yes 6 8 Yes 4.2%
94% 3,168 2.0 Yes 6 8 No 0.3%
4,303 2.1 Yes 7 8 Yes 4.1%
5,859 2.4 Yes 6 8 Yes 1.1%
3,279 2.0 Yes 7 8 No 1.8%
2.6%
2.0%
1.5%
0.1%
Sinai Hospital, New York
Clinic
Langone Hospitals, New York
Mayo Clinic, Rochester, Minn.
UCLA Medical Center, Los Angeles
New York-Presbyterian Hospital-Columbia
Johns Hopkins Hospital, Baltimore
Northwestern Memorial Hospital, Chicago
Health-UCSF Medical Center, San Francisco
Cedars-Sinai Medical Center, Los Angeles
UC San Diego Health-La Jolla and Hillcrest Hospitals, San
Keck Medical Center of USC, Los Angeles
Mayo Clinic-Phoenix 87.2
Rush University Medical Center, Chicago
Stanford Health Care-Stanford Hospital, Stanford, Calif. 86.6
Massachusetts General Hospital, Boston 86.2
Hosps. of the U. of Pennsylvania-Penn Presby., Philadelphia 85.6
18 Barnes-Jewish Hospital, Saint Louis 84.7
19 Brigham and Women’s Hospital, Boston 84.3
20 UPMC Presbyterian Shadyside, Pittsburgh 83.4
21 University of Michigan Health-Ann Arbor 83.0
22 Houston Methodist Hospital 82.8
23 UC Davis Medical Center, Sacramento, Calif. 81.3
24 North Shore University Hosp. at Northwell Health, Manhasset, N.Y. 80.9
25 Lenox Hill Hospital at Northwell Health, New York 80.6
Mayo Clinic-Jacksonville, Fla. 80.5
UT Southwestern Medical Center, Dallas 80.5
Vanderbilt University Medical Center, Nashville, Tenn. 79.9
29 Yale New Haven Hospital, New Haven, Conn. 79.7
Duke University Hospital, Durham, N.C.
University of Kansas Hospital, Kansas City
OHSU Hospital, Portland, Ore.
Beaumont Hospital-Grosse Pointe, Mich.
Hospital, Oroville, Calif.
Health University Hospital, Madison, Wis.
St. Francis Hospital & Heart Center, Roslyn, N.Y.
University of Alabama at Birmingham Hospital
11,097
16,740
11,055 2.1
5,666 2.5
9 17.9%
9 6.9%
9 3.2%
9 8.8%
9 18.8%
Yes 9 4.0%
Yes 9 10.9%
9 2.3%
9 10.3%
No 7 1.0%
9 4.1%
Yes 9 1.0%
96% 11,756 3.2 Yes Yes 8 2.4%
91% 11,067 2.1 Yes Yes 9 1.7%
94% 14,784 2.7 Yes Yes 9 1.4%
94% 29,068 2.6 Yes Yes 9 5.8%
91% 20,319 2.5 Yes Yes 9 2.6%
90% 21,053 2.5 Yes Yes 9 2.5%
92% 20,817 2.4 Yes Yes 9 1.6%
92% 27,417 2.3 Yes Yes 9 5.0%
92% 16,398 2.7 Yes Yes 9 3.6%
92% 24,767 2.1 Yes No 9 1.3%
89% 11,024 2.7 Yes Yes 9 0.5%
90% 42,128 2.4 Yes No 9 2.2%
89% 18,456 2.9 Yes No 9 0.9%
95% 9,737 2.8 Yes Yes 8 1.5%
93% 11,878 2.2 Yes No 9 0.8%
91% 16,224 2.3 Yes Yes 9 1.2%
86% 39,267 2.0 Yes Yes 9 3.7%
18,031 2.1 Yes Yes 9 5.7%
93% 14,672 2.1 Yes Yes 8 0.6%
91% 7,964 2.2 Yes Yes 9 0.5%
10,177
0.0%
0.0%
2.3%
8 0.0%
15,604
Brigham and Women’s Hospital,
Clinic, Rochester, Minn.
Barnes-Jewish Hospital, Saint Louis
Clinic
University of Alabama at Birmingham Hospital
Johns Hopkins Hospital, Baltimore
Long Island Jewish Med. Ctr. at Northwell, New Hyde Park,
UCLA Medical Center, Los Angeles
Stanford Health Care-Stanford Hospital, Stanford, Calif.
Inova Fairfax Hospital, Falls Church, Va.
NYU Langone Hospitals, New York
New York-Presbyterian Hospital-Columbia and Cornell
Rush University Medical Center, Chicago
UW Health University Hospital, Madison, Wis.
Cedars-Sinai Medical Center, Los Angeles
MUSC Health-University Medical Center, Charleston, S.C.
University of Chicago Medical Center
Lenox Hill Hospital at Northwell Health, New York 77.2
Northwestern Memorial Hospital, Chicago 77.2
20 Vanderbilt University Medical Center, Nashville, Tenn. 76.7
UC Davis Medical Center, Sacramento, Calif. 76.6
21 U. of Michigan Health Von Voigtlander Women’s Hospital, Ann Arbor 76.6
Yale New Haven Hospital, New Haven, Conn. 76.3
UCI Medical Center, Orange, Calif. 75.6
Houston Methodist Hospital 75.1
Beaumont Hospital-Royal Oak, Mich. 74.6
UC San Diego Health-La Jolla and Hillcrest Hospitals, San Diego 74.6
Morristown Medical Center, Morristown, N.J.
Advocate Christ Medical Center, Oak Lawn, Ill.
Hosps. of the U. of Pennsylvania-Penn Presby., Philadelphia 71.3
West Penn Hospital, Pittsburgh
Scripps La Jolla Hospitals, La Jolla, Calif.
University Hospital, Durham, N.C.
Montefiore Medical Center, Bronx, N.Y.
92%
91%
6.8%
10.0%
3.7%
9.6%
1.6%
7.3%
5 9 3.1%
5 9 2.7%
5 9 2.2%
5 9 0.9%
5 9 5.3%
5 9 7.0%
Yes 5 9 1.2%
2.4 No 5 9 0.6%
2.7 Yes 5 9 1.8%
2.0 Yes 5 9 1.3%
90% 270 2.3 Yes 5 9 1.2%
89% 180 2.9 Yes 5 9 4.6%
92% 159 2.0 Yes 5 9 4.9%
91% 173 2.3 Yes 5 9 3.9%
89% 187 2.7 Yes 5 9 1.0%
92% 303 2.7 Yes 5 9 3.7%
86% 467 2.0 Yes 5 9 2.7%
90% 188 2.0 Yes 5 9 1.9%
92% 165 2.1 Yes 5 8 1.0%
87% 275 2.0 Yes 5 9 0.6%
91% 208 2.1 Yes 5 9 2.1%
91% 388 2.1 Yes 5 9 0.2%
88% 446 2.7 Yes 5 9 0.1%
91% 251
5 9 2.4%
5 9 0.1%
5 9 0.7%
5 8 5.3%
5 9 0.5%
Langone Hospitals,
Health-UCSF Medical Center, San
New York-Presbyterian Hospital-Columbia and Cornell
Rush University Medical Center, Chicago
Johns Hopkins Hospital, Baltimore
Mayo Clinic, Rochester, Minn.
Cedars-Sinai Medical Center, Los Angeles
Cleveland Clinic
Mount Sinai Hospital, New York
Northwestern Memorial Hospital, Chicago
Massachusetts General Hospital, Boston
UCLA Medical Center, Los Angeles
Barnes-Jewish Hospital, Saint Louis 81.5
Stanford Health Care-Stanford Hospital, Stanford, Calif. 79.6
Hosps. of the U. of Pennsylvania-Penn Presby., Philadelphia 78.1
15 Houston Methodist Hospital 78.1
17 Long Island Jewish Med. Ctr. at Northwell, New Hyde Park, N.Y. 76.5
5 9 6.4%
5 9 18.1%
5 9 10.7%
5 9 3.4%
5 9 18.3%
Yes 5 9 22.9%
Yes 5 8 1.6%
2.4 Yes Yes 5 9 10.0%
Yes 5 9 2.7%
3,129 2.0 Yes Yes 5 9 4.1%
5,254 2.6 Yes Yes 5 9 16.1%
2,975 3.2 Yes Yes 5 9 6.6%
90% 5,361 2.5 Yes Yes 5 9 5.9%
94% 2,683 2.7 Yes Yes 5 9 4.1%
91% 4,043 2.5 Yes Yes 5 9 5.6%
92% 4,480 2.1 Yes Yes 5 9 1.1%
5 87% 4,848 1.8 Yes Yes 5 9 0.9%
18 Mayo Clinic-Jacksonville, Fla. 75.2 5 5 95% 2,278 2.8 Yes Yes 5 9 4.7%
19 Brigham and Women’s Hospital, Boston 75.1 5 5 92% 4,597 2.4 Yes Yes 5 9 5.5%
20 University of Michigan Health-Ann Arbor 74.2 5 5 92% 2,917 2.7 Yes Yes 5 9 3.3%
21 UC San Diego Health-La Jolla and Hillcrest Hospitals, San Diego 74.0 5 5 91% 2,074 2.1 Yes Yes 5 9 2.3%
22 Lenox Hill Hospital at Northwell Health, New York 73.0 5 5 89% 1,957 2.9 Yes Yes 5 9 1.1%
23 Duke University Hospital, Durham, N.C. 71.6 4 5 91% 4,029 2.1 Yes Yes 5 9 5.6%
24 Emory University Hospital, Atlanta 71.0
University of Miami Hospital and Clinics-UHealth Tower 70.2
5 91% 3,054 2.2 Yes Yes 5 9 3.2%
5 87% 1,097 1.3 Yes Yes 5 9 2.1%
Mayo Clinic-Phoenix 69.8 5 5 96% 1,754 3.2 Yes Yes 5 9 4.2%
Baylor St. Luke’s Medical Center, Houston 69.6
University of Kansas Hospital, Kansas City 69.5
Ohio State University Wexner Medical Center, Columbus 69.3
St. Francis Hospital & Heart Center, Roslyn, N.Y. 69.0
UT Southwestern Medical Center, Dallas 69.0
OHSU Hospital, Portland, Ore. 68.2
Presbyterian Shadyside,
Permanente
Angeles Medical Center
Hospital-Grosse Pointe, Mich.
Orlando
5 87% 3,009 2.0 Yes Yes 5 8 0.6%
5 93% 3,638 2.1 Yes Yes 5 9 0.9%
89% 5,410 2.2 Yes Yes 5 9 2.2%
94% 1,867 2.0 Yes No 5 8 0.2%
93% 2,717 2.2 Yes Yes 5 9 1.8%
0.8%
2.3%
0.4%
No
0.0%

At 57, I gave birth, again.
Not long after losing my child to a brain tumor, I found out

I had 3 brain tumors. Yet, I believed I could rise. I had a team all around me who moved mountains so I could rise.
I’m Barbara Higgins. Every day is a day to rise.
See my story at montefiore.org/Barbara

Celebrating 13 years of being the best Orthopedic Hospital in the nation.
Our great outcomes—the lowest rates of complication, infection, and readmission in the nation—start with putting our patients first. At Hospital for Special Surgery, it’s not just about being #1 in Orthopedics. It’s all the moments that our specialized doctors, dedicated staff, and state-of-the-art facilities can enable for our patients.
Learn more at HSS.edu

Health-UCSF Medical Center,
Health Shands Hospital, Gainesville, Fla.
Hospital-Troy, Mich.
Orthopedic Institute, Irvine, Calif.
University Health System-Metro Chicago
Keck Medical Center of USC, Los Angeles
Lancaster General Hospital, Lancaster, Pa.
North Shore University Hosp. at Northwell Health, Manhasset, N.Y.
Florida Orthopaedic Institute at Tampa General Hospital
Providence Mission Hospital, Mission Viejo & Laguna Beach, Calif.
John Muir Health-Walnut Creek Med. Ctr., Walnut Creek, Calif.
Providence Holy Cross Medical Center, Mission Hills, Calif. 57.0
Johns Hopkins Hospital, Baltimore 56.9
St. Francis Hospital & Heart Center, Roslyn, N.Y. 56.8
Queen’s Medical Center, Honolulu 56.4
UC San Diego Health-La Jolla and Hillcrest Hospitals, San Diego 56.4
Brigham and Women’s Hospital, Boston 56.2
UW Health University Hospital, Madison, Wis. 55.9
Advocate Good Samaritan Hospital, Downers Grove, Ill. 55.6
Hackensack U. Med. Ctr. at Hackensack Meridian Hlth., N.J. 55.6
AdventHealth Orlando 55.4
Penn State Health Milton S. Hershey Medical Center, Hershey, Pa. 55.3
UW Medicine-University of Washington Medical Center, Seattle 55.1
Mayo Clinic-Phoenix
Mount Sinai Beth Israel, New York
UC Davis Medical Center, Sacramento, Calif.
4,158
4,588
1,500 2.5
4,052 1.6
3,891 2.4
2,670 2.6
2 7 2.8%
2 7 0.5%
2 7 0.2%
2 7 1.5%
2 7 0.3%
2 7 2.5%
2 7 0.1%
2 7 0.8%
2 7 2.1%
2,406 2.2 Yes 2 7 0.4%
2,274 2.3 Yes 2 6 0.1%
885 2.3 Yes 2 6 0.0%
92% 1,881 2.4 Yes 2 7 3.7%
94% 1,539 2.0 Yes 2 7 0.2%
92% 2,159 1.5 Yes 1 6 0.0%
91% 1,765 2.1 Yes 2 7 2.2%
92% 3,113 2.4 Yes 2 7 2.9%
92% 2,694 2.4 Yes 2 7 0.8%
89% 1,669 2.2 Yes 2 7 0.1%
86% 2,414 2.8 Yes 2 7 0.7%
89% 9,378 1.9 No 2 7 1.1%
91% 2,093 2.3 Yes 2 7 0.7%
91% 2,228 2.3 Yes 2 7 1.7%
96% 1,919 3.2 Yes 2 7 2.3%
83% 1,063 1.4 No 2 7 0.1%
89% 1,940 2.7 Yes 2 7 1.5%
are explained on Page 113.
The American Orthopaedic
*
AdventHealth Orthopedic Institute, Central Florida Division - Winter Park, FL
Allegheny Health Network (AHN)Jefferson Hospital - Pittsburgh, PA
* Androscoggin Valley Hospital Orthopaedics & Sports Medicine - Berlin, NH
Anne Arundel Medical Group Orthopedics/ Luminis Health - Annapolis, MD
* Atlantic General Hospital - Berlin, MD
AtlantiCare Regional Medical Center - Pomona, NJ
Atrium Health MSKI Fracture Prevention ProgramCharlotte, NC
Atrium Health Wake Forest Baptist Medical Center - Winston Salem, NC
Baptist Orthopedic Hospital at Mission TrailSan Antonio, TX
Berkshire Medical Center - Pittsfield, MA
Bryan Medical Center - Lincoln, NE
Cedars-Sinai Medical Center - Los Angeles, CA
* Central Carolina Orthopaedic AssociatesSanford, NC
CHRISTUS Mother Frances Hospital - Tyler - Tyler, TX
Concord Hospital - Concord, NH
Cooper Health System - Camden, NJ
Crystal Clinic Orthopaedic Center - Akron, OH
* Firelands Physician Group - Sandusky Orthopedics and Pain Management - Sandusky, OH
Froedtert & the Medical College of WisconsinMilwaukee, WI
* Goshen Physicians Orthopedics and Sports Medicine - Goshen, IN
Greater Baltimore Medical Center - Baltimore, MD
Hartford HealthCare Bone and Joint InstituteHartford, CT
Henry Ford Hospital - Detroit, MI
Hoag Orthopedic Institute - Irvine, CA
Huntington Hospital - Northwell HealthHuntington, NY
JPS Health Network - Fort Worth, TX
^
*
Institutions are recognized for at least 75% compliance on at least 5 of the 10 recommended secondary fracture prevention measures over the last year.
KCU/HCA Research Medical CenterKansas City, MO
Lahey Hospital and Medical Center - Burlington, MA
Lexington Medical Center - West Columbia, SC
MaineGeneral Orthopaedics - Augusta, ME
Marshfield Clinic Health System - Marshfield, WI
Medical University of South Carolina - Charleston, SC
Memorial Regional Hospital - Hollywood, FL
Mendelson Kornblum Orthopedic & Spine Specialists - Warren, MI
Michigan Neurosurgical Institute, PCGrand Blanc, MI
Mount Sinai South Nassau - Oceanside, NY
NMC Health - Newton, KS
North Central Baptist Hospital - San Antonio, TX
Northern Light Eastern Maine Medical CenterBangor, ME
* Norton Audubon Hospital - Louisville, KY
* Norton Brownsboro Hospital - Louisville, KY
* Norton Cancer Institute - Louisville, KY
* Norton Hospital - Louisville, KY
Norton Women's and Children's HospitalLouisville, KY
NYU Langone Orthopedic Hospital - New York, NY
NYU Winthrop Hospital - Mineola, NY
OHSU Department of Orthopaedics & Rehabilitation - Portland, OR
Orthopaedic Associates of MichiganGrand Rapids, MI
^Orthopedic Associates of SW Ohio - Dayton, OH
Overlake Medical Center & Clinics - Bellevue, WA Paramount Care, Inc. - Maumee, OH
^Park Nicollet Methodist Hospital/TRIA Orthopaedic Center - Minneapolis, MN
^Prisma Health-Upstate - Greenville, SC
ProMedica Toledo Hospital - Toledo, OH Regions Hospital - St. Paul, MN
Resolute Health Hospital - New Braunfels, TX
^Sanford Medical Center - Fargo - Fargo, ND
*
Sonoran Orthopedics - Scottsdale, AZ
South Texas Fracture Prevention ClinicSan Antonio, TX
Southern Illinois Healthcare Herrin HospitalHerrin, IL
St. Luke's Health System Osteoporosis and Bone Health Program - Boise, ID



Tahoe Forest Health System - Truckee, CA
Tallahassee Memorial HealthCare - Tallahassee, FL
The Bone and Joint Center at AdventHealth Zephyrhills - Zephyrhills, FL
The Bone and Joint Center- Capital Region Orthopaedic Associates - Albany, NY

The Methodist Hospitals, Ortho Spine CenterMerrillville, IN
* University of Cincinnati - Cincinnati, OH
* The University of Texas at Austin -
UT Health Austin - Austin, TX
* TSAOG Orthopaedics and Spine - San Antonio, TX
UnityPoint Health Endocrinology and Midwest Orthopedics - Peoria, IL

University Hospital - San Antonio, TX
* University of Connecticut - Farmington, CT
University of Iowa Hospitals & Clinics - Iowa City, IA
* University of Texas Southwestern Medical Center Dallas, TX
University of Wisconsin Hospitals and ClinicsMadison, WI
UT Health East Texas Orthopedic and Sports Medicine Institute - Tyler, TX
VCU Health - Richmond, VA
West Coast Bone Health & Wellness CenterCamarillo, CA
Wooster Community Hospital Health SystemWooster, OH
^WVU Medicine Department of OrthopaedicsMorgantown, WV
^Yale New Haven Hospital Fragility Hip Fracture Program - New Haven, CT
Mayo Clinic, Rochester, Minn.
National Jewish Health, Denver-U. of Colorado Hosp.,
Cedars-Sinai Medical Center, Los Angeles
NYU Langone Hospitals, New York
UCLA Medical Center, Los Angeles
Cleveland Clinic
Johns Hopkins Hospital, Baltimore
Hosps. of the U. of Pennsylvania-Penn Presby., Philadelphia
UCSF Health-UCSF Medical Center, San Francisco
UC San Diego Health-La Jolla and Hillcrest Hospitals, San Diego
New York-Presbyterian Hospital-Columbia and Cornell
Stanford Health Care-Stanford Hospital, Stanford, Calif. 85.6
Northwestern Memorial Hospital, Chicago 84.5
14 Mayo Clinic-Phoenix 82.2
14 North Shore University Hosp. at Northwell Health, Manhasset, N.Y. 82.2
16 Massachusetts General Hospital, Boston 81.4
17 Mount Sinai Hospital, New York 80.0
18 Houston Methodist Hospital 79.6
18 Vanderbilt University Medical Center, Nashville, Tenn. 79.6
20 Rush University Medical Center, Chicago 79.5
21 UT Southwestern Medical Center, Dallas 79.3
22 Memorial Sloan Kettering Cancer Center, New York 78.5
22 University of Michigan Health-Ann Arbor 78.5
24 Brigham and Women’s Hospital, Boston 77.2
Barnes-Jewish Hospital, Saint Louis 76.2
Keck Medical Center of USC, Los Angeles 76.2
UC Davis Medical Center, Sacramento, Calif. 76.1
Northwestern Lake Forest Hospital, Lake Forest, Ill. 76.0
UPMC Presbyterian Shadyside, Pittsburgh
Yale New Haven Hospital, New Haven, Conn.
Duke University Hospital, Durham, N.C.
University of Kansas Hospital, Kansas City
Beaumont Hospital-Royal Oak, Mich.
Hill Hospital at Northwell Health, New
State University
Medical Center,
Muir Health-Walnut Creek Med. Ctr., Walnut Creek,
4,170
9,764
7,099
5,977 2.4
3,189 2.4
6,758
4,291 2.1
18,065 3.1
6 8 19.5%
6 8 25.3%
6 8 2.8%
6 8 5.1%
6 8 4.9%
6 8 12.6%
6 8 14.4%
6 8 9.0%
6 8 10.5%
6 8 4.6%
6 8 6.9%
4,315 2.7 Yes 6 8 3.1%
92% 4,966 2.0 Yes 6 8 2.3%
96% 4,216 3.2 Yes 5 8 2.8%
90% 11,185 2.4 Yes 5 8 1.6%
94% 7,877 2.6 Yes 6 8 8.4%
88% 8,310 2.3 Yes 5 8 3.9%
92% 7,453 2.1 Yes 6 8 0.7%
91% 4,979 2.3 Yes 6 8 6.0%
91% 3,085 2.1 Yes 5 8 1.0%
93% 4,523 2.2 Yes 6 8 1.7%
95% 4,771 2.4 Yes 5 8 1.2%
92% 5,189 2.7 Yes 6 8 4.8%
92% 5,977 2.4 Yes 6 8 6.5%
90% 6,306 2.5 Yes 6 8 4.2%
92% 1,127 2.5 Yes 6 8 1.4%
89% 4,079 2.7 Yes 5 8 0.7%
91% 1,887 1.9 Yes 5 8 0.1%
7,788 2.3 Yes 6 8 5.3%
13,085 2.0 Yes 5 8 3.3%
5,844 2.1 Yes 6 8 7.7%
5,024 2.1 Yes 5 8 1.0%
1.5%
At National Jewish Health, the nation’s leading respiratory hospital, we bring doctors, scientists and caregivers together to find answers, develop treatments and solve medical challenges. From providing care for adults and children with complications from COVID to addressing the needs of patients with lung, heart, immune and related diseases — our experts work within our communities and across the nation.
Our research breakthroughs improve lives around the world, while our innovative care leads to extraordinary outcomes.
Ranked # 1 or # 2 in Pulmonology on the U.S. News & World Report Best Hospitals list for 26 years.
To learn more or make an appointment, call 800.621.0505 or visit njhealth.org.
Rank Hospital
services score (16=best)
by CARF
of specialists recommending hospital
1 Shirley Ryan AbilityLab, Chicago 100.0 94% 95% 60% 90% Very High 7 16 No 27.7%
2 TIRR Memorial Hermann, Houston 89.7 94% 96% 61% 93% Very High 7 16 Yes 16.5%
3 Spaulding Rehabilitation Hospital, Charlestown, Mass. 84.1 94% 95% 51% 98% Very High 7 16 Yes 19.0%
4 Kessler Institute for Rehabilitation, West Orange, N.J. 80.8 94% 94% 61% 93% Very High 6 12 Yes 14.0%
5 UW Medicine-University of Washington Medical Center, Seattle 75.7 93% 96% 65% 95% Very Low 7 16 Yes 13.4%
6 Mayo Clinic, Rochester, Minn. 71.1 93% 96% 64% 88% Low 7 16 Yes 11.7%
7 Rusk Rehabilitation at NYU Langone Hospitals, New York 70.8 93% 96% 60% 100% High 7 16 Yes 9.9%
8 Shepherd Center, Atlanta* 69.9 NA NA NA NA NA 7 16 Yes 7.6%
9 MossRehab, Elkins Park, Pa. 68.7 93% 95% 62% 99% Very High 6 16 Yes 6.7%
10 UPMC Mercy, Pittsburgh 67.2 94% 95% 60% 99% Very High 7 16 No 5.9%
11 Santa Clara Valley Medical Center, San Jose, Calif. 65.6 94% 96% 71% 90% Very High 7 15 Yes 3.8%
12 New York-Presbyterian Hospital-Columbia and Cornell 64.6 94% 96% 63% 95% Average 6 16 Yes 8.2%
13 Mount Sinai Hospital, New York 62.5 94% 96% 57% 97% Very High 7 16 Yes 4.9%
14 Baylor Scott and White Institute for Rehabilitation-Dallas 62.3 94% 96% 65% 99% Very High 7 15 Yes 1.7%
15 Craig Hospital, Englewood, Colo.* 61.9 NA NA NA NA NA 6 14 No 6.2%
16 Carolinas Rehabilitation, Charlotte, N.C. 61.3 93% 96% 65% 94% Very High 7 16 Yes 3.5%
17 Mary Free Bed Rehabilitation Hospital, Grand Rapids, Mich. 60.9 94% 96% 69% 100% Very High 7 16 Yes 1.7%
18 MedStar National Rehabilitation Hospital, Washington, D.C. 60.5 94% 96% 56% NR Very High 7 16 Yes 3.5%
19 Rancho Los Amigos National Rehab. Ctr., Downey, Calif. 58.0 93% 96% 66% 86% Very High 7 16 Yes 0.9%
20 University of Alabama at Birmingham Hospital 57.7 94% 96% 69% 98% Very High 7 16 No 1.3%
21 WakeMed Health and Hospitals, Raleigh Campus, N.C. 57.2 94% 97% 71% 99% Very High 6 15 Yes 0.6%
22 UW Medicine/Harborview Medical Center, Seattle 56.6 93% 96% 58% 93% Very High 7 16 Yes 3.2%
23 Johns Hopkins Hospital, Baltimore* 55.4 NA NA NA NA NA 7 16 Yes 3.3%
24 MetroHealth Medical Center, Cleveland 54.4 94% 96% 57% 100% Very High 7 16 Yes 1.5%
25 Kaiser Permanente Vallejo Medical Center, Vallejo, Calif. 54.3 93% 96% 77% 78% Very High 6 15 Yes 1.5%
26 Emory Rehabilitation Hospital, Atlanta 54.1 94% 96% 67% 100% Very High 7 16 Yes 2.0%
27 UT Southwestern Medical Center, Dallas 54.0 NR NR NR NR High 7 15 Yes 2.7%
28 Legacy Good Samaritan Medical Center, Portland, Ore. 53.1 94% 96% 73% 93% Very High 6 15 Yes 0.0%
29 Hosps. of the U. of Pennsylvania-Penn Presby., Philadelphia 52.6 94% 95% 63% 100% Very High 7 16 Yes 2.0%
29 Sunnyview Rehabilitation Hospital, Schenectady, N.Y. 52.6 94% 96% 64% 91% Very High 7 16 Yes 0.3%
31 OhioHealth Rehabilitation Hospital, Columbus, Ohio 51.6 94% 96% 63% 97% Very High 7 15 Yes 0.2%
32 WellStar Kennestone Hospital, Marietta, Ga. 51.5 93% 97% 79% NR Average 6 15 Yes 0.0%
33 Ohio State University Wexner Medical Center, Columbus 51.4 93% 92% 58% 96% Very High 7 16 Yes 5.7%
University of Michigan Health-Ann Arbor
Sarasota Memorial Hospital, Fla.
Brooks Rehabilitation Hospital, Jacksonville, Fla.
St. David’s Medical Center, Austin
94% 95% 59% 100% Average 7 15 No 4.0%
94% 96% 66% 95% Very High 7 15 Yes 0.0%
94% 95% 57% 90% Very High 6 16 Yes 0.9%
94% 97% 69% 86% Very High 7 15 No 0.0%
Mayo Clinic, Rochester, Minn.
Clinic
Cedars-Sinai Medical Center, Los Angeles
Memorial Sloan Kettering Cancer Center, New York
New York-Presbyterian Hospital-Columbia and Cornell
University of Texas MD Anderson Cancer Center, Houston
Johns Hopkins Hospital, Baltimore
Keck Medical Center of USC, Los Angeles
University of Michigan Health-Ann Arbor
NYU Langone Hospitals, New York
UT Southwestern Medical Center, Dallas
Northwestern Memorial Hospital, Chicago
Vanderbilt University Medical Center, Nashville, Tenn.
Mount Sinai Hospital, New York
Rush University Medical Center, Chicago
UC San Diego Health-La Jolla and Hillcrest Hospitals, San Diego 76.0
17 UCSF Health-UCSF Medical Center, San Francisco 75.9
18 Barnes-Jewish Hospital, Saint Louis 75.4
19 Mayo Clinic-Phoenix 73.9
20 Long Island Jewish Med. Ctr. at Northwell, New Hyde Park, N.Y. 73.1
21 Hosps. of the U. of Pennsylvania-Penn Presby., Philadelphia 72.5
21 Houston Methodist Hospital 72.5
21 UCLA Medical Center, Los Angeles 72.5
24 New York-Presbyterian Brooklyn Methodist Hospital, Brooklyn 72.1
25 North Shore University Hosp. at Northwell Health, Manhasset, N.Y. 71.7
Duke University Hospital, Durham, N.C. 71.2
UW Medicine-University of Washington Medical Center, Seattle 71.2
Brigham and Women’s Hospital, Boston 70.6
University of North Carolina Hospitals, Chapel Hill 70.5
30 Stanford Health Care-Stanford Hospital, Stanford, Calif.
Hackensack U. Med. Ctr. at Hackensack Meridian Hlth., N.J.
Oroville Hospital, Oroville, Calif.
University of Chicago Medical Center
UPMC Presbyterian Shadyside, Pittsburgh
Memorial Hospital, Fla.
Jefferson Health-Thomas Jefferson U. Hospitals,
University Hospital, Atlanta
St. Luke’s Medical Center,
1,756 1.9
1,059 2.4
1,039 2.5
1,214 2.2
6 9 20.8%
6 9 23.6%
6 9 1.4%
6 8 8.0%
6 9 6.3%
6 9 7.5%
6 9 15.2%
6 9 5.9%
6 9 7.5%
6 9 5.5%
6 9 4.1%
1,435 2.0 Yes 6 9 3.3%
91% 1,111 2.3 Yes 6 9 6.9%
1,414 2.3 Yes 6 9 4.5%
91% 363 2.1 Yes 6 9 1.3%
91% 655 2.1 Yes 6 9 2.2%
91% 746 2.6 Yes 6 9 9.4%
90% 783 2.5 Yes 6 9 2.1%
96% 722 3.2 Yes 6 8 3.7%
87% 1,665 1.8 Yes 6 9 1.5%
91% 1,080 2.5 Yes 6 9 3.0%
92% 980 2.1 Yes 6 8 1.5%
93% 793 3.2 Yes 6 9 10.9%
88% 505 1.4 No 6 9 0.1%
90% 871 2.4 Yes 6 9 1.2%
91% 988 2.1 Yes 6 8 5.3%
91% 910 2.3 Yes 6 9 3.3%
92% 902 2.4 Yes 6 9 2.5%
91% 827 1.7 Yes 6 9 2.4%
674 2.7 Yes 6 9 3.3%
86% 947 2.8 Yes 6 9 2.8%
78% 388 1.3 No 6 9 0.2%
866 2.3 Yes 6 9 1.9%
1.7%
0.0%
1.8%
1.3%
These hospitals
the best in their specialty
particularly challenging patients, in the view of at least 5% of medical specialists surveyed by U.S. News over the past three years.
RankHospital
% of specialists recommending hospital
1 Bascom Palmer Eye Institute-U. of Miami Hosp. and Clinics, Miami 39.7%
2 Wills Eye Hospital, Thomas Jefferson U. Hospitals, Philadelphia 36.6%
3 Wilmer Eye Institute, Johns Hopkins Hospital, Baltimore 26.6%
4 Mass Eye and Ear, Massachusetts General Hospital, Boston 22.9%
5 Stein and Doheny Eye Institutes, UCLA Med. Ctr., Los Angeles 17.8%
6 Duke University Hospital, Durham, N.C. 11.7%
7 University of Iowa Hospitals and Clinics, Iowa City 11.0%
8 University of Michigan Health Kellogg Eye Center, Ann Arbor 8.1%
9 UCSF Health-UCSF Medical Center, San Francisco 6.2%
10 John A. Moran Eye Ctr., U. of Utah Hosps. & Clinics, Salt Lake City 5.9%
11 Cole Eye Institute, Cleveland Clinic 5.7%
12 New York Eye and Ear Infirmary of Mount Sinai 5.3%
RankHospital
% of specialists recommending hospital
1 McLean Hospital, Belmont, Mass. 18.9%
2 Johns Hopkins Hospital, Baltimore 17.6%
3 Massachusetts General Hospital, Boston 17.0%
4 New York-Presbyterian Hospital-Columbia and Cornell 13.1%
5 UCSF Health-UCSF Medical Center, San Francisco 9.3%
Resnick Neuropsychiatric Hospital at UCLA, Los Angeles 8.5%
Mayo Clinic, Rochester, Minn. 6.2%
Yale New Haven Hospital, New Haven, Conn. 6.1%
Sheppard Pratt Hospital, Baltimore 5.3%
Menninger Clinic, Houston 5.2%
NYU Langone Hospitals, New York 5.2%
RankHospital
% of specialists recommending hospital
Johns Hopkins Hospital, Baltimore 34.9%
Cleveland Clinic 24.6%
Hosp. for Special Surgery, NY-Presby. U. Hosp.-Columbia & Cornell 21.9%
Mayo Clinic, Rochester, Minn. 21.0%
Brigham and Women’s Hospital, Boston 15.5%
Massachusetts General Hospital, Boston 12.9%
NYU Langone Hospitals, New York
UCSF Health-UCSF Medical Center, San Francisco 10.5%
UCLA Medical Center, Los Angeles 9.4%
University of Alabama at Birmingham Hospital
UCHealth University of Colorado Hospital, Aurora 5.2%

Once again, we’re honored to be named one of just 10 children’s hospitals nationwide on the 2022–23 U.S. News & World Report Best Children’s Hospitals Honor Roll. Stanford Children’s Health is also ranked the No. 2 children’s hospital in the Pacific region and top-ranked in Northern California. This distinction demonstrates the enduring pursuit of excellence and exceptional quality that our faculty, physicians, and staff commit to patients and families. With our network of 65+ Bay Area locations, our patients can access this same great care close to home.



For kids and teens with chronic COVID, comprehensive clinic care can be tough to find
by Chelsea Cirruzzo ©
MORGAN RANDALL’S family thought they’d dodged a bullet. The then15-year-old’s symptoms were mild when she got COVID-19 in Decem ber 2020 – no fever, but the Massa chusetts teen lost her sense of smell and taste and had a sore throat. The family went into quarantine, and five days later, Morgan felt better, passing time by joining her dance team over Zoom from her bedroom.

“I was completely fine,” she says. “I felt, like, normal.”
Winter break rolled around and Morgan took a breather from school and dancing. When she returned, something had changed. During more intense dance sessions, she was short of breath and her legs, strong from years of tap dancing and pirouettes, were tired and weak. Both Morgan and her mom, Jessica, figured she was still recover ing from COVID-19, but by mid-February 2021, the symptoms weren’t letting up. Morgan could no longer make it through her usual solo. Scared, they turned to a pe diatrician who quickly pulled Morgan from dance – an activity she’d done since she was 3 – out of fear that her heart was inflamed.
“I was just confused because I was like, ‘Why is my body giving up on me?’ ” says Morgan, now 17.
Morgan is among an unknown number of children and teens who have signs of long COVID, which is often characterized by fatigue, malaise, shortness of breath and other symptoms that persist or surface anew after an initial bout with COVID-19. In 2021, the National Institutes of Health launched an initiative to study long COVID, and the Centers for Disease Control and Prevention unveiled guidance for treating patients with post-COVID conditions.
But with much still to be learned about long COVID in adults – who are more likely to die or develop severe illness from COVID-19 – researchers also know very little about long COVID in chil dren, particularly when it comes to who is getting it and how best to treat them. While a number of long COVID clinics have cropped up around the country to treat adults through a system of coordinated, multidisciplinary care, pediatric clinics remain relatively limited, meaning plenty of children and their guardians must navi gate a patchy treatment landscape and long wait times.
Research on pediatric long COVID is still in its infancy, but experts stress that more studies are sorely needed.
MORGAN RANDALL, 17, COMPLETES
A SOLO ON THE COMPETITION STAGE IN MAY 2022

A FEAT SINCE BECOMING ILL WITH LONG COVID.
Dr. Dan Cooper, a pediatric pulmonologist and professor of pediatrics at the University of California-Irvine, says that while children don’t tend to get as severely ill from COVID19 as adults, they’re still getting sick, and some are developing long-term symptoms, such as fatigue and shortness of breath. What’s more, he says the “relatively slow rate” of COVID vaccination among younger kids renders them more vulnerable to infection – and thus, long COVID.
Although long COVID doesn’t appear to be as common in kids as it is in adults, the science on pediatric long COVID is steps behind where it is in adults, explains Dr. Sean O’Leary, vice chair of the American Academy of Pediatrics Committee on Infectious Diseases.
Cooper says studies on pediatric long COVID need to focus on
several groups in particular: kids who had asymp tomatic or mild cases of COVID-19, those who were hospitalized and those who experienced multisystem inflammatory syndrome, or MIS-C – an uncommon but serious condition in which parts of the body like the brain, heart, lungs or eyes become inflamed. More than 8,600 patients in the U.S. as of late June 2022 had met the criteria for MIS-C, which can lead to post-COVID conditions, according to the CDC. At least 70 patients have died of MIS-C.
O’Leary says treatment for pediatric long COVID should focus on the specific needs of children, par ticularly on keeping them active through approaches such as physical therapy.
“One of our goals is to try to keep kids from get ting into sort of this vicious cycle of deconditioning” in which they’re so fatigued, they “don’t want to do anything,” O’Leary says. Research must explore the
















The American College of Cardiology (ACC) recognizes these Health Systems for their commitment to drive preeminent hospital care for heart patients. Participating in the ACC’s proven quality care delivery and outcomes programs demonstrates their commitment to better lives for healthier tomorrows.

Baylor Health Care System
Sentara Healthcare

Ballad Health System
Banner Health
Baptist Memorial Healthcare Corporation
BJC HealthCare
Christus Health System
Hendrick Health
Legacy Health
University of California Health System
Kaiser Permanente
Orlando Health
Lehigh Valley Health Network

Memorial Health System of California

Methodist Healthcare
MultiCare Health System
Northside Hospital System
Northwell Health

PeaceHealth
Yale New Haven Health
Mayo Foundation for Medical Education and Research
ProMedica Health System, Inc.

Quorum Health Corporation




Singing River Health System
SSM Health Care
St. Luke’s University Health Network
University of Colorado Health
University of Louisville Health, Inc.
Wellstar Health System

commonality of symptoms among kids with long COVID to help tailor future treatments, he adds.
For Breanna “Bree” Saligumba, an 11-year-old from California who loves soccer and track, ongoing symptoms since getting COVID-19 in March 2020 have caused her to miss school several times a month, says her mom, Marci. Bree is dealing with every thing from nerve pain, body tremors and difficulty breathing to inflammatory arthritis and fainting spells.
On a good day, Bree is the fastest girl on her soccer team, and has clocked running speeds on par with high school track athletes. But when her long COVID symptoms flare up, Bree struggles to play and tires easily. “I can’t stand anymore and it feels like I can’t move anymore and it hurts really bad,” she says.
Bree has been to the emergency room and urgent care so many times the family has lost count. In March 2022, Bree was rushed to the hospital by ambulance after she was found unresponsive on the school’s blacktop.
To manage her symptoms, Bree gets physical therapy, acu puncture and chiropractic care. She also uses several inhalers and painkillers. Although she is vaccinated, Bree contracted COVID-19 for a second time in May 2022.
Marci says Bree’s pediatrician helped coordinate much of her daughter’s care, sending the pair to multiple hospitals where Bree is seeing a rheumatologist, cardiologist, allergist and pain specialist.
“Her doctors are doing everything they can, but this virus is so new, there’s still things they need to learn,” Marci says.
One model for helping kids with long COVID takes a multi disciplinary approach to care, using a clinic as a hub that can connect patients to specialists all working together. But the availability of such clinics is lacking for youth.
That could be because the doctors running programs like these may simply have more experience working with adults, O’Leary says.
“It depends where you are, and it depends on the comfort level of the clinicians running the clinic,” he says.
It’s a challenge Jessica Ran dall, in Massachusetts, says she faced early in seeking out care for Morgan.
the idea came after he began seeing a pattern in early 2021: Kids who pri marily had mild COVID-19 infections in 2020 were coming back for care. Given the prevalence of long COVID in adults and the fact that more than 4 million children had tested positive for COVID-19 at that time, he began to wonder: Could there be thousands of kids with long COVID out there? (At least 14 million children have tested positive for COVID-19 since the pan demic began.)
Michigan Medicine wanted to be prepared, so the health system began building a model involving experts in areas such as pulmonology, cardiol ogy, physical rehabilitation and psy chology, he says.

Of the more than 100 kids who’ve been seen by the clinic, many are over age 10, most are in their teens and sev eral have had persistent symptoms for over a year. Very few had severe COVID19 symptoms initially, though a good number of patients lost their sense of smell and taste, Lumeng says. The clinic currently requires a referral from a pri mary care physician or a pediatric sub specialist for an appointment.
“I’d say the most prominent feature that we see is shortness of breath, chest pain – which again I think mirrors what is seen in adults,” Lumeng says. Many of the clinic’s patients are also active in sports and discovered their lingering conditions once they tried to take part again. These patients, Lumeng
“When we first started look ing, I contacted a couple of hos pitals in Boston and they said, ‘We’re so sorry but we can’t see her because we’re not licensed to see pediatric cases,’ ” she says. Jessica recalls being on the phone daily with Morgan’s pediatrician trying to find options.
“I was doing my own research and legwork and our pediatri cian was kind of sending the referrals,” she says. “There really wasn’t a place to collectively be seen.”
There are exceptions. Michigan Medicine, for example, opened a pediatric clinic in 2021 at C.S. Mott Children’s Hos pital in Ann Arbor. Clinic leader Dr. Carey Lumeng, a pediatric pulmonologist and professor at the University of Michigan, says
says, have been responding to asthma treatment, even if they’ve never previously had asthma.
Meanwhile, many kids with chest pain show no evidence of a lung or heart problem, he adds. That’s not unlike Bree, who says the inhalers she’s received have helped her play again. “I can run a little bit lon ger,” she says, “and actually get some goals.”
Lumeng estimates there may be just 10 or so pe diatric long COVID clinics in the U.S., though an international consortium “is trying to get a handle” on the condition while developing key measures to
help make research across centers possible, he says. Still, it’s hard to find pediatric doctors with experi ence managing fatigue, loss of smell or even chest pain, he adds.
“So, you have to make sure you have a multi disciplinary team and have somebody to take the reins to at least triage,” Lumeng says. Otherwise, patients are seeing multiple disconnected special ists who don’t know all that’s going on, he adds.
At the Kennedy Krieger Institute in Baltimore, which also launched a long COVID clinic for kids, that multidisciplinary approach is key. The clinic features a team that includes experts in physical therapy and behavioral health, as well as an edu cation specialist, since several patients are having difficulties in school.
Because long COVID is often a constellation of symptoms, patients and families find it helpful to have an interdisciplinary team, says Dr. Laura Malone, a pediatric neurologist and clinic co-direc tor. The task of tackling each symptom individually can be daunting and frustrating otherwise.
Working together allows team members to bring different perspectives to the table, enabling the development of a cohesive treatment plan for the patient at the end of the visit, she says.
For Morgan, seeing specialists who get her needs has been huge. She saw a physical therapist virtually,
who helped her with breathing exercises. Morgan’s also seen a pulmonary specialist who diagnosed her with exercise-induced asthma. After a heart screen ing came back normal, she was gradually able to return to dance. In early 2022, when Morgan was finally well enough to finish a solo on the competi tion stage – a first since becoming chronically ill – she cried tears of relief, her mom recalls.
While she’s not 100%, Morgan, now vaccinated, is feeling much better, despite a second bout of COVID-19 in 2022. The only lingering symptoms she has are fatigue and brain fog, particularly if she overdoes it. Even so, she worries about her future. “I’m very competitive,” she says. “Will I ever be able to dance the same again? It’s kind of scary.”
For Jessica Randall, Morgan’s mom, the entire process has been frustrating. She says it took eight weeks to first get Morgan into various specialists’ of fices. She’s aware of a post-COVID clinic with Boston Children’s Hospital, and has an appointment on the books to dig deeper into Morgan’s persistent fatigue.
Meantime, she wants to see more pediatric clinic options come online to better treat kids during what can be a scary period of limbo.
“To some people, eight weeks doesn’t seem like a long time,” she says. “But when it’s your child and you’re not sure what’s wrong, and you don’t know if her heart is inflamed, it’s a long time to wait.” l

The pandemic has dealt a major blow to youth mental health
by Steven Ross Johnson©
OVERNMENT analyses are provid ing a troubling look at how Ameri ca’s youth have suffered during the COVID-19 pandemic.
One examination of data from a nationally representative survey of high school students taken during the first half of 2021 found that 37% of students said they experienced poor mental health either most of the time or always during

the pandemic, with more than 31% of students saying they’d struggled in the past 30 days.
At least 44% of students reported feeling persistently sad or hopeless over the past year, with nearly 20% say ing they’d seriously considered suicide; 9% reported at tempting suicide during that time period.
The analysis was one of several research studies pub lished in April 2022 by the Centers for Disease Control and Prevention.
The mental health of children is public health crisis.” important conversations. alking to our kids, and to each of the best ways to address any challenge On Our Sleeves movement for children’s mental health – is committed to breaking the stigma, giving kids a voice, starting important conversations – and keeping them going. ee, expert-developed resources are ready for you OnOurSleeves.org/
an urgent other, is one facing families. – the .


*U.S. Surgeon General Youth Mental Health Advisory, 2021















tent feelings of sadness and hope lessness compared with 37% of students who identified as hetero sexual. More than a quarter of gay, lesbian and bisexual students said they attempted suicide in the past 12 months, compared with just 5% of heterosexual students.

A companion analysis also found that more than half of students reported experiencing emotional abuse by a parent or other adult in the home during the pandemic –such as being insulted or sworn at –while 11% said they were physically abused. Roughly 29% experienced a parent or adult in their home los ing a job amid the pandemic.
“These data echo a cry for help,” Dr. Debra Houry, the CDC’s acting principal deputy director, said in a state ment. “The COVID-19 pandemic has created traumatic stressors that have the potential to further erode students’ mental well-being. Our research shows that surrounding youth with the proper support can reverse these trends and help our youth now and in the future.”
Notably, feeling connected to others at school influ enced whether students reported experiencing poor mental health. Stronger social ties seemed to help shield kids from suicidal thoughts or attempts. Even a virtual sense of social connectedness to family and friends through phones or computers offered a buffer, the researchers found.
“Comprehensive strategies that improve connections with others at home, in the community, and at school might foster improved mental health among youths dur ing and after the pandemic,” the researchers wrote.
Unequal toll. A particularly large disparity in men tal health status was observed between heterosexual students and those who identified as lesbian, gay or bisexual. More than three-quarters of lesbian, gay and bisexual high school students reported having persis
Extreme stress. Additional find ings showed that about 1 in 3 stu dents reported using illicit drugs and alcohol more than they had before the pandemic, and that ap proximately one-third of students reported being treated badly or unfairly in school due to their race or ethnicity in their lifetime. About two-thirds of Asian students and more than half of both Black and multi racial students said they experienced what researchers called “perceived racism.”
The findings offer additional evidence pointing to a worsening mental health crisis among America’s youth. Data predating the pandemic, for example, found that persistent feelings of sadness and hopelessness among high school students increased by approximately 40% from 2009 to 2019.
“Young people and their families have been under in credible levels of stress during the pandemic,” Kathleen Ethier, director of the CDC’s Division of Adolescent and School Health, said in a spring 2022 call with reporters. “Our data exposes cracks and uncovers an important layer of insight into the extreme disruptions that some youth have encountered.”
Dr. Jonathan Mermin, director of the National Center for HIV, Viral Hepatitis, STD, and TB Prevention, said the pandemic’s impact on youth mental health will be felt well after the outbreak itself is over. “Together,” he said, “we can mitigate its negative effects, increase health equity and create a healthier future for all youth.” l



With world-class cancer and blood disorder programs only minutes away, kids can still feel like kids.





The Pediatric Hematology and Oncology Program at Rutgers Cancer Institute of New Jersey and RWJBarnabas Health provides top-tier care for your child’s type of cancer and blood disorders right here in our own community. As the state’s only National Cancer Institute-designated Comprehensive Cancer Center, we provide access to the most advanced therapies and clinical trials. Our Center for Pediatric Cancer and Blood Disorders Research is at the forefront of developing innovative treatments with fewer side effects. With nationally recognized children’s hospitals and programs close by, patients can spend less time traveling for treatment, and more time being kids. Learn more at rwjbh.org/PediatricCancerandBloodDisorders
NCI
Let’s beat cancer together.Let’s beat cancer together.

As in adults, the microbiomes of children are important for their good health
 by Arlene Weintraub
©
by Arlene Weintraub
©
LYNZIE SMITH, A 34-YEAR-OLD mother of three, breast fed her newborns for more than six months and stuck to a low-fat diet high in fruits and vegetables during all of her pregnancies. Now she’s passing on her healthy eating habits to her 7-year-old son and two daughters, ages 5 and 2. She and her husband regularly serve their children plant-based protein smoothies made with fruits and vegetables, and then they get creative to persuade the children to drink the healthy shake.
“We tell them if they drink it, they’ll get big muscles like the Hulk,” says Smith, of Hastings, Michigan. “Or we tell them if they eat all their fruit and vegetables, they’ll be able to wrestle their dad. Their goal is to try to be stronger than their dad.”
Unbeknownst to Smith, she’s also strengthening the vast networks of bacteria that live in her children’s digestive tracts. The human body contains trillions of microbes that play a key role in moderating important functions like immunity, metabolism and brain function. In fact, an improper balance of good and bad bacteria in the gut has been tied to an increased risk of several disorders, includ ing obesity, asthma and allergies.
Recent advances in gene sequencing have allowed researchers to unravel the ge netic codes of many of the bacteria in the gut, and to link those microbes with the roles they play in maintaining good health. As microbiome science advances, scien tists are learning more about how everyone can adopt habits that will boost levels of beneficial bacteria in the body while keeping the bad bugs at bay.
Smith’s OB-GYN, Dr. J. Daniel Woodall of Spectrum Health Pennock in Michi gan, hasn’t mentioned the term “microbiome” to her. But much of his advice has cen tered around establishing a diet and lifestyle that contribute to healthy gut bacteria, both for her and her children. “The infant microbiome mirrors that of the mother for three to six months,” he says. “We know a healthy diet leads to healthy gut flora,
and that breast milk has good bacteria.”
Indeed, research shows that the road to a healthy microbiome starts before birth. Several studies have found that a mother’s fat intake can influence the establishment of good bacteria in her baby’s microbiome, for example. Researchers at Baylor Col lege of Medicine and Texas Children’s Hospital in Houston studied 162 pregnant women and their newborns and found a tight correlation between the amount of fat in the diet during pregnancy and the depletion of some strains of healthy bac teria in the babies’ guts. Specifically, a diet consisting of 35% or more of fat led to a stark reduction in Bacteroides, bacteria that may influence immune system devel opment and inflammation. The impact of Mom’s diet on the microbiome of her baby can persist as long as six weeks after birth.
There hasn’t been enough research in people to determine exactly what the con sequences of that might be, but in nonhu man primates, that shift in the microbi ome causes newborns to be vulnerable to later obesity, insulin resistance and metabolic syndrome, says the study’s lead author, Dr. Kjersti Aagaard, a pro fessor at Baylor College of Medicine and Texas Children’s. “Just how much of that is reversible we don’t know,” she adds.
After birth, the evidence of breast feeding’s benefits to the microbiome continues to build. In 2020, Harvard researchers published a study in the journal Nature showing that mouse mothers pass on protective antibodies to their offspring via both the placenta and milk. That protects them from diseasecausing bacteria like E. coli.
Although further studies need to be done to confirm that the same phenom enon occurs in people, it could explain why mother’s milk is so beneficial, says Dr. Dennis Kasper, lead author and pro fessor of medicine and immunology at Harvard Medical School. “It’s long been thought that many antibodies against in fections have to come from the mother’s blood, passed across the placenta. But we saw clear protection against infection from just breast milk.”
Protecting the good. There’s grow ing suspicion that use of antibiotics early in life may be one explanation for the prevalence of childhood obesity – that wiping out the good bugs along with the
bad may change the microbiome in a way that predisposes children to the condi tion, as well as to others. In a 2019 study, a research team from the Uniformed Ser vices University in Bethesda, Maryland, studied the records of infants born be tween 2006 and 2013 and found a high association between antibiotic use dur ing the first two years of life and later development of obesity.
A subsequent study from the team found that children prescribed antibiot ics in their first six months were more apt to develop allergies or asthma later in life than were those who didn’t receive the drugs. Those who took more than one type of antibiotic faced a higher risk. The overall increase in risk ranged from 8% for food allergies to 47% for asthma. And in another study published in April 2022, the team found that kids who were pre scribed antibiotics in the first two years of life had a 71% in creased risk of being treated for psychiatric disorders later on in childhood.
That’s not to say parents should avoid giving antibiotics to their children to treat con firmed bacterial diseases, says Dr. Cade Nylund, professor of pediatrics at the Uniformed Services University and co-author of both studies. But they should make sure the drugs are truly needed.
“The most common indication for an tibiotics prescriptions in infants is upper respiratory infections, primarily ear in fections,” Nylund says. “However, a lot of times, parents come in with an infant who has a fever but no clear indication of an ear infection, and as a precaution, an tibiotics are given. Maybe we shouldn’t be doing that.”
When babies are born prematurely, they almost always receive antibiotics to protect against potentially deadly infec tions. Now some physicians are rethink ing that practice, including those who treat preemies at St. Louis Children’s Hospital. They were disturbed by a 2019 study from Washington University School of Medicine in St. Louis suggesting that antibiotics cause long-lasting damage to the gut microbiome.
The researchers found that 18 months after babies were discharged from the

neonatal intensive care unit, those who received antibiotics had more bacteria that can cause serious diseases than did healthy full-term babies. What’s worse, those bugs had grown resistant to an tibiotics. That’s a problem for the developing microbiome, says lead author Gautam Dantas, professor of pathology and immunology and molecular microbiology at Washington University School of Medicine.
“The microbiome and all of its important action is happen ing at exactly the same time in these (premature infants) as you’re bombarding them with the exact chemicals that can do the most damage,” Dantas says. That not only kills off good bugs that the baby might need, but it creates drug-resistant bad bacteria that can pass on their genes, potentially setting the child up for a future illness that’s hard to treat. “And that could happen 40 years later,” Dantas says.
There is one major caveat inherent in many of the studies drawing a link between antibiotics and negative changes to the microbiome, however. It could be that children who de velop diseases that require antibiotic treatments early in life are also more susceptible to infections, allergies and obesity, and it would be challenging to design a study to definitively answer the question of which came first.
That said, all of the mounting evidence argues for consider ing steps parents can take to better arm their kids. Studies
have shown that diets high in animal protein and fat, as well as highly processed carbohydrates like white bread and pastries, can deplete beneficial bugs such as Bifidobacterium, which is essential for healthy digestion and preventing infections. Up ping your children’s consumption of peas and other vegetables and fruits, downplaying sugary breakfast cereals and candy, as well as feeding them protein from sources like milk and yogurt, can boost levels of Bifidobacterium.
Get a pet. Early exposure to pets can increase the diver sity of gut microbes and boost the population of bacteria that protect against obesity and allergies, according to a long-term Canadian study of pregnancy and early childhood.
Some women who undergo cesarean sections immediately swab their children’s eyes and skin with vaginal fluid – a prac tice called “vaginal seeding” – hoping to pass along beneficial bacteria that their infants are unable to acquire because they’re not passing through the birth canal. But there’s limited evidence to back up that claim, Woodall warns, and the practice could risk passing on bacterial diseases like streptococcus to infants. The American College of Obstetricians and Gynecologists ad vised against vaginal seeding in 2017.
For now, commonsense habits like following a healthful Mediterranean diet and breastfeeding offer the best path to a healthy microbiome in your children, Woodall says. This sci ence is “definitely one piece of the pie in terms of overall infant health.” Expect to be hearing more about it, he says. l
THE OMICRON VARIANT has helped some NBA players realize their hoop dreams, with teams sud denly adding their names to the roster to cover for teammates sidelined by COVID-19.
Apart from such slivers of a silver lining in the professional ranks, though, the pandemic has large ly wreaked havoc on the present and future dreams of many young athletes. Even before March 2020, when widespread lockdown orders went into effect, regular participation by kids in recreational team sports like basketball, soccer, baseball and softball had dropped. Ad ditional data from the Aspen Institute shows that 44% of families said their community-based sports programs had shuttered, merged with another program or returned with a lower capacity limit because of COVID-19.
As with so many other aspects of the pandemic, the fallout wasn’t distributed equally. In September 2021, approximately 50% of parents agreed that the risk of illness was a potential barrier to their child resuming sports, and this sports-related fear of illness was higher among Hispanic (58%) and Black parents (53%) than whites (47%). Meanwhile, many families who rely on free or low-cost sports teams in their communities, often through a school or park district, were left without options while families like mine, who pay thousands of dollars a year for travel teams, were able to pay their coaches to pro

vide smaller specialized group instruction during the pandemic to maintain our chil dren’s competitive edge.
As I’ve continued to research this prob lem and hear stories from parents, college athletes, coaches and, yes, even my own children, I’ve become more convinced that we need to redefine our American ap proach to youth sports and create a more positive sports climate for all children.
A positive sports climate frequently leads to opportunities later in life. The only reason that I attended an Ivy League school, for example, was because I was a talented runner. Without attracting the notice of these coaches, I probably would not have ended up where I am in life –nor, as a result, would my own children.
As a psychologist, I know that children who participate in sports are less likely to suffer from issues such as depression or anxiety and are less likely to die by suicide.
My own research done in pre-pandemic
©
It’s time to make youth sports more equitable, positive and fun
times shows that children of color who can ac cess high-quality sports programming through community and school partnerships are less likely to experience issues like depression and anxiety after nine months. Even for athletes who don’t continue to compete in college or beyond, sports can change lives by fostering teamwork, discipline, belonging and fun.
KIDS WHO PARTICIPATE IN SPORTS ARE LESS LIKELY TO SUFFER FROM DEPRESSION AND ANXIETY OR DIE BY SUICIDE.

But the reality is that not all children have access to the benefits of sports. And the children who have the most to gain – children of color and those from less resourced backgrounds – are less likely to participate due to access issues. These children face the problems of poor access to sports equipment and facilities, and have other de mands on their time that make consistent engagement in intensive sports practices challenging. For kids in these situations, sports may be seen as a “way out,” but the reality is that disinvestment in chil dren’s holistic development means that far too many youth are stuck in under-resourced environments. After all, only a small number of children earn athletic scholarships or become professional athletes.
A better way. Children of color from middle- and upper-class backgrounds may not face the same access issues, but they can ex perience their own sets of problems. They frequently experience pi geonholing into one type of sport they are assumed to be better suited
for, or they’re the only one on their team who looks like them. These children also experience discrimination on their own teams, and when they com pete against other teams, they frequently have to bear that burden alone. I’ve spoken with numerous college athletes who can recount the racial trauma they endured as children. This racial trauma didn’t just come from competitors on the play ing field, it sometimes came from their own coaches and teammates. While these chil dren may reap the benefits of sports, it comes at the cost of their positive racial identity.
We can create a better sports climate for all youth as we transi tion out of the pandemic and rec ognize the mental and physical health benefits that sports yield. We can do this by offering more sports opportunities in schools – especially for younger elemen tary school-aged children.
Chicago Public Schools, the third-largest school system in the nation, does not offer schoolbased sports programming until youth are in fifth grade. Non profit organizations such as Urban Initiatives and Girls in the Game have stepped in to fill the gap by offering school-based sports pro gramming with social and emotional components, but these organizations cannot do it alone.
We can equip nonprofit and community-based sports organizations with tools to improve their eq uity and inclusion practices. We can train coaches and parents on how to prevent, address and heal from racism on the field. Organizations like the Center for Healing and Justice through Sport are doing both in their work to train coaches on creating a healingcentered sports climate.
The COVID-19 pandemic has altered the way we play sports at all levels. We can use this moment to change youth sports for the better. Even if the chil dren in your life don’t have plans to become profes sional basketball players, we should take this oppor tunity to make youth sports more equitable, positive and fun – for all kids. l
Jocelyn Carter is a professor of psychology and the director of clinical training at DePaul University. She is a Public Voices Fellow with The OpEd Project.
We’re proud to be one of the top 3 children’s hospitals in the nation— but our rankings are only the beginning. From research to clinical care, we’re tackling the big things so kids can enjoy the small things.







Building a world where all kids can live their best possible lives.
This elite list showcases hospitals with unusual breadth of excellence in pediatric specialty care. For each specialty, each hospital that ranked among the top 50 earned points toward the Honor Roll: 25 points for ranking No. 1, 24 points for No. 2 and so on; hospitals ranked 21-50 received 5 points. The hospitals with the most points define the Honor Roll.
1
Boston Children’s Hospital Boston, Massachusetts 243 points
Texas Children’s Hospital Houston, Texas 224 points
Cincinnati Children’s Hospital Medical Center Cincinnati, Ohio 207 points
Children’s Hospital of Philadelphia Philadelphia, Pennsylvania 205 points
5
Children’s National Hospital Washington, D.C. 166 points
UPMC Children’s Hospital of Pittsburgh Pittsburgh, Pennsylvania 164 points
Children's Hospital Colorado Aurora, Colorado 153 points
8
Children's Hospital Los Angeles Los Angeles, California 142 points
Nationwide Children’s Hospital Columbus, Ohio 140 points
Lucile Packard Children’s Hospital Stanford Palo Alto, California 135 points





Jonah, 2, travels from his Texas home to CHOP, where he receives expert care for his rare genetic syndrome.



When it came to finding expert care for their son’s rare genetic condition, making the trip from Texas to Philadelphia was an easy decision for his parents. Children’s Hospital of Philadelphia has clinicians who specialize in PallisterKillian syndrome — and a multitude of other complex diseases. Unmatched expertise in the uncommon is just one reason we have been on the U.S. News & World Report Honor Roll of Best Children’s Hospitals since its inception.
From developing advanced therapies to expertly treating rare diseases, we’re here for your child at every step.

4 CHILDREN’S HOSPITAL OF PHILADELPHIA

THE COUNTRY'S FIRST HOSPITAL DEDICATED JUST TO PEDIATRIC CARE TYPICALLY COUNTS MORE THAN 1 MILLION ADMISSIONS AND OUTPATIENT VISITS ANNUALLY.
BASED IN WASHINGTON, D.C., CHILDREN'S NATIONAL HAS MORE THAN 300 INPATIENT BEDS AND IS ON THE LEADING EDGE OF PEDIATRIC RESEARCH.
HERE SHOULD anxious parents take a newborn with a life-threatening heart defect, or find ongoing care for a child with failing kidneys or lung-clogging cys tic fibrosis? A local hospital’s pediatric department might be perfectly capable of managing ear infections, allergies, flu and other common childhood ailments. But it may not have the expertise to treat severely ill kids. That’s where children’s hospitals come in. There are approximately 200 hospitals in the country that either exclusively treat pediatric patients or possess a pediatric department that functions like a self-contained
children’s hospital. Even within that group, some centers are better than others. U.S. News created the Best Children’s Hospitals rankings to help parents, in consultation with their doctors, find those best suited to their child.
The 2022-23 rankings highlight top children’s centers in 10 specialties: cancer, cardiology and heart surgery, diabetes and endocrinology, gastroenterology and gastrointestinal surgery, neonatology, nephrology, neurology and neurosurgery, ortho pedics, pulmonology and lung surgery, and urology. This year, 90 hospitals ranked in at least one specialty, and 10 were named to the Honor Roll for scoring near the top in most or all special ties. Regional rankings for each of seven multi-state regions

(Page 210) list hospitals according to the number of specialties in which they were among the best.
Rich data. Judging the excellence of children’s hospitals is challenging, and no single metric or ranking should be viewed as a definitive guide.
U.S. News gathered more than 1,000 data points on each hospital to determine its strengths and weaknesses. Many summary measures appear in the ranking tables that follow; more can be found at usnews.com/childrenshospitals, which also fea
tures data on dozens of additional children’s hospitals.
Almost all of the medical data used in these rankings were obtained by ask ing hospitals to complete a lengthy on line data-collection process. This year, 119 hospitals surveyed by U.S. News provided enough data to be evaluated.

RTI International, a North Car olina-based research firm, oversaw data collection and produced the rankings. Collaborating with RTI staff, 168 pediatric experts serving in working groups helped design the data-collection survey.
Whether and how high an institu tion was ranked depended on three elements: its clinical outcomes (such as survival and surgical complica tions), its delivery of care (such as ad hering to safe and effective practices), and its resources (such as staffing and technology). Each element contrib uted one-third of a hospital’s overall score in most specialties. A detailed FAQ about the rankings is available at usnews.com/aboutchildrens. Here are the basics:
Clinical outcomes. These reveal a hospital’s success at keeping kids alive after their treat ment, protecting them from infections and complications, and improving their quality of life. While tough to measure, outcomes tend to matter most to both families and doctors.
Delivery of care. How well a hospital handles day-to-day care was determined in part by com pliance with accepted “best practices,” such as performing neuropsychologi cal evaluation of patients with certain cancers. Another factor: a hospital’s demonstrated commitment to diversi ty, equity and inclusion by, say, screen ing patients for social determinants of health like food insecurity. U.S. News also surveyed pediatric special ists, asking them to identify up to 10 hospitals they consider best in their area of expertise for kids with complex medical problems.
Resources. Surgical volume, nursepatient ratio, clinics and programs for conditions such as asthma, and dozens of other measures were considered.
Every child, everywhere, deserves the very best. It’s why Children’s Hospital & Medical Center combines the largest group of pediatric specialties in the region, the most advanced technology and the biggest hearts all in one place. Together, in this safe and welcoming environment of excellence, we’re shaping the future of pediatric medicine to deliver the very best for kids.


A Nurse Magnet hospital: hospital recognized by American Nurses Credentialing Center as meeting standards for nursing excellence. Infection prevention score, ICU: ability to prevent central-line bloodstream infections in intensive care units. Infection prevention score, overall: ability to prevent infections through mea sures such as hand hygiene and vaccination. No. of best practices: how well hospital adheres to recommended ways of diagnosing and treating patients, such as documenting blood sugar levels for a high percentage of outpatients (diabetes & endocrinology) and conducting hip exams with ultrasound specialists (orthopedics). Nurse-patient ratio: balance of full-time registered nurses to inpatients.
Patient volume score: relative number of patients in past year with specified disorders. % of specialists recommending hospital: percentage of physician specialists surveyed in 2020, 2021 and 2022 who named hospital among best for very challenging patients. Procedure volume score: relative number of tests and nonsurgical procedures in past one, two or three years, such as implanting radioactive seeds in a cancerous thyroid (diabetes & endocrinology) and using an endoscope for diagnosis (gastroenterology). Surgical procedures are included in orthopedics.
Surgery volume score: relative number of patients who had specified surgical procedures in past year. Surgical complications prevention score: ability to prevent surgery-related complications and readmissions within 30 days (neurology & neurosurgery, orthopedics, urology).
U.S. News score: 0 to 100 summary of overall performance in specialty.
NA: not applicable; service not provided by hospital.
NR: data not reported or unavailable.
Bone marrow transplant survival score: survival of stem cell recipients at 100 days. Five-year survival score: survival five years after treatment for acute lymphoblastic leukemia, acute myeloid leukemia and neuroblastoma. Palliative care score: how well program meets specified training and staffing standards for children with terminal or life-limiting conditions, and number of cancer patients referred to program.
CARDIOLOGY & HEART SURGERY
Catheter procedure volume score: relative number of specified catheter-based procedures in past year, such as inserting stents and treating heart rhythm problems. Length of stay after surgery score: success in minimizing how long certain congenital heart patients spend in the hospital for care related to their heart condition. Norwood/hybrid surgery survival score: survival at one year after the first in a series of reconstructive surgeries, evaluated over past four years.
Risk-adjusted surgical survival score: survival in the hospital and 30 days from discharge after congenital heart surgery, adjusted for operative and patient risk, evaluated over past four years.
Diabetes management score: ability to prevent serious problems in children with Type 1 diabetes and to keep blood sugar levels in check. Hypothyroid management score: relative proportions of children treated for underac tive thyroid who test normal and of infants who begin treatment by 3 weeks of age.
Liver transplant survival score: one- and three-year survival after liver transplant. Nonsurgical procedure volume score: relative number of tests and noninvasive procedures. Selected treatments success score: shown, for example, by high remission rates for inflammatory bowel disease and few complications from endoscopic procedures.
Infection prevention score, NICU: ability to prevent central-line bloodstream infections in neonatal ICU. Keeping breathing tube in place score: ability to minimize inappropriate breathingtube removal in intubated infants. Leaves NICU on breast milk score: relative percentage of infants discharged from NICU receiving some nutrition from breast milk.
NICU temperature management score: success in managing NICU patients’ temperature at the time of admission and postoperatively.
Biopsy complications prevention score: ability to minimize complications after kidney biopsy. Dialysis management score: relative proportion of dialysis patients in past two years who tested normal. Infection prevention score, dialysis: ability to minimize dialysis-related infection. Kidney transplant survival score: based on patient survival and functioning kidney at one and three years.
Epilepsy management score: ability to treat children with epilepsy. Surgical survival score: survival at 30 days after complex surgery and procedures, such as those involving brain tumors, epilepsy and head trauma.
Fracture repair score: ability to treat complex leg and forearm fractures efficiently.
Asthma inpatient care score: ability to mini mize asthmatic children’s asthma-related deaths, length of stay and readmissions. Cystic fibrosis management score: ability to improve lung function and nutritional status.
Lung transplant survival score: reflects number of transplants in past two years, one-year survival, and recognition by United Network for Organ Sharing.
Minimally invasive volume score: relative number of patients in past year who had specified nonsurgical procedures. Testicular torsion care score: promptness of emergency surgery to correct twisted spermatic cord.
Dana-Farber/Boston
St. Jude Children’s Research Hospital, Memphis,
Cincinnati Children’s Hospital Medical Center
Texas Children’s Hospital, Houston
Children’s Hospital of Philadelphia
Children’s National Hospital, Washington, D.C.
Children’s Healthcare of Atlanta
Children’s Hospital Colorado, Aurora
Hopkins Children’s Center,
Ann and Robert H. Lurie Children’s Hospital
Children’s Hospital, Columbus, Ohio
U. of Michigan Health C.S. Mott Children’s Hospital,
UPMC Children’s Hospital of Pittsburgh
Children’s Hospital Los Angeles
Cleveland Clinic Children’s Hospital
Children’s Medical Center Dallas
Arbor
15 30
15 30
8 45.7%
8 29.9%
8 34.0%
8 34.5%
8 44.5%
8 17.2%
8 19.9%
8 17.6%
10.6%
9.1%
8 14.5%
15 30
13 30
8 3.9%
8 4.8%
15 30 3.8 Yes 8 21.6%
15 26 3.5 Yes 8 1.2%
15 30 3.3 Yes 8 3.3%
UCSF Benioff Children’s Hospitals, San Francisco and Oakland 83.0 14 4 41 13 29 4.2 Yes 7 9.8%
18 MSK Kids at Memorial Sloan Kettering Cancer Center, New York 82.3 12 5 35 11 23 5.8 Yes 8 10.9%
19 Monroe Carell Jr. Children’s Hospital at Vanderbilt, Nashville, Tenn. 82.1 14 5 42 12 30 3.5 Yes 8 2.3%
20 Seattle Children’s Hospital 82.0 13 4 41 8 16 3.6 Yes 8 26.3%
21 Children’s Wisconsin Hospital, Milwaukee 81.7 15 5 38 15 16 4.0 Yes 8 1.8%
22 Lucile Packard Children’s Hospital Stanford, Palo Alto, Calif. 81.3 13 5 42 15 15 4.3 Yes 6 7.6%
23 Children’s Cancer Hospital-U. of Texas MD Anderson Cancer Center 80.9 12 5 39 15 23 3.3 Yes 8 4.1%
24 Riley Hospital for Children at IU Health, Indianapolis 80.7 12 6 39 11 28 4.3 Yes 8 2.1%
25 CHOC Children’s Hospital, Orange, Calif. 80.3 12
Rainbow Babies and Children’s Hospital, Cleveland 80.3 15
Nemours Children’s Hospital-Delaware, Wilmington, Del. 79.9 13
New York-Presbyterian Hospital-Columbia and Cornell, New York 79.5 13
Rady Children’s Hospital, San Diego 79.4
Doernbecher Children’s Hosp. at Oregon Hlth. & Sci. U., Portland, Ore.
Children’s Medical Center, New Hyde Park, N.Y.
Shawn Jenkins Children’s Hospital, Charleston, S.C.
Carolina
Hospital
40 12 20 3.8 Yes 8 3.5%
9 19 3.1 Yes 8 1.1%
11 14 3.3 Yes 8 2.1%
13 23 4.0 Yes 7 3.5%
12 27 3.5
8 2.2%
15 18 4.3 Yes 8 1.0%
12 12 4.0 Yes 8 1.0%
14 10 2.5
8 0.8%
Children’s HealthSM and UT Southwestern Pediatric Group physicians are making life better for children. In fact, Children’s Medical Center Dallas was ranked in all 10 pediatric specialties by U.S. News & World Report With advanced research and lifesaving treatments, we’re leading the way in pediatrics.

H.
Rady Children’s Hospital, San Diego
Children’s Hospital Los Angeles
Children’s Hospital Colorado, Aurora
Nationwide Children’s Hospital, Columbus, Ohio
24.7%
8 15 3.5 3.7%
11 15 3.8 16.7%
3 10 19 4.1 13.9%
7 16 3.3 10.4%
Cincinnati Children’s & Kentucky Children’s Hosp. Joint Heart Program 76.9 2 24 9 48 1 11 21 4.5 25.9%
16 Johns Hopkins Children’s Center, Baltimore 76.9 4 18 7 48 3 5 9 3.6 1.8%
18 Children’s Healthcare of Atlanta 76.4 2 22 8 44 5 13 20 5.3 16.5%
19 Children’s Mercy Kansas City Hospital, Mo. 75.1 3 22 7 47 5 9 15 4.2 2.6%
19 Le Bonheur Children’s Hospital, Memphis, Tenn. 75.1 4 22 7 42 5 6 12 2.6 3.4%
Virginia Congenital Cardiac Collaborative, Charlottesville & Norfolk 74.8 4 23 7 46 3 9 17 3.0 1.5%
Levine Children’s Hospital, Charlotte, N.C. 74.1 4 23 8 47 4 6 16 3.3 2.2%
Seattle Children’s Hospital 74.0 3 23 7 47 2 11 15 3.6 9.9%
St. Louis Children’s Hospital-Washington University 73.3 3 20 7 45 3 6 19 3.7 3.4%
Hassenfeld Children’s Hospital at NYU Langone, New York
Lucile Packard Children’s Hospital Stanford, Palo Alto, Calif.
UF Health Shands Children’s Hospital, Gainesville, Fla.
Children’s Hospital of Alabama at UAB, Birmingham
Children’s Medical Center Dallas
Carell Jr. Children’s Hospital at Vanderbilt,
Wisconsin Hospital, Milwaukee
Family Children’s Hospital, Madison, Wis.
State Health Children’s Hospital, Hershey,
5 5 10 3.1 1.3%
5 14 19 4.3 32.4%
5 8 10 2.8 1.9%
2 9 12 3.7 2.0%
3.9%
4.2%
5.6%
0.8%














































Hopkins Children’s Center,
Health Shands Children’s Hospital, Gainesville, Fla.
North Carolina Children’s Hospital at UNC, Chapel Hill
Rainbow Babies and Children’s Hospital, Cleveland
Norton Children’s Hospital, Louisville, Ky.
13
119 21.2%
25.3%
117 15.7%
115 16.0%
109 11.0%
8.8%
3.7%
103 14.5%
109 6.5%
Yes 118 6.1%
Yes 111 2.4%
11 3.1 Yes 117 3.3%
14 3.1 No 116 1.2%
Ann and Robert H. Lurie Children’s Hospital of Chicago 77.7 40 6 36 33 12 2.8 Yes 109 6.9%
18 Yale New Haven Children’s Hospital, New Haven, Conn. 77.4 29 8 38 33 8 4.1 Yes 118 10.4%
19 Nationwide Children’s Hospital, Columbus, Ohio 77.3 27 9 36 34 8 3.3 Yes 111 7.5%
20 St. Louis Children’s Hospital-Washington University 77.1 37 5 37 32 13 3.7 Yes 106 5.6%
Children’s Medical Center Dallas 75.8 26 9 37 34 14 3.3 Yes 110 5.4%
Children’s Mercy Kansas City Hospital, Mo. 75.7 37 6 38 33 8 4.2 Yes 107 4.1%
U. of Michigan Health C.S. Mott Children’s Hospital, Ann Arbor 75.7 33 8 36 31 9 4.9 Yes 111 3.3%
MassGeneral Hospital for Children, Boston 75.0 31 8 28 32 14 3.7 Yes 113 5.5%
University of Iowa Stead Family Children’s Hospital, Iowa City 75.0 44 6 34 34 7 3.5 Yes 99 1.8%
CHOC Children’s Hospital, Orange, Calif.
Cohen Children’s Medical Center, New Hyde Park, N.Y.
Arnold Palmer Hospital for Children, Orlando
Arkansas Children’s Hospital, Little Rock
Monroe Carell Jr. Children’s Hospital
Benioff Children’s Hospitals,
Healthcare of
York-Presbyterian
Hopkins All Children’s
32 11 3.8 Yes 104 2.0%
33 14 4.0 Yes 113 1.4%
30 12 3.0 Yes 115 0.2%
31 13 3.5 Yes 113 1.1%
3.7%
2.4%
7.5%
Suri had a bad stomach ache that turned out to be myocarditis, a serious inflammation of the heart. Specialists from our multidisciplinary pediatric critical care team worked together to regulate her heartbeat—and got Suri back to thinking about what comes next. nyp.org/pediatrics

Clinic Children’s Hospital
Lucile Packard Children’s Hospital
Alto,
St. Louis Children’s Hospital-Washington University
New York-Presbyterian Hosp.-Columbia and Cornell, New York
Riley Hospital for Children at IU Health, Indianapolis
Children’s National Hospital, Washington, D.C.
Children’s Wisconsin Hospital, Milwaukee
North Carolina Children’s Hospital at UNC, Chapel Hill
Seattle Children’s Hospital
Levine Children’s Hospital, Charlotte, N.C.
UCSF Benioff Children’s Hospitals, San Francisco and Oakland
U. of Michigan Health C.S. Mott Children’s Hospital, Ann Arbor
Yale New Haven Children’s Hospital, New Haven, Conn.
Children’s Hospital of Michigan, Detroit
Rady Children’s Hospital, San Diego
Children’s Mercy Kansas City Hospital, Mo.
Monroe Carell Jr. Children’s Hosp.
Children’s
and Robert H. Lurie
Hospital for Children,
Kravis Children’s
13
18
Yes 14.5%
Yes 2.0%
11 16 4.3 Yes 9.3%
12 14 3.7 Yes 4.6%
11 18 4.0 Yes 5.2%
26 10 18 4.3 Yes 3.9%
21 11 14 3.9 Yes 5.4%
24 11 17 4.0 Yes 4.4%
17 11 11 4.5 Yes 1.4%
24 9 13 3.6 Yes 12.7%
23 7 15 3.3 Yes 1.1%
23 6 16 4.2 Yes 6.2%
27 10 16 4.9 Yes 2.2%
19 8 13 4.1 Yes 2.5%
26 6 12 2.7 No 0.4%
24 11 13 3.5 Yes 2.8%
24 11 14 4.2 Yes 4.3%
2.3%
3.2%
At CHOC, we know that research and innovation can lead to lifesaving decisions. Our culture encourages out-of-the box thinking and problem solving guided by our passion for giving every child
healthiest life possible.
This philosophy of “Go Beyond” can lead to the discovery of new medical devices or medications. It also can reveal how therapies used for certain diagnoses can be applied to other ones.







In a recent example of the latter, a device used by gastroenterologist Dr. Ashish Chogle for functional gastrointestinal disorders now is being studied in a clinical trial to treat patients with Post-Concussion Syndrome (PCS). The device, called IB-Stim, attaches to the ear and electrically stimulates the vagal nerve, the most important nerve of the autonomic nervous system.
CHOC was the first pediatric hospital to use the IB-Stim on patients (outside of a research study) suffering from irritable bowel
syndrome and other GI issues. Neurologist Dr. Sharief Taraman says the device shows great potential in its new application for patients with PCS, in which dysfunction of the autonomic nervous system is believed to play a critical role. Innovation requires looking at the bigger picture. Research can bring breakthrough ideas to real-life solutions. At CHOC, both are happening across our enterprise as we continue to advance care for the children and families we serve.

Translating patient needs into innovative
National
Hospital,
18.3%
Packard
Children’s Hospital
St. Louis Children’s Hospital-Washington University
Children’s Hospital, San Diego
Ann & Robert H. Lurie Children’s Hosp.-Prentice Women’s Hosp.,
Cleveland Clinic Children’s Hospital
Nationwide Children’s Hospital, Columbus, Ohio
Rainbow Babies and Children’s Hospital, Cleveland
CHOC Children’s Hospital, Orange, Calif.
Children’s Mercy Kansas City Hospital, Mo.
85 16.7%
85 23.1%
85 10.1%
86 5.2%
26 3.1 83 7.6%
20 2.7 85 3.5%
44 5 33 3.1 83 16.7%
41 5 18 4.0 84 8.2%
43 5 30 3.8 83 3.3%
47 5 35 4.0 86 3.8%
Riley Hospital for Children at IU Health, Indianapolis 84.4 2 5 12 44 5 33 3.0 85 4.0%
16 New York-Presbyterian Hospital-Columbia and Cornell, New York 83.5
7 44 5 28 2.7 82 10.1%
17 Children’s Hospital of Philadelphia 83.3 3 5 8 45 1 37 4.0 84 36.2%
18 Children’s Medical Center Dallas 82.8
5 10 44 5 22 3.1 84 4.1%
19 Children’s Hospital Colorado, Aurora 82.7 3 4 12 44 3 33 2.9 85 11.7%
19 Children’s Hospital Los Angeles 82.7 3 5 11 41 3 31 3.2 85 9.5%
20 UCLA Mattel Children’s Hospital, Los Angeles 82.2 3 5 10 37 5 16 4.1 81 7.6%
22 Monroe Carell Jr. Children’s Hospital at Vanderbilt, Nashville, Tenn. 82.0 2 5 12 39 5 19 2.7 80 6.4%
23 North Carolina Children’s Hospital at UNC, Chapel Hill 81.4
24 Cohen Children’s Medical Center, New Hyde Park, N.Y. 81.2
Duke Children’s Hospital and Health Center, Durham, N.C. 81.2
University of Iowa Stead Family Children’s Hospital, Iowa City 81.0
Johns Hopkins Children’s Center, Baltimore 79.2
Seattle Children’s Hospital
UC Davis Children’s Hospital, Sacramento, Calif.
Valley Children’s Healthcare and Hospital, Madera, Calif.
Levine Children’s Hospital, Charlotte, N.C.
University of Virginia Children’s Hospital, Charlottesville
5 12 45 5 25 2.5 83 2.0%
12 45 5 23 3.3 83 1.0%
11 44 5 25 2.7 83 3.0%
11 42 5 24 2.5 78 6.6%
8 47 4 32 3.3 80 4.7%
30 5.0 74 10.6%
25 3.3 83 1.6%
25 2.2 77 1.4%
24 2.5 82 1.4%
Kids aren’t just different from adults — they’re also different from each other. That’s why each kid needs incredibly different care. Inspired by the kids we treat at Children’s Hospital Colorado, we’re creating a culture that continuously encourages curiosity and discovery. Questions once asked within the silos of specific specialties are now being addressed by collaborative multidisciplinary teams to create individualized diagnoses and treatments. These remarkable advances lead to better health outcomes for each child and allow us to deliver the dedicated difference every kid deserves.
Children’s Hospital Colorado is proud to be nationally ranked in every pediatric specialty by U.S. News & World Report.

Children’s
Children’s Hospital,
National
Children’s Hospital
Children’s
Children’s Hospital of
Healthcare of
Children’s Hospital,
Children’s Hospital of Pittsburgh
Johns Hopkins Children’s Center, Baltimore
Hospital for Children at IU Health,
UCLA Mattel Children’s Hospital, Los Angeles
Benioff Children’s Hospitals, San Francisco
Ann and Robert H. Lurie Children’s Hospital of Chicago 85.5
Rady Children’s Hospital, San Diego 85.2
Children’s Hospital Los Angeles 83.9
UC Davis Children’s Hospital, Sacramento, Calif. 83.3
Doernbecher Children’s Hosp. at Oregon Hlth. & Sci. U., Portland 82.6 24
U. of Michigan Health C.S. Mott Children’s Hospital, Ann Arbor 82.6 22
Children’s Hospital Colorado, Aurora 82.0 23
New York-Presbyterian Hosp.-Columbia and Cornell, New York 82.0 22
Children’s Medical Center Dallas
St. Louis Children’s Hospital-Washington University
Levine Children’s Hospital, Charlotte, N.C.
Cohen Children’s Medical Center, New Hyde Park, N.Y.
University of Iowa Stead Family Children’s Hospital, Iowa City
Cleveland Clinic Children’s Hospital
Phoenix Children’s Hospital
MUSC Shawn Jenkins Children’s Hospital, Charleston, S.C.
Children’s Hospital of Richmond at VCU, Va.
Hospital
Alabama
Linda University Children’s
Children’s Hospital,
Sanzari
Hovnanian
12 64
14
12
28.3%
42.0%
Yes 41.5%
Yes 39.1%
Yes 23.4%
20.2%
11 3.3 Yes 10.0%
Yes 14.1%
Yes 7.9%
4.6 Yes 11.3%
Yes 5.8%
7 14 2.8 Yes 13.3%
9 14 3.5 Yes 3.8%
57 5 9 13 3.8 Yes 6.3%
64 5 9 12 7.8 Yes 1.7%
12 58 5 9 8 4.3 Yes 2.3%
11 61 5 6 14 4.9 Yes 5.6%
9 64 3 8 12 4.1 Yes 7.3%
10 62 5 9 11 4.0 Yes 4.0%
64
9 13 3.3 Yes 6.6%
60 3 7 12 3.7 Yes 6.0%
12 64 4 8 12 3.3 Yes 1.7%
12 65 2 8 10 4.0 Yes 0.8%
7 14 3.5 Yes 4.7%
9 11 3.5 Yes 1.7%
9 14 3.2 No 1.3%
7 14 2.5 Yes 1.2%















patient
Boston Children’s Hospital
Texas Children’s Hospital, Houston
Children’s National Hospital, Washington, D.C.
Children’s Hospital of Philadelphia
St. Louis Children’s Hospital-Washington University
Cincinnati Children’s Hospital Medical Center
Lucile Packard Children’s Hospital Stanford, Palo Alto, Calif.
Rady Children’s Hospital, San Diego
Nationwide Children’s Hospital, Columbus, Ohio
UPMC Children’s Hospital of Pittsburgh
Children’s Healthcare of Atlanta
Children’s Hospital Colorado, Aurora
Seattle Children’s Hospital
recommending hospital
36 4.0 Yes 43.3%
38 4.2 Yes 26.1%
34 3.9 Yes 20.2%
33 3.5 Yes 35.5%
36 3.7
17.6%
37 4.5 Yes 19.6%
29 4.3 Yes 9.2%
39 3.5 Yes 4.2%
Yes 13.4%
9.7%
36 5.3 Yes 3.4%
32 4.1 Yes 15.7%
29 3.6 Yes 17.3%
New York-Presbyterian Hospital-Columbia and Cornell, New York 84.7 11 22 6 41 27 4.0 Yes 7.2%
Children’s Hospital Los Angeles 84.2 12 22 4 40 34 3.8 Yes 7.8%
UCSF Benioff Children’s Hospitals, San Francisco and Oakland 83.5 12 17 4 43 32 4.2 Yes 12.7%
Intermountain Primary Children’s Hosp.-U. of Utah, Salt Lake City 82.7 11 22 6 42 36 3.3 No 7.4%
Children’s Mercy Kansas City Hospital, Mo. 81.2 12 20 6 43 29 4.2 Yes 2.1%
18 Johns Hopkins All Children’s Hospital, St. Petersburg, Fla. 81.2 12 22 6 44 29 3.9 Yes 1.5%
19 Phoenix Children’s Hospital 81.1 12 20 6 44 36 3.2 No 4.4%
20 Cohen Children’s Medical Center, New Hyde Park, N.Y. 80.8 12 22 4 43 32 4.0 Yes 2.5%
21 Children’s Medical Center Dallas 80.4 12 22 3 44 38 3.3 Yes 3.4%
23 Johns Hopkins Children’s Center, Baltimore 78.4 12 19 2 45 24 3.6 Yes 12.5%
23 Monroe Carell Jr. Children’s Hospital at Vanderbilt, Nashville, Tenn. 78.4 11 14 6 43 32 3.5 Yes 4.1%
25 Nicklaus Children’s Hospital, Miami 77.7 12 17 6 36 23 2.9 Yes 5.5%
Children’s Hospital of Michigan, Detroit 77.3 12 22 6 41 27 2.7 No 0.9%
27 Children’s Memorial Hermann Hospital, Houston 77.1 12 19 6 39 23 3.3 Yes 1.6%
Children’s Hospital of Alabama at UAB, Birmingham 76.6 12 18 5 44 31 3.7 No 5.0%
Cook Children’s Medical Center, Fort Worth 76.5 12 20 5 40 28 3.2 Yes 3.2%
UCLA Mattel Children’s Hospital, Los Angeles 76.1 12 18 5 37 19 4.6 Yes 5.3%
Yale New Haven Children’s Hospital, New Haven, Conn. 76.1
Mayo Clinic Children’s Center, Rochester, Minn.
Valley Children’s Healthcare and Hospital, Madera, Calif.
UF Health Shands Children’s Hospital, Gainesville, Fla.
Children’s Wisconsin Hospital, Milwaukee
12 4.1 Yes 0.9%
19 3.7 Yes 4.9%
20 3.8 Yes 0.6%
14 2.8 Yes 1.3%
20 4.0
Boston Children’s Hospital
Children’s Hospital, San
Medical Center
Hospital of Philadelphia
Children’s Hospital
Hospital Los Angeles
Rite Hospital
Center
Children’s National Hospital, Washington, D.C.
Texas Children’s Hospital, Houston
Children’s Pavilion-Hospital
Louis Children’s Hospital-Washington
Healthcare of Atlanta
Children’s Hospital Colorado, Aurora
Johns Hopkins Children’s Center, Baltimore
UCLA Mattel Children’s Hospital, Los Angeles
Nationwide Children’s Hospital, Columbus, Ohio
16 Mayo Clinic Children’s Center, Rochester, Minn.
17 Rainbow Babies and Children’s Hospital, Cleveland
26
79 43.2%
79 30.1%
79 34.6%
78 38.4%
78 15.7%
Yes 75 15.9%
Yes 73 6.3%
Yes 80 11.2%
4.6%
78 8.4%
79 11.7%
26
Yes 70 14.6%
12 16 3.6 Yes 78 4.2%
20 20 4.6 Yes 77 4.1%
23 23 3.3 Yes 77 8.7%
9 15 3.7 Yes 77 3.1%
8 10 36 20 16 3.1 Yes 79 5.5%
18 Lucile Packard Children’s Hospital Stanford, Palo Alto, Calif. 76.6 8 10 41 8 24 4.3 Yes 68 3.5%
19 UC Davis Children’s Hospital/Shriners Hospitals N. Calif., Sacramento 76.5 8 8 39 21 25 7.8 Yes 76 5.6%
20 Nemours Children’s Hospital-Delaware, Wilmington, Del. 75.7 6 9 39 17 22 3.3 Yes 77 16.5%
21 Valley Children’s Healthcare and Hospital, Madera, Calif. 75.4 7 13 39 21 17 3.8 Yes 78 0.3%
22 Cohen Children’s Medical Center, New Hyde Park, N.Y. 73.8 7 11 40 15 18 4.0 Yes 80 0.7%
23 North Carolina Children’s Hospital at UNC, Chapel Hill 73.6 7 12 42 14 12 4.5 Yes 70 0.8%
24 Levine Children’s Hospital, Charlotte, N.C. 72.7 8 11 41 13 17 3.3 Yes 71 0.5%
25 Akron Children’s Hospital, Ohio
CHOC Children’s Hospital, Orange, Calif.
Ann and Robert H. Lurie Children’s Hospital of Chicago
UCSF Benioff Children’s Hospitals, San Francisco and Oakland
UPMC Children’s Hosp. of Pittsburgh-Shriners Hosps.
Mercy Kansas City Hospital, Mo.
Carell Jr. Children’s Hospital at
Primary Children’s Hosp.-Shriners Hosps. for Children-U.
38 18 19 3.3 Yes 75 2.1%
15 15 3.8 Yes 69 1.2%
39 12 20 2.8 Yes 66 5.0%
12 17 4.2 Yes 75 3.1%
73 2.5%
Yes 76 2.5%
Yes 77 5.1%
Hospital
Children’s
Hospital
Hospital
Hospital for Children
National Hospital,
Children’s
Health,
13.0%
Carolina Children’s Hospital
Johns Hopkins Children’s Center, Baltimore
St. Louis Children’s Hospital-Washington University
Children’s Hospital Los Angeles
Children’s Healthcare of Atlanta
Rainbow Babies and Children’s Hospital, Cleveland
23.2%
10.8%
15 3.6 Yes 10.1%
12 3.7 Yes 11.7%
5 14 3.8 Yes 13.9%
45 5 15 5.3 Yes 3.6%
44 5 13 3.1 Yes 4.8%
18 UF Health Shands Children’s Hospital, Gainesville, Fla. 85.0 8 5 15 47 5 12 2.8 Yes 1.5%
19 Ann and Robert H. Lurie Children’s Hospital of Chicago 84.1 7 NA 19 46 3 13 2.8 Yes 9.4%
19 Monroe Carell Jr. Children’s Hospital at Vanderbilt, Nashville, Tenn. 84.1 8
18 47 2 13 3.5 Yes 7.0%
21 Children’s Medical Center Dallas 82.6 7 NA 16 48 5 14 3.3 Yes 2.9%
21 New York-Presbyterian Hospital-Columbia and Cornell, New York 82.6
23 Rady Children’s Hospital, San Diego 82.4
24 Arkansas Children’s Hospital, Little Rock 82.1 8
24 Children’s Mercy Kansas City Hospital, Mo. 82.1 8
UCSF Benioff Children’s Hospitals, San Francisco and Oakland 82.1
U. of Michigan Health C.S. Mott Children’s Hospital, Ann Arbor 82.0
Children’s Wisconsin Hospital, Milwaukee
Valley Children’s Healthcare and Hospital, Madera, Calif. 81.0
Clinic Children’s Hospital
New Haven Children’s Hospital, New Haven, Conn.
Children’s Medical Center, New Hyde Park, N.Y.
Hospital for Children, Boston
Children’s
14 42 5 13 4.0 Yes 6.1%
18 51 2 11 3.5 Yes 3.2%
19 43 5 11 3.5 Yes 1.1%
17 46 5 11 4.2 Yes 2.9%
17 49 3 9 4.2 Yes 3.6%
16 47 5 17 4.9 Yes 2.5%
17 45 5 12 4.0 Yes 1.5%
18 51 5 9 3.8 Yes 0.1%
1.3%
Yes 1.3%
1.3%
3.4%

The ACC's comprehensive offerings of adult and pediatric congenital heart disease (CHD) programs drive quality improvement and help advance optimal patient care for children and adults with heart disease. Choose one of these top hospitals and clinics that deliver the best heart-focused care and are dedicated to treatment of patients of all ages.
Adult Congenital & Pediatric Cardiology (ACPC) Quality Network™
is a national network of CHD clinics dedicated to developing best practices and advancing standards for patient care.
Boston Children's Hospital Boston, MA
Cardiology Care for Children Lancaster, PA
Child Cardiology Associates Fairfax, VA
Children's Healthcare of Atlanta Atlanta, GA
Children's Hearts Nashville, TN
Children's Hospital Colorado Aurora, CO
Children's Hospital of Los Angeles Los Angeles, CA
Children's Hospital Medical Center of Akron Akron, OH
Children's Hospital of New Orleans New Orleans, LA
Children's Hospital of Orange County Orange, CA
Children's Hospital of Philadelphia Philadelphia, PA
Children's Mercy Kansas City Kansas City, MO
Children's National Medical Center Washington, DC
Cincinnati Children's Hospital Medical Center Cincinnati, OH
Eastern Maine Medical Center Bangor, ME
Intermountain Primary Children's Hospital Salt Lake City, UT
Johns Hopkins All Children's Hospital, Inc St. Petersburg, FL
Le Bonheur Children's Hospital Memphis, TN
Lee Health - HealthPark Medical Center Fort Myers, FL
Lucile S. Packard Children's Hospital at Stanford University Palo Alto, CA
Lurie Children's Hospital of Chicago Chicago, IL
Mayo Clinic Hospital - Saint Mary's Campus Rochester, MN
Miami Children's Health System Miami, FL
Nationwide Children's Hospital Columbus, OH
Nemours Children's Health Wilmington, DE
New York - Presbyterian Weill Cornell Medical Center New York, NY
NorthWest Congenital Heart Care Tacoma, WA
Pediatric and Congenital Cardiology Associates Austin, TX
Pediatrix Cardiology Associates of San Antonio San Antonio, TX
Pediatric Cardiology Associates and Tampa Bay Adult Congenital Heart Center St. Petersburg, FL
Pediatrix Cardiology of Broward West Palm Beach, FL







Pediatrix Cardiology of Dallas Dallas, TX
Pediatrix Cardiology of North Texas Dallas, TX
Phoenix Children's Hospital Phoenix, AZ
Rainbow Babies & Children's Hospital Cleveland, OH
Riley Hospital for Children Indiana University Health Indianapolis, IN
Rocky Mountain Pediatric Cardiology Denver, CO
Sanger Heart & Vascular Institute Charlotte, NC
Seattle Children's Hospital Seattle, WA
Texas Children's Hospital Houston, TX
The Cleveland Clinic Foundation Cleveland, OH
The Mount Sinai Medical Center New York, NY
University of Kentucky Lexington, KY
University of Maryland Medical Center Cardiology Baltimore, MD
UCSF Benioff Children’s Hospital San Francisco, CA
UPMC Children's Hospital of Pittsburgh Pittsburgh, PA
Upstate Golisano Children's Hospital Syracuse, NY
Wellstar Kennestone Regional Medical Center Marietta, GA
1 Boston Children’s Hospital
Children’s Hospital of Philadelphia
Riley Hospital for Children at IU Health, Indianapolis
Cincinnati Children’s Hospital Medical Center
Texas Children’s Hospital, Houston
Ann and Robert H. Lurie Children’s Hospital of Chicago
Children’s Hospital Colorado, Aurora
Children’s Hospital Los Angeles
Monroe Carell Jr. Children’s Hospital at Vanderbilt,
UPMC Children’s Hospital of Pittsburgh
Children’s Healthcare of Atlanta
Seattle Children’s Hospital
Nationwide Children’s Hospital, Columbus, Ohio 79.2 11
14 Mayo Clinic Children’s Center, Rochester, Minn.
14
mending
27 24 6 4.0 Yes 54.4%
26 22 6 3.5 Yes 54.4%
26 21 6 4.3 Yes 36.9%
24 21 6 4.5 Yes 31.1%
22
Yes 26.7%
26 22 5 2.8 Yes 37.4%
26 23 6 4.1 Yes 13.4%
24 21 5 3.8 Yes 13.1%
18 5 3.5 Yes 28.0%
23 16 4 3.3 Yes 8.7%
20 21 6 5.3 Yes 7.8%
21 16 5 3.6 Yes 23.0%
33 25 21 5 3.3 Yes 21.8%
32 16 15 4 3.7 Yes 9.8%
15 Children’s Medical Center Dallas 78.3 12 2 35 22 20 6 3.3 Yes 13.8%
16 Rady Children’s Hospital, San Diego 77.2 12 2 36 22 12 5 3.5 Yes 9.8%
17 Children’s Mercy Kansas City Hospital, Mo. 76.8 14 2 35 15 17 5 4.2 Yes 2.4%
17 Children’s National Hospital, Washington, D.C. 76.8 10 2 36 26 16 5 3.9 Yes 14.3%
18 St. Louis Children’s Hospital-Washington University 76.1 14 2 35 20 17 4 3.7 Yes 2.0%
20 Cohen Children’s Medical Center, New Hyde Park, N.Y. 75.6 14 2 34 19 15 3 4.0 Yes 2.5%
21 Johns Hopkins Children’s Center, Baltimore 73.6 11 2 36 13 16 3 3.6 Yes 11.0%
22 Lucile Packard Children’s Hospital Stanford, Palo Alto, Calif. 73.1 12 2 35 20 11 3 4.3 Yes 3.4%
23 UCSF Benioff Children’s Hospitals, San Francisco and Oakland 72.7 10 2 35 24 16 3 4.2 Yes 8.2%
24 Cleveland Clinic Children’s Hospital 72.6 13 2 32 14 14 4 3.5 Yes 0.7%
24 U. of Michigan Health C.S. Mott Children’s Hospital, Ann Arbor 72.6 12 2 34 19 15 3 4.9 Yes 5.0%
Norton Children’s Hospital, Louisville, Ky. 72.2 15 2 29 25 15 6 3.1 No 0.9%
Duke Children’s Hospital and Health Center, Durham, N.C. 69.4 11 2 33 23 17 3 3.6 Yes 7.6%
UCLA Mattel Children’s Hospital, Los Angeles 69.0 14 2 28 11 12 2 4.6 Yes 3.2%
Valley Children’s Healthcare and Hospital, Madera, Calif. 68.7 15
Yale New Haven Children’s Hospital, New Haven, Conn.
University of Chicago Comer Children’s Hospital
Children’s Hospital New Orleans
Children’s Hospital of Richmond at VCU, Va.
Connecticut Children’s Medical Center,
York-Presbyterian
Wisconsin Hospital,
Carolina
Hospital,
33 13 15 3 3.8 Yes 0.8%
16 14 2 4.1 Yes 4.8%
8 14 6 3.4 Yes 0.8%
11 15 4 1.9 Yes 1.9%
11 12 4 2.6 Yes 1.9%
assesses key information of CHD patients undergoing diagnosis catheterizations and catheter-based care. The Physician Champion is listed with the hospital.
Adventhealth Orlando Matthew Zussman, MD
Advocate Children’s Hospital Oak Lawn Alexander Javois, MD
Arkansas Children’s Hospital
Michael Angtuaco, MD
Ascension St. Vincent Hospital
Brenda Erner, MD
Atrium Health’s Carolinas Medical Center
Joseph Paolillo, MD
Boston Children’s Hospital Brian Quinn, MD
Cedars - Sinai Health Systems Evan Zahn, MD
Children’s Healthcare of Atlanta Dennis Kim, MD, PHD
Children’s Hospital and Medical Center - Omaha Christopher Curzon, DO



Children’s Hospital Colorado Ryan Leahy, MD
Children’s Hospital Medical Center of Akron David Waight, MD
Children’s Hospital of Los Angeles Neil Patel, MD
Children’s Hospital of New Orleans Marla Johnston, MD
Children’s Hospital of Orange County Michael Recto, MD
Children’s Hospital of Philadelphia Jonathan Rome, MD
Children’s Hospital of San Antonio Srinath Gowda, MD
Children’s Hospital of the Kings Daughters, Inc. Michael Vance, MD
Children’s Medical Center of Dallas Surendranath Veeram Reddy, MD
Children’s Mercy Kansas City Stephen Kaine, MD
Children’s Minnesota Marko Vezmar, MD
Children’s National Medical Center Joshua Kanter, MD
Children’s Wisconsin Susan Foerster, MD
Cincinnati Children’s Hospital Medical Center
Shabana Shahanavaz, MD
Cleveland Clinic
Bradley Martino, MD

Cohen Children’s Medical Center
Dipak Kholwadwala, MD
Connecticut Children’s Medical Center Cesar Mesia, MD
Cook Children’s Medical Center Deborah Schutte, MD
Dell Children’s Medical Center of Central Texas Byron Holt, MD
Duke University Hospital Gregory Fleming, MD
Geisinger Medical Center Robert Mangano, MD
Indiana University Health Methodist Hospital Georges Ephrem, MD
Inova Fairfax Medical Campus IHVI Harvey Sherber, MD
Intermountain Primary Children’s Hospital Robert Gray, MD
Jackson Memorial Hospital - Jackson Health System Satinder Sandhu, MD
Joe Dimaggio Children’s Hospital K Chan, MD
Johns Hopkins All Children’s Hospital, Inc Jim Thompson, MD
Johns Hopkins Hospital John Thomson, MD
Kaiser Permanente Oakland Medical Center Luis Alesandro Larrazabal Martinez, MD
Le Bonheur Children’s Hospital Shyam Sathanandam, MD
Loma Linda University Medical Center Brent Gordon, MD
Lucile S. Packard Children’s Hospital at Stanford University Kara Motonaga, MD
Lurie Children’s Hospital of Chicago Alan Nugent, MD
Maine Medical Center Jon Donnelly, MD
Massachusetts General Hospital Ignacio Inglessis, MD
Mayo Clinic Hospital - Saint Mary’s Campus Allison Cabalka, MD
Medical City Dallas Hospital Vivian Dimas, MD
Medical University of South Carolina Varsha Bandisode, MD
Memorial Hermann Hospital - TMC Kiran Mallula, MD
MemorialCare Long Beach Medical Center Saar Danon, MD
Methodist Hospital/Methodist Children’s Hospital Rolando Zamorasalinas, MD
Miami Children’s Health System Lourdes Prieto, MD Michigan Medicine Wendy Whiteside, MD
Montefiore Medical Center Nicole Sutton, MD
Nationwide Children’s Hospital Darren Berman, MD Nemours Children’s Health Wolfgang Radtke, MD
Nemours Children’s Hospital Mike Bingler, MD
New York - Presbyterian Weill Cornell Medical Center Ralf Holzer, MD
New York Presbyterian - Morgan Stanley Children’s Matthew Crystal, MD
Newark Beth Israel Medical Center Rajiv Verma, MD
Norton Children’s Hospital Edward Kim, MD
NYU Langone Health - Tisch Hospital Physician Michael Argilla, MD
Ochsner Clinic Foundation Ivory Crittendon, MD
Oregon Health & Science University Ali Mumford, MD
Orlando Health David Nykanen, MD
OSF Healthcare Saint Francis Medical Center Priti Patel, MD
OU Medicine, Inc. Charles Sperrazza, MD
Penn State Hershey Medical Center Howard Weber, MD
Phoenix Children’s Hospital Joseph Graziano, MD
Presbyterian/St. Luke’s Medical Center David Miller, MD
Providence Sacred Heart Medical Center
Carl Garabedian, MD
Rady Children’s Hospital - San Diego Howaida Elsaid, MD
Rainbow Babies & Children’s Hospital
Martin Bocks, MD
Riley Hospital for Children Indiana University Health Larry Markham, MD
Seattle Children’s Hospital
Agustin Rubio, MD
Spectrum Health


Joseph Vettukattil, MD
SSM Cardinal Glennon Children’s Medical
Robert Petersen, MD
St. Christopher’s Hospital for Children
Boban Abraham, MD
St. Joseph’s & St. Joseph’s Children’s Hospitals
Jeremy Ringewald, MD
St. Louis Children’s Hospital
David Balzer, MD
Straub Medical Center
James Sim, MD
Sutter Medical Center - Sacramento
Peihsiu Huang, MD
Texas Children’s Hospital
Gary Stapleton, MD
The Mount Sinai Medical Center
Barry Love, MD
UC San Diego Health System Sulpizio
Cardiovascular Center
Laith Alshawabkeh, MD
UCSF Benioff Children’s Hospitals, Oakland
Suzanne Strong, MD
UF Health Shands Hospital
James Fudge, MD
UNC Medical Center
Elman Frantz, MD
University of California (UCLA)
Mark Sklansky, MD
University of California Davis Medical Center
Frank Ing, MD
University of California San Francisco Medical Center
Phillip Moore, MD
University of Iowa Hospitals and Clinics

Osamah Aldoss, MD
University of Kentucky
Liliana Terziyskakuvlieva, MD
University of Maryland Medical Center Cardiology
Sudhir Vashist, MD, MBBS
University of Minnesota Health, Heart Care Gurumurthy Hiremath, MD
University of Mississippi Medical Center
Libby Poag, MD
UPMC Children’s Hospital of Pittsburgh
Jackie Kreutzer, MD
UR Medicine Strong Memorial Hospital
Rajiv Devanagondi, MD
UW Health Luke Lamers, MD
Valley Children’s Hospital Carl Owada, MD
VCU - Medical College of Virginia Kyongjin Lee, MD
Vidant Medical Center
Dennis Morris, MD
Wake Forest Baptist Health
Derek Williams, DO
Wayne State University - Children’s Hospital of MI
Thomas Forbes, MD
Westchester County Health Care Corp.

Markus Erb, MD
Wolfson Children’s Hospital
Robert English, MD
Yale New Haven Hospital
Jeremy Asnes, MD
BC Children’s Hospital
Shubhayan Sanatani, MD
CHU Sainte - Justine
Jeanluc Bigras, MD
Stollery Children’s Hospital
Elina Williams, MD
The Hospital for Sick Children
Audrey Marshall, MD








F YOU’RE LIKE MOST people facing hospi talization, you’d prefer to stay close to home. It’s more convenient. It might avoid a hefty bill for out-of-network care. Friends and family may be able to visit you. And getting follow-up care from the same medical team will be more practical.
Our Best Regional Hospitals listings showcase nearly 500 hun dred hospitals around the U.S. that offer high-quality care across a range of clinical services. These services include both complex, highly specialized care for the sickest patients – the focus of the Best Hospitals specialty rankings (see Page 110) – and safe, effec tive treatment for those whose medical needs are more common place, such as patients seeking hip or knee replacement surgery for age-related arthritis. The Best Regional Hospitals rankings, found in their entirety at usnews.com/bestregionalhospitals, offer readers in most parts of the country a number of high-quality choices near home.

These evaluations include ratings of how well hospitals handle 20 relatively common procedures and conditions in addition to their assessments in 11 specialties.* The 20 areas of care are colon can cer surgery, lung cancer surgery, ovarian cancer surgery, prostate cancer surgery, uterine cancer surgery, heart attack, heart failure, heart bypass surgery, heart valve surgery, transcatheter aortic valve replacement, abdominal aortic aneurysm repair, stroke, back sur
gery, hip replacement, knee replacement, hip fracture, diabetes, kidney failure, pneu monia and chronic obstructive pulmonary disease. Hospitals are assigned a rating of “high performing,” “average” or “below av erage” in each area in which they treated enough patients to be evaluated.
Recognition as a Best Regional Hospital means a hospital was nationally ranked in at least one of 11 specialties, or that it earned at least seven “high performing” ratings across the procedures and conditions. Each such hospital also had to meet certain other cri teria; an FAQ at usnews.com/best-hospitals offers more details.
The Best Regional Hospitals appear ranked by state on the following pages. Hos pitals are numerically ordered according to the following rules:
1. The higher rank went to the hospital with the better status in the Best Hospitals Honor Roll ranking (Page 109), if applicable.
*Cancer; cardiology & heart surgery; diabetes & endocrinology; ear, nose & throat; gastroenterology & GI surgery; geriatrics; obstetrics & gynecology; neurology & neurosurgery; orthopedics; pulmonology & lung surgery; and urology.
by Ben Harder ©
How we identified and ranked the top hospitals state by state
2. Next, the higher rank went to the hospital that earned more points according to the following three rules: (a) A hospital received two points for each of the 11 specialties in which it was ranked among the top 50. (b) A hospital received one point for each specialty, procedure or condition in which it was rated high performing. (c) A hospital lost one point for each procedure or condition in which it was rated below average. Certain rare exceptions apply.
Based on the same rules, hospitals in major metropolitan areas also were ranked against other top hospitals in the metropolis. Our website displays these rankings for 92 metro areas with approximately 500,000 or more residents. The website also lists top hospitals in more than 100 U.S. News-defined regions, such as Kentucky’s Bluegrass Region, the Ozarks in Arkansas and the Florida Panhandle, to help consumers outside the biggest urban centers searching for high-quality care.
Our goal with the state and metro area rankings is to identify general medical-

surgical hospitals that provide both breadth and quality, so only hospitals that deliver a wide range of clinical services for adults were considered for the Best Regional Hospitals rankings.

Pediatric care did not factor into these rankings; instead, children’s hospitals are separately ranked by region (Page 210) based on their performance across the 10 children’s specialties (Page 165).
How a hospital performed in ophthalmology, psychiatry, rehabilitation and rheumatology did not factor into the Best Regional Hospitals rankings, either. While these four specialties are undeniably important, many hospitals treat few, if any, inpatients in these specialty areas. Additionally, specialty hospitals such as dedicated cancer centers, surgical hospitals and rehabilitation facilities were not considered for the regional rankings.
When choosing a hospital, you’ll want to consult with your physician or other health professional and combine your own research with ours to find the best possible care.
l

U.S. NEWS EVALUATED nearly 4,500 hospitals on their performance in 20 common procedures and conditions, ranging from treatment for stroke to surgery for colon cancer. While many hospitals demonstrated certain areas of strength, only these four hospitals were high performing in all 20 types of care.
l Barnes-Jewish Hospital
St. Louis, Missouri
l Cedars-Sinai Medical Center
Los Angeles, California
l Mayo Clinic Rochester, Minnesota
l NYU Langone Hospitals
New York, New York
help patients identify top hospitals near home, the table below compares hospitals across 11 of the areas of complex specialty care that comprise the Best
rankings
plus 20 routine procedures and conditions.
Providence Saint John’s Health Center, Santa Monica
Kaiser Permanente Los Angeles Medical Center
Eisenhower Medical Center, Rancho Mirage
21 Kaiser Permanente Anaheim and Irvine Med. Centers, Anaheim
21 Providence St. Joseph Hospital-Orange
24 PIH Health Hospital-Whittier
24 Sharp Chula Vista Medical Center, Chula Vista
26 Adventist Health Glendale
26 Kaiser Permanente San Diego Zion and San Diego Med. Ctr.
26 Mercy General Hospital, Sacramento
26 Providence Little Company of Mary Medical Center Torrance
26 Providence St. Joseph Medical Center-Burbank
31 MemorialCare Orange Coast Medical Center, Fountain Valley
31 Providence St. Jude Medical Center, Fullerton
33 Kaiser Permanente Fontana and Ontario Med. Centers, Fontana
33 MemorialCare Saddleback Medical Center, Laguna Hills
33 Santa Barbara Cottage Hospital, Santa Barbara
36 Community Memorial Hospital-Ventura
37 Community Hospital of the Monterey Peninsula, Monterey
37 Kaiser Permanente Roseville
Vincent’s
Cleveland Clinic Indian River Hospital, Vero Beach
Mease Countryside Hospital, Safety Harbor
Memorial Hospital West, Pembroke Pines
Memorial Regional Hospital, Hollywood
Ascension Sacred Heart Pensacola Hospital, Pensacola
Holy Cross Health-Fort Lauderdale
St. Anthony’s Hospital, St. Petersburg
24 Tallahassee Memorial Healthcare, Tallahassee
24 UF Health Jacksonville
AdventHealth Waterman, Tavares
Health First Holmes Regional Medical Center, Melbourne
Cleveland Clinic Martin Health, Stuart
Lakeland Regional Health, Lakeland
Physicians Regional-Pine Ridge, Naples
University Hospital, Atlanta13
St. Joseph’s Hospital, Atlanta
Hospital Atlanta
The NCH Healthcare System has received the Healthgrades 2022 America’s 100 Best Hospitals Award™. This notable distinction places NCH in a small, elite group of hospitals who are in the top two percent of nearly 4,500 hospitals assessed nationwide for superior clinical care and patient outcomes for the treatment of the most common conditions and procedures as measured by Healthgrades, the leading resource that connects consumers, physicians and health systems.

For more information on the award-winning services of the NCH Healthcare System, please visit NCHmd.org.

Lutheran General Hospital,
Edward Hospital,
Good Shepherd Hospital, Barrington
Northwestern Medicine-McHenry, Huntley & Woodstock, McHenry
Advocate Sherman Hospital, Elgin
Northwestern Lake Forest Hospital, Lake Forest
Northwestern Medicine Central DuPage Hospital, Winfield
Advocate Good Samaritan Hospital, Downers Grove
14 Advocate Illinois Masonic Medical Center, Chicago
14 Northwestern Medicine Palos Hospital, Palos Heights
14 OSF HealthCare St. Francis Medical Center, Peoria
18 Carle Foundation Hospital, Urbana
Elmhurst Hospital, Elmhurst
Advocate Condell Medical Center, Libertyville
Northwest Community Hospital, Arlington Heights
Northwestern Medicine Delnor Hospital, Geneva
Silver
Henry Ford Macomb Hospitals, Clinton Township
McLaren Northern Michigan Hospital, Petoskey
Mercy Health St. Mary’s Campus, Grand Rapids
Ascension Borgess Hospital, Kalamazoo
Ascension Genesys Hospital, Grand Blanc
Beaumont Hospital-Dearborn
Covenant Healthcare-Saginaw
St. Joseph Mercy Oakland, Pontiac
Ascension St. John Hospital, Detroit
McLaren Flint Hospital, Flint
Mayo Clinic, Rochester
Abbott Northwestern Hospital, Minneapolis21




















At Hackensack Meridian Health , we’re honored to have more U.S. News & World Report-ranked hospitals than any other system in New Jersey. We’re proud to be home to the state’s only nationally-ranked Urology and Neurology & Neurosurgery programs, as well as the best Cardiology & Heart Surgery program. As if that isn’t enough, we also offer our patients nationally recognized Orthopedics and Rehabilitation programs, and premier cancer care at John Theurer Cancer Center. Earning such high praise proves that we’re ready whenever and wherever New Jersey needs us.






To learn more about these rankings and find a doctor, visit HackensackMeridianHealth.org.






Stony Brook University Hospital, Stony Brook
Huntington Hospital at Northwell Health, Huntington
New York-Presbyterian Brooklyn Methodist Hospital, Brooklyn
St. Peter’s Hospital-Albany
13 Mount Sinai Morningside & Mount Sinai West Hosps., New York
13 Rochester General Hospital, Rochester
15 South Shore University Hospital at Northwell Health, Bay Shore
16 White Plains Hospital, White Plains
17 Mount Sinai Beth Israel, New York
17 Northern Westchester Hosp. at Northwell Health, Mount Kisco
17 St. Joseph’s Health Hospital, Syracuse
17 Strong Memorial Hospital of the University of Rochester
21 Buffalo General Medical Center
22 Albany Medical Center, Albany
22 Staten Island University Hosp. at Northwell Health, Staten Island
22 Upstate University Hospital, Syracuse
25
York-Presbyterian/Queens,
Samaritan Hospital-West
Brothers Medical Center,
Sinai South Nassau Hospital,

Clinic
Valley Hospital,
General,
Toledo Hospital,
Health Main Campus,
Hospital,
North Hospital, Cincinnati
Clinic South Pointe Hosp., Warrensville
University Hospitals
Medical Center, Beachwood
Hospital,
Hospital,
Hospital,
Line Health Bryn Mawr Hospital,
Temple University Hospital, Philadelphia
UPMC Passavant, Pittsburgh
Chester County Hospital, West Chester
Jefferson Health-Abington Hospital, Abington
Geisinger Medical Center, Danville
Mary Medical Center-Langhorne
General Hospital,
Nittany Medical Center,
Hamot,
Baylor Scott and White Medical Center-Temple
Memorial Hermann Hospital, Houston37
Memorial Hermann Greater Heights Hospital, Houston
St. David’s Medical Center, Austin
Ascension Seton Medical Center Austin
Christus Mother Frances Hospital-Tyler
Houston Methodist Sugar Land Hospital, Sugar Land
Memorial Hermann Memorial City Medical Center, Houston
Methodist Hospital-San Antonio
Parkland Health-Dallas
Texas Health Presbyterian Hospital Dallas
Baptist Medical Center, San Antonio
Covenant Medical Center-Lubbock
Medical City Dallas
Dallas Medical Center
Health Harris Methodist Hosp. Southwest,
David’s South Austin Medical Center
or good reasons, parents of kids who need specialty care tend to seek a hospital close to home, usually within the state where they live or in a neighboring state. Designed to help families identify top pediatric centers near home, the region-by-region rankings below compare children’s hospitals on overall performance across 10 pediatric specialties.
Children’s Hospital, Charlotte,
Carolina Children’s Hospital
Arkansas Children’s Hospital, Little Rock
Arnold Palmer Hospital for Children, Orlando
Nicklaus Children’s Hospital, Miami
UF Health Shands Children’s Hospital, Gainesville, Fla.
Johns Hopkins All Children’s Hospital, St. Petersburg, Fla.
MUSC Shawn Jenkins Children’s Hospital, Charleston, S.C.
Le Bonheur Children’s Hospital, Memphis, Tenn.
Ochsner Hospital for Children, New Orleans
15 Children’s Hospital New Orleans
15 Joe DiMaggio Children’s Hospital at Memorial, Hollywood, Fla.
15 Nemours Children’s Hospital-Florida, Orlando
18 AdventHealth for Children, Orlando
18 Holtz Children’s Hospital at UM-Jackson Memorial Medical Center, Miami
18 Wolfson Children’s Hospital, Jacksonville, Fla.
Cincinnati Children’s Hospital
Nationwide Children’s Hospital, Columbus,
Children’s
UC Davis Children’s Hospital, Sacramento, Calif.

Loma Linda University Children’s Hospital, Loma Linda,
Health Fairview Masonic Children’s Hospital-Children’s Minnesota
Primary Children’s Hospital-Shriners Hospitals for Children-University of Utah 13Children’s Medical Center Dallas-Scottish Rite Hospital for Children 14Jimmy Everest Center for Cancer and Blood Disorders in Children 15Doernbecher Children’s Hospital at OHSU/Shriners Hospitals for Children Portland 16UC Davis Children’s Hospital/Shriners Hospitals for Children-Northern California
LOS ANGELES
Uniting expertise from Columbia and Weill Cornell Medicine to innovate women’s health.
What’s better than the top minds from one of the nation’s best schools? Top minds from two of them. Dr. D’Alton, Dr. Riley, and their teams are working to achieve pioneering breakthroughs in all areas of women’s health and improve care for all our patients.


